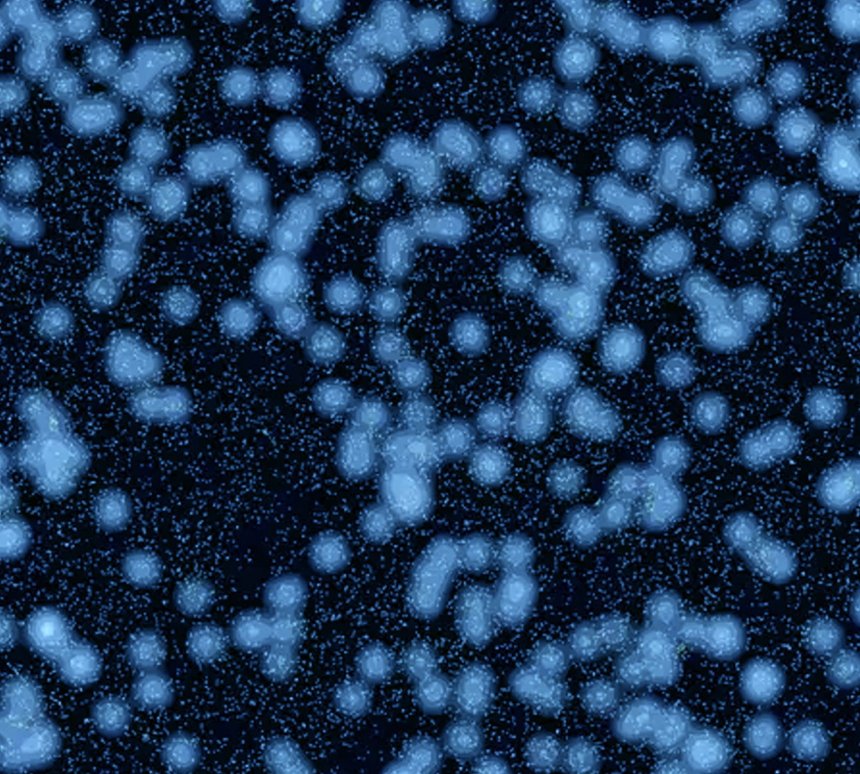
Zoek de ‘Big Ring’, iets boven het midden. De kleine spikkeltjes zijn verre quasars; de grotere lichtvlekken markeren de plekken waar zich veel voorgrondsterrenstelsels bevinden. (Beeld Alexia Lopez/De Volkskrant)

Logboek 2024/1 Winter, 2 oorlogen

Dit is een bijzondere foto. In 1986 ving men de renovatie van de Lingesluis aan en vond een 400 pond zware Duitse bom in de sluiskolk. Of ervoor, dat weet ik niet. Waar de bom tot ontploffing werd gebracht, weet ik ook niet. Links zie je het kantoor van de havendienst en daarnaast de voorganger van ons huis, dat zelf werd gerenoveerd in 1991.
In het komende kwartaal wordt het dek van onze Dulce opgeknapt, een intensieve klus waarvoor mast en tuigage verwijderd moest en ze in de loods van Jachtwerf Rexwinkel in Numansdorp werd gelegd. Na Oud & Nieuw begint men met de klus, waarbij de hoop is dat de drie plekken van de lekkages na verwijdering van het oude teakdek gevonden en gedicht kunnen worden. Daarna komt er een nieuw dek van kunstteak op met dezelfde kleur als het nog goede teak van zonnedek, kuip en zwemplatform. Ook krijgen we een nieuwe wasmachine. Met zo'n anderhalf tot twee maanden zou de klus geklaard zijn.
Gorinchem (24.001)

Maandag 01-01-2024, Nieuwjaarsdag
De oogst van oudjaarsavond: enige tientallen gewonden, een tweede dode (In Haarlem) en ettelijke zwaargewonden en veel oogletsels. Het vuurwerkverbod in een aantal steden (Nijmegen, Tilburg, Eindhoven) werd massaal genegeerd. De politie pakte minstens 200 mensen op vanwege vernielingen, brandstichtingen en opstootjes, blijkt uit de eerste schattingen. Mensen, vaak met bivakmutsen op, wierpen stenen en vuurwerk naar de politie en naar hulpverleners. Tientallen agenten raakte gewond. Het is weer voorbij. In Gorcum bleef het rustig, althans rond de haven en op het Eind. Wel mooi siervuurwerk gezien. De brandweer rukte een aantal keren uit voor kleine brandjes. We keken naar twee documentaires over ABBA en hebben nog even gedanst. Dit jaar geen champagne. Elkaar gekust en een goed nieuwjaar gewenst. Direct na twaalf uur belde Rommert. Na half één kwam buurman Lourens langs met een fles champagne. Dus toch champagne. Het werd tegen half drie. Vanochtend scheur ik het laatste blaadje van de scheurkalender af en hang de nieuwe op, de Sterrenkunde scheurkalender. Weer een heel jaar scheuren en lezen. Anna kookt voor het eerst eitjes in de airfryer; zonder gas, ze had gisteren uitgevonden dat zoiets kan (10 minuten op 120 graden).
In de tweede helft van de middag zullen de dochters van Anna en hun aanhang het traditionele nieuwjaarsbezoek aan ons brengen.
De gemiddelde temperatuur van het jaar 2023 in De Bilt komt inderdaad uit op 11,8 graden, zoals verwacht. Dat is maar liefst 1,3 graden boven het dertigjarig gemiddelde van 1991 - 2020. Tweederde van de maanden had een hogere temperatuur. Nu op weg naar nieuwe klimaatrecords in 2024! Naar het begin van dit kwartaal
Gorinchem (24.003)

Woensdag 03-01-2024
Storm Henk bracht een onstuimige nacht maar niet veel problemen. Omgewaaide bomen, afgewaaide takken op de wegen, losgewaaide zonnepanelen en een losgewaaide gevel in Zaandam. In een dorp bij Eindhoven woei iemand met zijn fiets om en liet daarbij het leven. Onder meer in IJmuiden en Vlissingen mat men ruim een uur lang gemiddeld windkracht 9. Zie hier hoe de storm aan zijn naam komt. Het KNMI had voor het noordwesten code oranje afgekondigd. Dat kon om 2 uur worden ingetrokken. De overlast door opgestuwd water in IJsselmeer en Markermeer viel mee. Vanmorgen is het weer kalm. Het water in de Lingehaven is vannacht gestegen tot steigerniveau. Het waterschap sloot de Arkelse Damsluis weer af, waardoor er meer water naar het Kanaal van Steenenhoek en onze haven afvloeit. In de grote rivieren valt het peil mee. In Duitsland voert De Moezel veel regenwater af naar de Rijn. Dat kan rond 5 januari bij Lobith langskomen. De komende dagen wordt het kouder en droger. Bij ons komt vanmorgen iemand de rookgasafvoer van onze cv-ketel verbeteren. De afvoerpijp bestond uit twee materialen (metaal en kunststof), wat niet mag, en hij zat niet goed aan muur en plafond vast.
Vandaag wat korte perioden met zon in de ochtend, in de middag steeds vaker regen. Op BdW leggen nieuwe cruiseschepen aan. Groepen toeristen lopen met kleurige groene paraplu's over de sluis. Anna gaat op bezoek bij een vriendin op de Schuttersgracht.
Inderdaad lijkt het weersysteem dat maandenlang treinen van oceaandepressies naar Europa bracht, eindelijk te veranderen. Er gaat door hogere drukgebieden meer kou uit het noorden naar ons toe komen en het wordt droger. Een verschuiving van een trage uitzakker van de straalstroom? Er is meer kou in het hoge noorden, zoals vannacht in Zweden, waar de thermometer vannacht -43,6 graden aanwees. Die ijzige temperatuur werd gemeten in het dorpje Kvikkjokk. Het was de laagste temperatuur in januari in 25 jaar in Zweden. Ook in andere delen van Zweden en Finland is het nu extreem koud met temperaturen rond de -40 graden. De verwachting is dat de kou de komende dagen aanhoudt. Warhoofden, domrechtse lieden en klimaatwappies zullen gaan roepen: zie je wel dat klimaatopwarming niet bestaat! Je hoeft inderdaad niet lang te wachten: hier Raisa Blommestijn op X.
Verdere verhoging van de spanningen in het Midden Oosten dankzij de uitschakeling door Israël met een drone van een Hamasleider in Beiroet en de dood van ruim 100 doden door twee bomexplosies bij de herdenking in de stad Kerman van de dood van generaal Soleimani, leider van de Iraanse Revolutionaire Garde, vier jaar geleden. Zullen Hezbollah en Iran zich in de oorlog mengen? Hezbollah-leider Hassan Nasrallah geeft naar verwachting om 17.00 uur (Nederlandse tijd) een toespraak. Sinds de Hamas-gruweldaden op 7 oktober vorig jaar en het grootschalig geweld van Israël in Gaza, hopen de spanningen zich in de regio zó snel op dat het op een autokatalytisch proces lijkt, dat onvermijdelijk naar de uitbraak van een grote oorlog leidt. Net zoals dat nog steeds mogelijk is bij de oorlog in Oekraïne. Bij beide conflicten zijn dezelfde twee rivaliserende grootmachten betrokken: de VS en Rusland. Vier staten hebben kernwapens; behalve de eerdere twee ook Israël en waarschijnlijk Iran. Naar het begin van dit kwartaal
Gorinchem (24.004)

Donderdag 04-01-2024
Gisteravond zag ik - Anna was vroeg naar bed gegaan - met groot enthousiasme de uitzending van VPRO's Wintergasten, waarin Janine Abbring de Britse zoöloog en schrijver George Monbiot interviewde. 'De media zijn een grotere bedreiging dan de fossiele brandstofindustrie', zei hij na het afspelen van een fragment uit de film 'Don't Look Up'. Ik voelde een enorme verwantschap met Monbiot, van wie een aantal boeken in mijn kast staan. Veel herkenning, zowel qua jeugd en leergierigheid als qua liefde voor de wetenschap, opvattingen en somberheid. Dat laatste niet omdat de aarde zal vergaan, die overleeft de mensheid wel, maar over de onzinnige mens die zelf de zesde massa-extinctie teweegbrengt. De multipele crises van het heden doen Monbiot sterk denken aan de aanloop voor de Perm-Trias massa-extinctie van 251 miljoen jaar geleden, de grootste golf van uitsterven ooit. Toen stierf 95% van alle in zee levende soorten uit, evenals en ongeveer 70% van de gewervelde landdieren. Het is daarnaast de enige keer dat ook de insecten op grote schaal (een derde) uitstierven.
Amsterdamse wetenschappers ontdekten de oorzaak van het postcovidsyndroom en met name van de extreme vermoeidheid waar het mee gepaard gaat. Postexertionele malaise (PEM). Knap onderzoek! Het artikel in Nature Communications staat hier. Men vond een duidelijke biologische oorzaak. Het is dus niet 'psychisch'. Bij postcovidpatiënten is na inspanning de schade in het spierweefsel veel groter dan bij gezonde mensen. Hun mitochondriën, de energiecentrales in de cellen, functioneren minder goed. Inspanning verergert hun klachten. Dat geldt niet alleen voor spierweefsel, maar voor alle cellen in het lichaam, dus ook voor hersencellen. Die werken allemaal veel slechter. Hoe het pathologisch mechanisme precies werkt is nog onbekend. Tot dusver denken veel wetenschappers dat er restjes virus achter blijven in het lichaam, die de immuunrespons blijven aanjagen. Daarvoor vonden de Amsterdammers geen aanwijzingen. Mogelijk blijft er wel een enzym in de lichaamscellen achter, dat de mitochondrieën laat doorrazen en permanente cellulaire stress geeft. Dat gaan ze verder uitzoeken.
Veel regen in de nacht en ook vandaag, afgewisseld met zonnige periodes. De Linge stijgt verder. In de haven staan de steigers nu onder water. Gisteren viel aan het eind van de middag een van de drie pompen van het Kolff-gemaal bij Hardinvxveld uit. Ondanks de inzet van een extra drijvend gemaal is de pompcapaciteit nu niet meer genoeg om alle water van de polders af te voeren via het Kanaal van Steenenhoek. Het waterschap zette de keersluis van het Merwedekanaal bij Gorcum deels dicht, om te voorkomen dat het water er over de oevers gaat stromen. Derhalve gebruikt men nu de Linge als buffer en dat merken we tot hier in de haven. Men gebruikt een van de keersluizen in Asperen om het water zo goed mogelijk te verdelen tussen Tiel - Geldemalsen - Leerdam en Gorcum. Gelukkig heeft het waterschap inmiddels een nieuwe motor voor het Kolffgemaal gevonden. Die bouwen ze nu in. Toch beginnen vanmiddag tuinen in Leerdam onder te stromen. De gemeente deelt zandzakken uit.
Ook de grote rivieren stijgen weer. Voor de Rijn wordt de piek zondagochtend verwacht. Waarschijnlijk wordt het bij Lobith toch niet meer dan 14,5 meter; hetzelfde niveau als direct na de Kerstdagen. De hoofdmoot van alle regen viel in een brede zône die over België en Noordoost-Frankrijk naar het oosten loopt. Rijkswaterstaat springt de Fransen bij; twee experts vertrokken met twee noodpompen naar Duinkerken en Calais. De Maas steeg gisteren razendsnel. In Maastricht verwacht men vandaag de hoogste piek. Eveneens in Maastricht spoelde gisteren een overlaatdam weg bij de stuw van Borgharen. Woonboten in een afwateringskanaal moesten ontruimd worden. Eén woonark sloeg los, dreef pardoes over de afsluitdam heen en knalde tegen een brug aan die nu dreigt in te storten.
Op snelwegen in het zuiden van Zweden en het midden van Denemarken stonden vannacht duizenden auto's uren vast vanwege hevige sneeuwval. Mensen moesten de nacht in hun auto's doorbrengen. In Zweden is het leger ingezet om mensen te bevrijden. De wappies kraaien opnieuw victorie, zoals SinjoorinMokum. Zie je wel, al die sneeuw, geen sprankje van klimaatopwarming! Zwarte Henk hoort Gerrit Hiemstra al knarsentanden. Rare namen hebben die gasten. Het heeft weinig zin ze te zeggen dat in een warmer klimaat de hydrologische cyclus intensiever wordt met onder andere juist groter kans op extreme sneeuwval. Zie o.a. hier.
Omdat Anna vanmorgen migraine heeft ga ik alleen naar de sportschool. Vanmiddag is ze weer opgeknapt en gaat op bezoek bij onze bovenste buurvrouw. Ik kijk eens in de kelders onder ons huis. Droog. Een dikke tien jaar geleden liepen ze wel eens onder. Toen werden de muren geïmpregneerd en waterafstotend gemaakt. Dat werkt nog steeds. Naar het begin van dit kwartaal
Gorinchem (24.005)

Vrijdag 05-01-2024
De gemiddelde wereldtemperatuur bleef in december ongewoon hoog. De update kwam vorige maand uit op +0,83 graden Celsius boven het gemiddelde van de periode 1991 - 2020; vrijwel even hoog als in oktober (+0,93) en november (+0,91). Het is het gemiddelde van de temperaturen die satellieten maten in de lagere atmosfeer. De lineaire trend van opwarming staat op +0,14 graden per tien jaar, te verdelen in +0,12 graden boven de oceanen en +0,19 graden boven de landmassa's. Het jaar 2023 was ook bij de satellietmetingen het warmste ooit gemeten sinds 1979, het begin van de metingen. Waarom de stijging zo groot was? Men schrijft dat toe aan vier factoren. Deels aan de El Niño, die vorig jaar begon en vooral in 2024 zal doorwerken, Voor een ander deel aan de 25e cyclus van zonneactiviteit, de schonere lucht boven de scheepvaartroutes (vanwege minder uitstoot van het koelende zwaveldioxide door schonere brandstof, lees hier) en voor een laatste deel aan de uitbarsting in januari 2022 van de ondergrondse vulkaan Hunga Tonga in de Stille Oceaan. Die bracht heel veel waterdamp in de hogere lagen van de atmosfeer, dat daar een jaar of twee à drie aanwezig blijft. Waterdamp is een sterk broeikasgas. Men becijfert de extra opwarming op +0,1 graden Celsius. Afgezien van deze vier factoren is er ook nog de opwarmingstrend zélf, die gewoon blijft doorgaan en verreweg het grootste aandeel levert.
Een grijze ochtend na weer een nacht regen. Waterschap Rivierenland heeft deze nacht een nieuwe pomp geplaatst in het Kolffgemaal in Hardinxveld. Het drijvend hulpgemaal blijft ook door pompen, zodat er extra water in de Beneden Merwede wordt geloosd. De Gorcumse Kanaalsluis kan nu weer open en dat werkt mee aan de verlagen van het hoge peil in de Linge. Nu, vrijdagmiddag, is het waterpeil bij ons in de haven niet meer gestegen en ook niet gedaald. Het peil in de Merwede bij Vuren stijgt vandaag nog wel en zal morgen ook nog stijgen. Door de aanvoer via de IJssel blijft de waterstand in het IJsselmeer nog steeds hoog, hoewel er weer water kon worden gespuid naar de Waddenzee. Bij Enkhuizen, Hoorn, Marken, Monnickendam en Volendam blijft het water hoog. Het Oranjesluizencomplex in het IJ bij Amsterdam blijft tot en met volgende week woensdag gestremd. Het Markermeer kan niet lozen op het IJsselmeer omdat het water daar hoger staat. Rijkswaterstaat denkt dat de waterstanden op beide meren over enkele dagen gelijk zullen zijn. In het weekend krijgen we droger weer. De vooruitzichten zijn gunstig, volgens de dienst. Misschien moet je zeggen dat we ditmaal aan flinke overlast ontsnappen. Maar niet te vroeg juichen, en zijn dan wel koude en vooral droge dagen op komst, maar volgens de KNMI-pluim duren die niet zo heel lang. Na 13 januari is er weer kans op nieuwe regen en natte sneeuw.
Vandaag dus regenbuien. We proberen tussendoor snel boodschappen te doen in de binnenstad, maar op de terugweg toch weer een bui. Naar het begin van dit kwartaal
Gorinchem (24.006)

Zaterdag 06-01-2024
Vannacht geen regen meer. Vanochtend is het grijs bewolkt maar droog. We brengen onze kapotte magnetron naar het Repair Café. Dat zit in een schoolgebouw op de Dokter Hiemstralaan, vlakbij waar Anna vroeger woonde (en sinds kort Jordin & Dane). Iedere eerste zaterdag van de maand zitten daar vrijwilligers met technisch vernuft klaar om kleine reparaties uit te voeren. We zijn met onze kapotte magnetron de eerste bezoekers van het jaar. Het probleem: de deur sluit niet meer en maakte geen contact. Twee reparateurs halen de omkapping eraf en weten de deur eruit te verwijderen. De oorzaak is meteen duidelijk, een veertje was losgeraakt. Dat moet de sluiting tegen een magnetisch contactje brengen. Ze bevestigen het weer en klaar is Kees! Bij het losmaken brak de deurhendel af; die lijmen ze nu weer vast. Kosten zijn er niet, wel kun je een bijdrage geven. Wij geven een tientje. Een prima instelling, dat Repair Café! Zo geven ze apparaten een langer leven in plaats van dat men meteen een nieuwe koopt. Dat hadden wij overigens wel gedaan, omdat we de afgelopen weken niet zonder wilden zitten. Die gaat nu naar de kelder als reserve, zolang de oude (circa 13 jaar) nog meegaat.
Anna gaat nog even naar de stad en ik loop naar het 'BOEM Paukeslag' van Paul van Ostaijen, nummer 29 in de Poëzieroute. Bij het vorig bezoek zag het er slecht uit; door vuil, mos en regenwater waren de kleinere letters niet goed leesbaar, maar nu viel het me mee. Na verwijdering van mos en vuil ziet het er weer toonbaar en leesbaar uit (foto hier). In de loop van de middag valt er toch weer druilregen.
Op de terugweg van het Repair Café zagen we dat het water van de Linge hard onder de Brug van Ceelen doorstroomt, op weg naar het Kanaal van Steenenhoek en het Kolffgemaal bij Hardinxveld. Op deze manier zal het water snel zakken, ook bij ons in de haven. Ook het waterpeil in de Merwede is niet zo hoog meer. De hoogste waterstand van de Rijn bij Lobith, die morgen naar verwachting wordt bereikt, valt wat lager uit dan Rijkswaterstaat verwachtte. De rivier bereikt een piek van ongeveer 14,35 meter boven NAP en dat is ongeveer 15 centimeter lager dan de top van het vorige hoogwater kort voor de jaarwisseling. Het is de vierde hoogwatergolf in de grote rivieren sinds 22 november vorig jaar. Rijkswaterstaat noemt dat ‘vrij uitzonderlijk’. In de loop van de dag vaart een binnenvaartschip zich vast in de ondergelopen uiterwaarden naast de IJsselkop bij Westervoort, niet ver van Arnhem op het punt waar de rivier aftakt van de Nederrijn. Het schip blokkeert de IJssel. Zo'n stranding gebeurde deze week ook al een keer op de rivier, iets verder naar het noorden. Door het hoge waterpeil is de vaargeul soms lastig zichtbaar.
Over uitsterven. De vogelgriep laat diepe sporen na onder vogels in het Waddengebied. De grote stern is in feite uitgestorven als broedvogel in het noorden van Nederland. Ook de slechtvalk gaat het ronduit slecht, staat in de Vogelbalans 2023 van Sovon Vogelonderzoek Nederland 2023. Naar het begin van dit kwartaal
Gorinchem (24.007)

Zondag 07-01-2024
De neiging is groot om de betekenis van alles te zoeken in het begin ervan. Wie het begin snapt, snapt de rest ook, is het idee (en het verlangen). Eind vorig jaar begon ik wat pogingen te doen om nader door te dringen naar de oerknal. Nu, na de feestdagen zal ik die weer voortzetten. We kwamen toen uit bij de ultrakorte periode van kosmische inflatie, een onvoorstelbaar extreme explosie van exponentiële groei, waarin de fluctuaties van het begin zowel werden afgevlakt als voor altijd vastgelegd. We zouden die dus moeten kunnen vinden. Overigens stellen sommigen deze explosieve oerinflatie gelijk aan de eigenlijke oerknal, hoewel hij strikt gesproken niet het begin van ons universum zou zijn. Ergens vlak na dat begin ontstonden het Higgsveld, de donkere energie, de natuurkrachten en alle materie, zowel de gewone als de donkere. Nadat de inflatie ophield, bestond het universum uit quark-gluonplasma en andere elementaire deeltjes. De temperaturen waren zó hoog dat de willekeurige bewegingen van deeltjes een relativistische snelheid bereikten en deeltje/antideeltjeparen van allerlei soorten deeltjes continu werden gevormd en vernietigd in botsingen. In het ziedendhete plasma overleefden de oorspronkelijke fluctuatie-verschillen van de oerknal en bleven bewaard tot 380.000 jaar later - het tijdstip dat het vlak van de laatste verstrooiing wordt genoemd - de vrij rondvliegende electronen zich hechten aan atoomkernen en het prille heelal doorzichtig werd. De oorspronkelijke fluctuatieverschillen zijn nog te zien in de kosmische achtergrondstraling (CMB) die we konden meten. Bijvoorbeeld met de COBE-satelliet (1992) en de WMAP- (2001) en de Planck-satelliet (2009 - 2013).
Besef s.v.p. dat het overzicht hierboven veel te beperkt is en te schematisch. Het moet nu even dienen om het onderwerp weer op gang te brengen. Op basis van de jongste gegevens van de Planck-satelliet wordt de leeftijd van onze kosmos becijferd op 13,798 ± 0,037 miljard jaar. Het zal niet verbazen dat iedereen opkeek toen recente waarnemingen lieten zien dat er zwarte gaten bestaan, die haast even oud zijn. Dus bijna 13,8 miljard jaar!
Dat is zeer vreemd: zwarte gaten ontstaan namelijk uit de explosies van sterren die aan het eind van hun bestaan zijn gekomen. Supernova's dus. Veel van die zwarte gaten gaan schuil in de kernen van sterrenstelsels, zoals er ook een in de kern van onze Melkweg zit, Sagittarius A*. Hij kwam in dit blog regelmatig aan de orde. Met de onvolprezen James Webb ruimtetelescoop ging men in de ruimte op zoek naar zwaartekrachtlenzen om de oudste sterrenstelsels in beeld te brengen. Op die manier vond men sterrenstelsel UHZ1, dat we zien zoals het er ongeveer een half miljard jaar na de oerknal uitzag. (Wie ver kijkt in het heelal, kijkt tegelijk terug in de tijd). Dit sterrenstelsel bevindt zich daarmee op meer dan 13,2 miljard lichtjaar van de aarde. Zit er ook een zwart gat in de kern van de stokoude UHZ1? Om daarachter te komen gebruikten de onderzoekers de röntgentelescoop Chandra, ook een satelliettelescoop. Een zwart gat slokt materie - ruimtestof en hele sterren - op uit zijn omgeving en produceert daarbij een kenmerkend soort röntgenstraling. Chandra bevestigde dat UZH1 een zwart gat in zijn kern had.
Deze waarneming betekent dus dat zwarte gaten al een half miljard jaar na de oerknal bestonden. Dat is een groot mysterie! Ga maar na: de evolutie van sterren, sterrenstelsels en tenslotte ineenstortende supernova's kost meerdere honderd miljoen jaren. Bovendien is er een maximaal tempo waarin een zwart gat massa kan opslokken en de massa van het zwarte gat in UHZ1 is zó groot dat een half miljard jaar simpelweg niet genoeg zou zijn om de waargenomen massa te bereiken. En nog meer....sinds de ontdekking van het buitensporig zware, zwarte gat in UHZ1 zijn er aanwijzingen gevonden voor nog veel meer oude en te zware zwarte gaten in het heelal. Hoe kunnen er zo kort na de oerknal al zoveel zwarte gaten zijn?
(Met dank aan Quantumuniverse en Quantamagazine).
Vanochtend is het grijs en droog. Tegen de middag klaart de hemel op. Het water in de haven is gezakt; de steigers zijn weer begaanbaar. Het tankschip dat gisteren bij de Kop van de IJssel aan de grond liep en de doorgang blokkeerde, is vlot getrokken. Het Gorcums volk paradeert weer massaal over de sluis en de wallen. Anna gaat naar de Grote Markt waar Tessa is met Lina-Mae om te schaatsen.
De hoogwaterpiek in het Markermeer is voorbij. Het peil in het IJsselmeer is voldoende gedaald om erop te kunnen lozen. Omdat de wind is gedraaid kan nu veel water vanuit het IJsselmeer naar de Waddenzee gespuid worden. De Rijn bij Lobith bereikte vanmorgen een piek van 14,35 meter boven NAP.. Minder dan de 14,5 meter van de vorige keer. De komende dagen zakt het naar normaal. We zijn er deze keer goed vanaf gekomen, maar de winter is nog lang niet om en de wereld warmt verder op. Naar het begin van dit kwartaal
Gorinchem (24.008)

Maandag 08-01-2024
Gisteren ging het over de oerknal en de zeer oude en zware zwarte gaten, die men onlangs met de JWST en de Chandra-satelliet ontdekte. Die hebben haast dezelfde leeftijd als het heelal zelf. Een mysterie. Hoe kunnen zulke enorme zwarte gaten al zó vlak na de oerknal zijn ontstaan? Dus toen het universum slechts 0,55 miljard jaar oud was? Daar zou niet voldoende tijd voor zijn geweest. Deze talrijke superzware zwarte gaten verschijnen onbegrijpelijk vroeg in de prille geschiedenis van het heelal. Daar verzamelen ze - zoals het hoort - ieder een tornado van stof en gas om zich heen en vormen er sterren en hele sterrenstelsels mee, die om de gaten heen cirkelen. De gigantische zwarte monsters ter grootte van miljoenen zonnen gaan zelf schuil in de kernen van die stelsels, die ze van binnenuit weer beginnen op te slokken. Een proces dat tientallen tot honderden miljarden jaren kan duren. Daarom kunnen wij ze nu nog zien met behulp van de twee ruimtetelescopen. Maar hoe kunnen ze zó vroeg ontstaan? Kunnen ze ook op andere manieren ontstaan dan via de gebruikelijke route, een supernova-explosie? Zijn ze misschien extreem snel gegroeid? Of waren ze van meet af aan al zo groot?
Voor de maximale snelheid van groei van een zwart gat bestaat een limiet, de Eddington-limiet. Als er teveel straling uit een zwart gat stroomt dan vliegt de materie, stof en gas, eromheen uiteen. Dan remt de groei, maar de limiet is geen absolute grens. Een super-Eddington zwart gat zou misschien mogelijk zijn bij een enorme, aanhoudende stroom van straling, maar die zou wel onvoorstelbaar groot en langdurig moeten zijn. Een tweede mogelijkheid is dat de mega-monsters direct zo groot geboren werden. Kolossale stofwolken zouden in het vroege heelal misschien direct tot zo'n mega-gat ineen gevallen kunnen zijn. Kosmologen gaven zulke zware objecten de naam 'zware zaden' ('heavy seeds') of ook wel 'hidden little monsters'. Men spreekt ook wel van 'Overmassive (of Outsize) Black Hole Galaxies' (OBG's). Ook deze verklaring klopt niet zomaar; dit soort enorme gaswolken zou steevast uiteen moeten vallen en in plaats van één vroeg megazwaar zwart gat een aantal sterren beginnen te vormen.
Kosmologen proberen een oplossing te vinden door met de JWST nog verder terug te kijken in de richting van de oerknal. Zo willen ze nog veel jongere zwarte gaten vinden, die dus nog niet zo enorm in omvang zijn, om als het ware hun 'geboortegewicht' te bepalen. Dat project heet de Cosmic Evolution Early Release Science Survey, afgekort CEERS. Inmiddels vonden ze enige dozijnen van die potentiële hidden little monsters, die herkenbaar zijn aan een breed uitgesmeerde spectraallijn van waterstof. Verder bevatten ze veel meer stikstof en veel minder zuurstof dan verwacht. Nog verder terug in het verleden verwacht men steeds vagere, lichtzwakke exemplaren te vinden. Het onlangs gevonden stelsel UZH1 - zie gisteren - bevat daar het tot dusver oudste exemplaar van en het ziet ernaar uit dat het een echte heavy seed bevat. Men speurt verder. De JWST heeft nog maar een uiterst miniem segmentje van het uitspansel onderzocht. Je vraagt je misschien af of de ruimtetelescoop in een bepaalde richting moet kijken om zo dicht mogelijk bij de oerknal te komen. Nee, dat maakt niet uit, elke richting is goed. De oerknal was overal.
Vannacht lichte vorst en ook overdag blijft het onder nul. 's Ochtends dwarrelt er wat lichte sneeuw langs de ramen. Anna gaat bij Nikita op Zaila passen. De bewolking trekt weg, steeds vaker is het zonnig. De noordoostenwind is koud en schraal. Vanwege het 'winterweer' worden twee gaswinningslocaties in Groningen tijdelijk weer op de waakvlam gezet. Dat is om om ze snel in bedrijf te kunnen nemen in geval van het uitvallen van ’s lands grootste gasopslag bij Norg. Waarschijnlijk kunnen ze woensdag alweer uit, omdat de vorstperiode slechts kort is.
Vanochtend werd op Cape Canaveral een Vulcan Centaur-raket gelanceerd van het bedrijf United Launch Alliancem. Hij brengt een onbemande maanlander in de ruimte, genaamd Peregrine, Die moet op 23 februari de eerste maanlanding van de Verenigde Staten sinds een halve eeuw gaan uitvoeren. Lukt dit, dan is het tevens de eerste succesvolle maanlanding uitgevoerd door een commerciële onderneming, Astrobotic Technology uit Pittsburgh (Pennsylvania). 'Leading America back to the moon'.
De lander vervoert onder meer vijf wetenschappelijke instrumenten van de Amerikaanse ruimtevaartorganisatie Nasa. Het betreft apparaten die op de maan gaan zoeken naar stoffen als water, koolstofdioxide, methaan en zwavel. De raket vervoert ook DNA of overblijfselen van 70 mensen en een hond mee. De mensen waren verbonden aan de sciencefictionserie Star Trek. Ze worden uitgezet in een baan om de zon. Andere menselijke resten worden op de maan gezet. Dat leidde tot protest bij de Navajo Indianen wegens ontheiliging van de maan. En, zie je wel, kort na de lancering raakt de missie in de problemen. De Peregrine slaagde er niet in zijn zonnepanelen uit te vouwen. Als die de boordaccu's niet kunnen opladen kan de missie niet verder. De grote Manitou straft onmiddellijk. Naar het begin van dit kwartaal
Gorinchem (24.009)

Dinsdag 09-01-2024
Gisteravond waren de geometrische beelden van de Pool Ryszard Winiarski een van de items in Binnenste Buiten van KRO/NCRV. Een bol, een kubus, een liggende cilinder, een ronde kegel en een driekantige piramide, alle vijf wit. Die staan vlakbij ons huis - dat je ook krijgt te zien - aan de andere kant van de sluis. Vroeger vond ik ze niet eens zo bijzonder, maar in de loop der jaren ging ik ze steeds meer waarderen. Ze zien eruit of ze daar zijn achtergelaten door buitenaardse bezoekers. Alsof ze met die stereometrische beelden een boodschap brachten en zich daarna snel uit de benen maakten. Het filmpje dateert duidelijk uit de tijd dat de bomen nog in blad waren. Op zeker ogenblik loopt onze illustere buurman Sjoerd van W. zomaar door het beeld. De presentator haalt ook het verhaal aan dat ze alle vijf dezelfde inhoud hebben. Ik heb dat nooit nagemeten, dus of het zo is? Er is in Gorcum in elk geval nog een ander abstract werk, waar dat zeker wel het geval is, op de Kleine Landtong, naast de Lange Brug. Dat is van Ewerdt Hilgemann, ook uit het eerste Symposiumjaar 1974 en het heet niet voor niks 'Drie gelijke volumes'.
Vannacht vroor het een graad of vijf à zes en vandaag blijft het om het vriespunt. Grote opwinding onder schaatsers. Vanavond is de eerste marathon, in Winterswijk. Vanaf donderdag verwacht het KNMI alweer dooi, maar gaande de komende week kan het opnieuw gaan vriezen. Vorstperiodes zijn bepaald zeldzaam aan het worden in Nederland, schrijft De Volkskrant vanmorgen. Het aantal ‘ijsdagen’, dagen waarop het 24 uur vriest, waren er begin jaren 60 nog gemiddeld tien. Nu zijn het er nog maar een stuk of zes per jaar. In 2014, 2020 en vorig jaar waren er zelfs helemaal geen ijsdagen in Nederland, iets dat in de vorige eeuw maar eens in de twintig jaar voorkwam. Enfin, we kleden ons warm aan, ik in het jack dat ik in begin 2020 in Antarctica droeg, en gaan naar de sportschool en daarna naar de AH. Eenmaal thuis zien we dat ik de druiven driemaal heb gescand; we hebben echter twee doosjes. Dat is het tegenovergestelde van winkeldiefstal.
Vandaag verschijnt ook de analyse van Copernicus, het Europese klimaatbureau, over het jaar 2023. Inderdaad het warmste jaar ooit gemeten. Bijna 1,5 graad (1,48 graad) warmer dan aan het einde van de 19e eeuw. Daarmee is het vorige wereldwijde hitterecord, uit 2016, ruim gebroken. Zulke hoge waarden zouden al 100.000 jaar lang niet zijn voorgekomen. Tijdens hittegolven werd het in Zuid-Europa lokaal 45 graden en werden in China en de VS zelfs temperaturen tot 50 graden genoteerd. Nog opmerkelijker waren de dramatisch hoge temperatuur van de noordelijke Atlantische Oceaan, bosbranden in Canada en de hoeveelheid zee-ijs rond Antarctica; ze braken niet alleen records, maar deden dat ook met zeer grote marges. Vanaf juni 2023 tot en met december werd zeven maanden op rij het wereldwijde maandrecord gebroken. De concentraties van de twee belangrijkste broeikasgassen, CO2 en methaan, bereikte in 2023 eveneens recordhoogtes, blijkt uit de metingen van Copernicus. Omdat de effecten van de nieuwe El Nino naijlen, is de kans aanwezig dat 2024 nog warmer wordt. Dat gebeurde ook na de vorige krachtige El Niño, in 2015. Dat jaar werd recordwarm, maar vervolgens overtroffen door 2016. Ook de 25e zonnecyclus draagt in 2024 wat extra warmte bij. Bovendien zou de klimaatgevoeligheid voor CO2 hoger kunnen zijn dan gedacht. Naar het begin van dit kwartaal
Gorinchem (24.010)

Woensdag 10-01-2024
Vannacht vroor het een graad of zes tot zeven. Vanochtend zien we dat de haven dicht ligt. Het vriest tegen tien uur nog ruim 5 graden, de hemel is blauw en de zon kruipt stralend achter de Altenawal omhoog. In de bloembakken hebben de winterviolen allemaal hun kopjes neergelegd. Ze kunnen ertegen. De rest van de dag is het net als gisteren om het vriespunt. Vannacht opnieuw matige vorst.
Microbioloog Marc Bonten vertelt vanmorgen in De Volkskrant dat er tijdens de coronapandemie enkele honderden patiënten waarschijnlijk zijn overleden aan het malariamiddel hydrochloroquine, vooral in de eerste periode. Het medicament leek toen nog beloftevol, maar dat duurde niet lang. Uit nieuwe doorrekeningen blijkt hoeveel schade het middel in diverse landen heeft aangericht. Wereldwijd zijn zeker 17 duizend mensen in de eerste fase van de pandemie overleden aan de bijwerkingen van hydroxychloroquine, blijkt uit die nieuwe analyse door Franse wetenschappers. Het is waarschijnlijk zelfs een onderschatting, benadrukt het team in vakblad Biomedicine & Pharmacotherapy, vanwege het gebrek aan gegevens uit de meeste landen. ‘Toch vind ik dat je dit niemand kunt verwijten', zegt Bonten. 'Dit was de eerste golf, de ic’s lagen vol, mensen gingen dood, we stonden met lege handen. En van dit middel wees laboratoriumonderzoek uit dat het misschien werkte'. Ja, dat snap ik, zo gaan die dingen, ze stonden met de rug tegen de muur, maar ik vrees dat de twitterende goegemeente zich massaal op hem en de Fransen zal storten.
De grote omslag kwam op 5 juni (2020), toen een grote Britse vergelijking tussen wel en niet behandelde patiënten liet zien dat de patiënten die hydroxychloroquine kregen, 11 procent méér risico op sterfte hadden. ‘Toen zijn alle studies gestopt’, herinnert Bonten zich. ‘In één klap was duidelijk: het is gewoon niet goed om dit aan patiënten te geven.’ Er werd in alle media terstond groot alarm over geslagen, maar inmiddels was het middel toen al omarmd door onder meer Donald Trump, die het een ‘gamechanger’ noemde: '...be put in use IMMEDIATELY. PEOPLE ARE DYING, MOVE FAST, and GOD BLESS EVERYONE!' Zo ook de Braziliaanse president Jaïr Bolsonaro en in Nederland Thierry Baudet, die het zelfs in maart 2021 nog een ‘goedwerkend middel’ vond. Hij beklaagde zich dat het toen (al meer dan een halfjaar - TZ) niet meer in Nederland gebruikt werd, 'Want u moet van lockdown naar “vaccin”'. Misschien kan de aanstaande parlementaire enquètecommissie coronabeleid daar ook wat onderzoek naar doen? Naar het begin van dit kwartaal
Gorinchem (24.011)

Donderdag 11-01-2024
Gisteravond heb ik met schoonzoon Michel het grootzeil in het autootje weten te krijgen. Vannacht weer matige vorst, een graad of zes. Vanochtend komt de zon op in een nog heldere hemel, want die zal in de loop van de dag vanuit het noorden snel bewolkt raken. Dan gaat het dooien. We rijden met het grootzeil naar onze zeilmaker. Anna moet op een smal stukje van de achterbank zitten met één been gestrekt, want het zeil ligt van voor naar achteren door de auto. Zo arriveren we twintig minuten later op een industrieterrein bij Made. De zeilmaker zal zorgen dat het grootzeil gewassen wordt. Dan rijden we door naar de werf in Numansdorp om te kijken hoe de boot erbij staat. In de loods zijn er steigers gebouwd langs de zijboorden (foto hier). Het oude teakdek is inmiddels verwijderd. Overal onder het oude teak was veel water; raar, want de boot staat al weken in de loods. Ook de voetrail is weg aan beide kanten (foto hier). Bij het losmaken van de voetrail kwam ook het teak eronder mee los. Een meevallertje. Aanwijzingen voor lekkage-gaten vonden ze niet onder de voetrail. Pascal is nu bezig alle oude schroeven te verwijderen, waarmee het teak aan het polyesterdek vastzat. Het zijn er misschien wel duizend. Sommige schroeven zijn gebroken; die moet hij dan eerst 'soevereinen' om het stuk afgebroken schroef te kunnen verwijderen. Die term kende ik nog niet. Het grote aantal gaatjes zou wel eens de oorzaak van onze lekkageproblemen kunnen zijn. In het dek moeten ze nu iets groter gemaakt worden om ze goed te kunnen afdichten. De vier oude afwateringsgaatjes voor het dek, die overigens meestal dicht zaten, verdwijnen ook. Als het polyesterdek helemaal schoon is komen er twee of drie lagen gelcoat overheen. De voetrail wordt vervolgens met kit teruggeplaatst en het kunstteak komt ertegenaan te liggen (niet neer eronder). Dat is evenhoog zodat buis- en regenwater er gemakkelijk overheen kunnen wegspoelen. Het is nauwelijks mogelijk dat we nog langer lekkage hebben.
Nieuwe zaken: een luchtbel in het polyester bij de kuip, het vervangen van de oude messing afsluiters, met giethars een vloertje leggen in de ankerbun, nieuwe stukjes slang bij de gasflessen en het fornuis, nieuwe wieken voor de windgenerator (de oude - nog uit Kreta - zijn versleten) en een nieuw stuk aan de ankerketting. Pfff...niet mis, allemaal samen, we zijn er enigszins beduusd van. Het is helemaal grijs bewolkt als we naar huis rijden, maar wel droog. Het is nog te vroeg voor files. Op het ijs in de haven staan al plassen smeltwater. Naar het begin van dit kwartaal
Gorinchem (24.012)
Vrijdag 12-01-2024
Ieder jaar houdt de American Astronomical Society in januari een congres. Dat levert de publicaties van heel wat opmerkelijk onderzoek op. Niet zelden is er zelfs opzienbarend nieuws. Zo ook dit jaar. PhD-student Alexia Lopez van de Universiteit van Central Lancashire bestudeert de grote structuren in het heelal. Daar schreef ik onlangs een paar keer over, onder andere hier. Nu maakt ze bekend dat ze een kolossale structuur had ontdekt, zó groot dat hij eigenlijk niet zou kunnen bestaan. Bij het onderzoek van tienduizenden verre quasars - dat zijn doorgaans superzware zwarte gaten in de centra van zeer verre sterrenstelsels, op afstanden van 13 miljard lichtjaar - vond ze een gigantische ring van actieve stelsels met een omvang van wel 3 miljard lichtjaar. Ze had al eerder (in 2021) zo'n enorme ringstructuur van stelsels ontdekt van 3,3 miljard lichtjaar, The Giant Arc op 9,2 miljard lichtjaar van de aarde. Het opmerkelijke is dat dergelijke mega-structuren volgens de gangbare opvattingen eigenlijk niet kunnen bestaan. Ze overschrijden een belangrijk kosmologisch beginsel, namelijk dat van isotropie: het heelal is op de grootste schaal in alle richtingen homogeen en hetzelfde. Alle materie zou gelijk over het universum verdeeld moeten zijn, vrijwel volledig vlak gestreken door de ultrakorte maar excessieve periode van kosmische inflatie direct na de oerknal. (Daar zijn mogelijk wel uitzonderingen op, maar niet van dit kaliber, geloof ik). Sinds de oerknal zou er namelijk onvoldoende tijd zijn geweest voor de vorming van samenhangende structuren groter dan zo'n 1,2 miljard lichtjaar, maar de laatste tijd is er vaker twijfel over het kosmologisch principe. De vondsten van Lopez schoppen het gangbare kosmologische model nu behoorlijk in de war.
Het gloednieuwe Vera Rubin Observatory, dat in 2025 in gebruik genomen gaat worden in Chili, zal hopelijk uitsluitsel geven, zegt Govert Schilling in De Volkskrant. 'Rubin gaat van vele miljarden sterrenstelsels de posities en afstanden bepalen. Dat leidt tot de meest nauwkeurige 3D-kaarten van het heelal. Dan zal ook blijken of kolossale structuren zoals de Giant Arc en de Big Ring echt bestaan'.
Vandaag een grijze dag, maar droog. Ik ga alleen sporten, want Anna stort zich al vroeg op de voorbereidingen van een diner. Vanavond komen Joop & Tonny eten. Daar verheug ik me op. Naar het begin van dit kwartaal
Gorinchem (24.013)

Zaterdag 13-01-2024
Nog een vondst die gepresenteerd werd op het jaarlijkse congres van de American Astronomic Association: een donker oer-sterrenstelsel. Karen O'Neil, senior-wetenschapper van de Green Bank-radiosterrenwacht (VS) vond bij toeval tijdens een onderzoek naar waterstofgas in LSB-stelsels – dat zijn sterrenstelsels met een lage oppervlaktehelderheid (low surface brightness) - iets bijzonders: een stelsel dat alleen maar uit gas bestaat. Plus natuurlijk heel veel donkere materie, vermoed ik, want louter gas zou niet voldoende zwaartekracht hebben om de zaak bij elkaar te houden. Het stelsel kreeg de naam J0613+52 en bevat dus helemaal geen sterren, alleen dicht oergas zonder enige aanwijzing voor stervorming. Ik neem aan dat het om waterstofgas gaat, het eerste abundant aanwezige gas in het vroege heelal dat verder nog wat helium bevat en een spoor van lithium. De kleuren op de foto hierboven zijn kunstmatig aangepast aan de waarschijnlijke rotatie van het stelsel. De blauwe kleur is licht dat naar ons toekomt, de rode is van licht dat van ons af beweegt. Op de foto ziet hij er dus mooier uit dan hij in werkelijkheid is. Andere stelsels zijn ver uit de buurt, zodat er geen ontmoetingen of botsingen met J0613+52 kunnen zijn geweest die stervorming aan de gang hadden kunnen brengen. Over de veronderstelde ouderdom c.q. afstand van het stelsel vind ik geen informatie. Misschien weten ze dat nog niet.
Zomer op het zuidelijk halfrond. Het is inmiddels zó warm op het Australisch continent dat vogels van de hitte dood uit de bomen vallen en vuilnishopen spontaan in brand vliegen. Fake news?, denk je even, helaas nee, het is wáár. In het noordwesten werd het daar deze week 46,6 graden Celsius.
Het is een grijze zaterdag, op de rand van miezer. Op de Kriekenmarkt halen ze vanmorgen de kerstboom weg. Nu zijn de feestdagen echt voorbij. 's Middags komen Tessa en Lina-Mae op de thee. Naar het begin van dit kwartaal
Gorinchem (24.014)

Zondag 14-01-2024
Er is al een paar dagen sprake van een inval van extreme kou in Canada en het oosten van de VS. De temperaturen zakken op verschillende plaatsen tot -40 graden en meer. Een arctische uitbraak, dus een snelle instroom van zeer koude lucht uit het Noordpoolgebied. Niet voor de eerste keer; ook in 2014 en 2019 waren er zulke uitbraken van ijskoude poollucht. Het beeld past bij veranderingen van de poolwervel (polar vortex), een cyclonale luchtstoom die altijd aanwezig is op 10 tot 50 km hoogte boven het Noordpoolgebied. Deze poolwervel verzwakt door de sterke opwarming van de polen, de arctische amplificatie, waardoor het temperatuurverschil met de evenaar kleiner wordt. De temperatuurgradient tussen equator en polen neemt af. De iets lager gelegen straalstroom verzwakt mee en daardoor ontstaan brede, koude wervelingen en lussen, die steeds verder naar het zuiden uitzakken en daar de ijskoude poollucht naar toe brengen. Zoals nu weer in de VS, maar het kan ook bij ons gebeuren. Omgekeerd kan 's zomers zeer warme lucht van de evenaar naar het noorden stromen en daar langdurige droogte en hittegolven brengen. Het plaatje hierboven laat dat goed zien. De enorme contrasten in koude lucht boven de VS en warme lucht boven de noordpool zie je geweldig goed in de projectie ervan (van vandaag) hieronder:
De ijzige kou in de VS ontlokt aan de brigades van klimaatwappies smalende reacties: climate warming is a hoax! Weerman Reinier van den Berg post er op X ook over. Ik heb niet de illusie dat het helpt. We hebben in Europees verband afgesproken dat over nog maar zes jaar onze uitstoot meer dan gehalveerd moet zijn ten opzichte van 1990 en we lagen met een reductie van 30 procent goed op koers, maar in ons land zijn de ontkenners van PVV en BBB nu bezig een regering te vormen die het ingezette klimaatbeleid weer zal afschaffen.
In IJsland is een nieuwe vulkaanuitbarsting. Ditmaal bereikt de lavastroom wel het dorpje Grindavik, waar ik ooit geweest bem. Dat was - meen ik - in augustus 1990, toen de 1e Golfoorlog op uitbreken stond. Ik was erop een congres. Aansluitend had ik een auto gehuurd om grote delen van het uitermate fascinerende landschap te kunnen zien. Ik heb er nog veel foto's van. Toen zwom ik ook in de warme meren, onder meer de Blue Lagoon, niet ver van Grindavik. Ook maakte ik een tocht met een vliegtuigje naar Kulusuk op Groenland en met een boot naar de Westmanneilanden en meer specifiek naar het eiland Heimaey. Het dorp werd in 1973 ook deels door een vulkaanuitbarsting verwoest. Dat kon je nog zien aan de delen van huizen die boven de lava uitstaken. Die lava was overigens nog altijd warm. De gids vertelde dat men destijds heel snel de bewoners moest evacueren. Ook de oude mensen uit het bejaardenhuis, van wie men in de haast alle gebitten van de nachtkastjes weggriste en bij elkaar in een emmer gooide. Eenmaal aan de vaste wal moesten ze uitzoeken welk gebit bij wie hoorde. Ik wilde nog een keer met de boot naar IJsland varen, maar het kwam er niet van.
Vandaag is het een kille, bewolkte dag. 's Middags gaan we naar de housewarming van het nieuwe huis van Jordin & Dane. Dat ligt vlak achter het huis waar Anna en ik in 2002 zijn begonnen met samenleven. Natuurlijk lopen we er even langs. We waren erg gelukkig daar. Nu ook (maar dan op het Eind). Gezellig om de familie weer even te zien. Op de terugweg valt vieze miezerregen. Naar het begin van dit kwartaal
Gorinchem (24.015)

Maandag 15-01-2024
Bij het ontwaken valt er juist een dichte sneeuwbui. Het blijft korte tijd liggen, zie de foto hierboven en hier een andere. Een strooiwagen rijdt door de straat. Code geel in het hele land van het KNMI. Er staan files van bij elkaar meer dan duizend kilometer. Zonder problemen rijden we naar de sportschool en daarna naar de Plus. De rest van de ochtend wisselen buien met hagel, natte sneeuw en regen af met zeer korte periodes zonneschijn. In de middag worden de zonnige periodes langer. De komende week hebben we meer winterse buien voor de boeg, vooral in het zuiden van het land.
Een verbazend bericht: na 35 jaar stopt de gemeente met de Open Havendagen en de Botenbeurs. Zo? Hoe jammer! Die evenementen waren altijd erg succesvol en gezellig, maar de gemeente zegt dat de belangstelling de laatste jaren is afgenomen. Dat is waar, we konden het nog afgelopen september zelf zien. Er lagen veel minder boten voor de verkoop. Eigenlijk liep de belangstelling al terug na de Covid-periode. Tja, maar met wat meer inspanning zou men de evenementen toch weer aan de gang kunnen brengen, zou je zeggen. Kennelijk ontbreken daartoe de lust en de inspiratie. 'Voor nu is het de hoogste tijd voor prachtige nieuwe initiatieven vanuit de stad', schrijft de gemeente. Welke dan? Dat staat er niet bij. Naar het begin van dit kwartaal
Gorinchem (24.016)

Dinsdag 16-01-2024
Voelt iedereen het? De spanningen in de wereld nemen al jaren toe, er zijn nieuwe oorlogen (Oekraïne) en oude conflicten vlammen ineens op (Israël en de Palestijnen). Gevaarlijke tegenstellingen verscherpen zich zoals de situatie China/Taiwan en van de beide Korea's. Allianties verzwakken zoals die tussen Amerika en Europa (Trump, toenemend isolationisme) en van Europa zelf (rechts-populisme, toenemende verdeeldheid). Het is alsof er zich een versnelling van de geschiedenis voordoet. Tegelijk nemen de mondiale problemen toe en sommige ervan worden onbeheersbaar: klimaatopwarming, de kloof arm/rijk, de oncontroleerbare globalisering van de economie, groeiende migratiestromen en de verkommering van natuur en milieu. Voeg daar nog bij: Arteficial Intelligence, autocratisch bestuur, pandemieën en cyberwar. De afgelopen weken heb ik twee boeken gelezen van Ingo Piepers over de dynamiek en ontwikkeling van het internationale systeem van staten en de rol van oorlog daarin sinds 1500. Ik schreef al eerder over Piepers op mijn blog, hier in 2016, hier in 2020 en onlangs hier. Ik las nu 'De onvermijdelijkheid van een nieuwe wereldoorlog' (Prometeus, 2020) en 'Van verval naar vernieuwing' (Politica Scripta, 2023). Zijn manier van schrijven is nogal saai maar zijn analyses in de dynamiek van oorlogen en boodschap zijn adembenemend.
Wel moet je enig inzicht hebben in chaostheorie en het gedrag van dynamische systemen die ver uit evenwicht zijn, dissipatieve structuren, thermodynamica en entropie. Het is ondoenlijk om hier eventjes de complexe gedachtengangen van Piepers uiteen te zetten, maar wel kan ik iets laten zien van de voorspellingen die hij doet. Dat doe ik aan de hand van bovenstaand plaatje, dat is gebaseerd op het boek uit 2020. Ik heb er zelf in rood wat aan toegevoegd. In 2020 voorspelde hij dat op basis van zijn model het mondiale statensysteem weer kritiek zou worden 'over plus of min twee jaar'. 'Volgens datzelfde model zal die kritieke periode circa zeventien jaar duren'.
Het plaatje toont de laatste kritieke periode (de piek links); dat was de 2e Wereldoorlog. Die bracht een nieuw evenwicht in het statensysteem met onder andere de oprichting van de Verenigde Naties en de Europese Gemeenschap, die in een halve eeuw uitgroeide naar de huidige EU. De vorige transitieperiode bracht de formatie van nationale staten en kolonialisme en duurde van 1500 - 1939, de nieuwe transitieperiode kent een mondiaal statensysteem. De jaren van de Koude Oorlog gaven een abnormale bevriezing van de dynamiek die vier decennia duurde, totdat in 1989 - 1992 door de val van de Sovjet-Unie de dynamiek van het statensysteem weer loskwam en spanningen en oorlogen opnieuw konden groeien. Piepers stelt dat het jaar 2011 daarin een kantelpunt was, waarin de spanningen mog steeds bleven oplopen maar niet meer door niet-systeemoorlogen geredresseerd konden worden. Nu lopen de spanningen dermate hoog op dat alleen systeemoorlog, waar alle grootmachten aan deelnemen zoals in de beide wereldoorlogen, een nieuw evenwicht kan scheppen. Die systeemoorlog lijkt nu in de maak.
Het is wat kort foor de bocht, maar hieronder in de context van Piepers een overzicht van de huidige toestand. De rol van de VS als grootse militair-economisch macht is nog steeds cruciaal, maar nieuwe grootmachten claimen een grotere invloed (China, India), terwijl andere op hun retour zijn (het VK, Frankrijk, Rusland). De EU slaagt er niet in zich als supermacht op te stellen. Oude en nieuwe grootmachten bezitten kernwapens. Het regelmechanisme van de VN-Veiligheidsraad is nog gebaseerd op de uitkomst van WO2 en is nu onmachtig. De NAVO is verzwakt en vormt geen eenheid. Nieuwe allianties vormen zich, zoals die van de BRIGGS-landen en van China-Rusland met Iran en Noord Korea. Welke grootmachten zijn partijen in de huidige oorlogen en conflicten? Op een rijtje. In Oekraïne: de VS, Rusland, een verdeelde EU en China. Midden-Oosten: de VS, het VK en Rusland. Taiwan: China, de VS en Japan. De Korea's: de VS, China en Rusland. De VS speelt nog een hoofdrol in alle conflicten, maar in de komende herfst zijn er presidentsverkiezingen die alles kunnen veranderen.
Vannacht viel er een centimeter of drie, vier sneeuw; vanmorgen zijn straten, kades en steigers nog witter dan gisteren. Het is een grijze ochtend maar sneeuw valt er niet meer. Ik maak een afspraak met de tandarts voor morgenochtend, want gisteravond voelde ik opeens dat rechtsboven een kroon in mijn gebit los zat. Vanmiddag is er veel zon. Anna krijgt onze bovenste buurvrouw op bezoek.
Rijkswaterstaat verwacht dat het water in de Rijn, Waal, Lek en de IJssel vanaf komend weekend weer gaat stijgen. Naar het begin van dit kwartaal
Gorinchem (24.017)

Woensdag 17-01-2024
Een bewolkte dag. De zon schijnt als een bleke, vage vlek door de grijze sneeuwlucht, maar sneeuw valt er niet. Die blijft hangen in het zuiden waar een lagedrukgebied over het noorden van Frankrijk naar Duitsland trekt. In de Ardennen valt veel sneeuw evenals in het zuiden van Limburg. Het is voor mij een medisch dagje. 's Ochtends stelt mijn tandarts vast dat ik een ontsteking heb onder een van de kleine kiezen rechts in mijn bovenkaak. Het is de kies waar ik al eerder problemen mee had. De tandarts maakt een X-foto. Je ziet de ontsteking als een zwarte wolk boven de kies zitten. In 2004 verrichtte kaakchirurg Louïse C. er in Utrecht een wortelkanaalbehandeling aan alsmede een apexresectie en er kwam een kroon op. Voor hoelang het duurt, zei ze. Nou, dat was dus twintig jaar, daar kan ik niet ontevreden mee zijn. Nu kan er niks meer mee, de kies moet eruit. Na lokale verdoving is de extractie een fluitje van een cent. Hechting niet nodig. De ontsteking moet nu genezen en het kaakbot ook. Na de zomer kunnen we eens kijken wat er mogelijk is. Zolang zit ik dus met een gat. Dat is een eind naar achteren, dus je ziet het niet.
Aan het eind van de middag moet ik naar het zorgcentrum aan de Mollenburgseweg, in de vroegere Exoduskerk, voor fundusfoto's van mijn ogen. Dat in het kader van de diabetescontrôle. Het autootje staat dik onder de sneeuw op de Krommenhoek. Dat is er zo af. Over een week of zo zal ik de uitslag van de foto's kunnen zien in mijn dossier bij de huisarts.
Vol verbazing kijk ik naar de kronkelige gang van zaken in de 1e Kamer rond de Spreidingswet. De wet die een eerlijke verdeling van asielzoekers over de gemeenten mogelijk moet maken. Hij werd in de 2e Kamer aangenomen terwijl de hele VVD-fractie tegenstemde. In de Eerste Kamer zullen de VVD-senatoren volgende week vóór de Spreidingswet stemmen. PVV'ers schelden op X: 'Landverraders!' en 'bom onder de formatie!'. Het is winst dat de wet er nu kan komen, maar de U-bochten van de VVD zijn niet meer serieus te nemen. Wilders reageerde meteen kwaad op X met 'MIJN HEMEL!'. Caroline van der Plas kreeg de lachers op haar hand met de reactie (in De Telegraaf) 'dat je nu in elke gemeente in Nederland een Ter Apel krijgt'. Dilan Yesilgöz blijft doen alsof er niets aan de hand is. De Telegraaf sprak gisteravond over 'een zwabberkoers' en zei dat de VVD-senatoren Yesilgüz 'voor joker' hebben gezet. De rechtervleugel van de VVD, zeg maar de NIMBY-brigade, wil de partijleider er zaterdag over een week op het VVD-congres in Noordwijkerhout (over de Europese verkiezingen) over aanspreken. Zal Rutte opnieuw voor zijn blunderende opvolgster in de bres springen? De vier formerende rechtse partijen hebben het er vandaag over. Aan het begin daarvan zei Wilders vanmorgen 'We hebben een probleem en daar gaan we zo over praten'. Hebben we een probleem? Nee, we hebben een democratie, Geert.
Raoul du Pré constateert in De Volkskrant dat Yesilgöz heeft gegokt en verloren, door de spreidingswet deel te laten uitmaken van een politiek schaakspel. 'Van der Burg gokte intussen ook: hij hield vast aan zijn voorstel, vanuit de verwachting dat uiteindelijk genoeg Eerste Kamerleden gevoelig zouden zijn voor zijn argumenten. Hij blijkt zijn eigen partij beter te kennen'. Du Pré meent dat de Vier, als ze straks moeite hebben om 'grip op asielmigratie' te krijgen, nog wel eens blij kunnen worden dat er een spreidingswet is. Naar het begin van dit kwartaal
Gorinchem (24.018)

Donderdag 18-01-2024
De opmerking duikt nog steeds af en toe op in gesprekken over klimaatopwarming tijdens verjaardagen of de borrel: plemp de Sahara vol met zonnepanelen! Gebruik die enorme, nutteloze zandbak om met duurzame, niet-fossiele energie voorgoed van fossiele brandstof af te komen! Het wederwoord maakte onder meer gewag van de ontelbare liters water om de onoverzienbare rijen panelen stofvrij te houden en hoe je de geproduceerde energie over de bevolkte wereld zou moeten verspreiden. (Via een internationale spreidingswet?) En hoe moet je al die energie vervoeren? Toch poogde het project Desertec, opgericht in 2009, serieus om dergelijke plannen gestalte te geven. Je hoort er weinig meer over. In een studie in Nature Communications and Environment van Chinese en Zweedse onderzoekers komt nog een andere complicatie aan bod. Dat heeft te maken met de beroemde 2e Wet van de Thermodynamica en meer speciaal de entropie, die zegt dat warmte nooit volledig in energie kan worden omgezet en dat er bij energieovergangen altijd warmte verloren gaat. Dat kan wel 80 tot 85 procent zijn.
Een kolossaal woud van zonnepanelen zou zóveel warmte afgeven aan de lucht boven de Sahara, dat het de wolkenvorming wereldwijd veranderd en daarmee het klimaat over de hele wereld beïnvloedt. De onderzoekers becijferden met behulp van een simulatie de mate van invloed. Onder meer het Midden-Oosten, Zuid-Europa, India, Oost-China, Australië en het zuidwesten van de VS worden bewolkter, wat daar kan resulteren in 5 procent minder opgewekte energie. Het omgekeerde gebeurt in onder meer Midden- en Zuid-Amerika, het Caribisch gebied, Midden- en Oost-Amerika, Scandinavië en Zuid-Afrika. 'In een wereld waarin bijna elke regio in zonne-energie investeert en er afhankelijker van wordt, kan een complex web van afhankelijkheden, rivaliteit en kansen ontstaan. Het geopolitieke manoeuvreren bij de bouw van zonne-energieprojecten door bepaalde landen kan het potentieel voor zonne-energie tot ver over hun nationale grenzen beïnvloeden', concluderen de onderzoekers op een blog over het onderzoek. Deze eerste becijfering kent nog vele onvolkomenheden; het probleem is zeer complex. Duidelijk is dat de 'oplossing' wereldwijd tal van nieuwe problemen met zich mee zou brengen, zowel in de zomers als in de winters. Weer een illusie minder, want hoe moet een wereld die steeds meer verdeeld raakt die Gordiaanse knoop door zien te hakken? (met dank aan dit artikel van Laura Wismans in de NRC).
Er heerst grote droogte in de Algarve en in Catalonië. Daar wordt het watergebruik door de overheden aan banden gelegd. In de Algarve wordt de watervoorziening in steden met 15 procent verminderd. Dat geldt ook voor hotels en golfbanen. Landbouwbedrijven moeten het met een kwart minder water doen.
In de Spaanse regio Catalonië is de situatie niet veel beter. Het gebied in het noordoosten kampt met de ergste droogte die daar ooit is gemeten. In een aantal plaatsen in Catalonië wordt de waterdruk al verlaagd. De autoriteiten gaan meer maatregelen nemen zodra de reservoirs voor 16 procent zijn gevuld. Dat duurt mogelijk niet lang meer, want de waterbergingen zijn nu nog maar voor 16,2 procent vol. Verder geldt er een verbod op het vullen van zwembaden, ook in de toerismebranche. Douches bij buitenzwembaden en op stranden mogen niet worden gebruikt.
Eeen droge dag met steeds meer zon. We gaan keurig sporten. Met de secretaris/penningmeester bereid ik de aanstaande vergadering van onze VVE voor. Verder lees ik op aanraden van Rommert de SF-roman: 'The Three-Body Problem' van de Chinese auteur Cixin Liu (Head of Zeus, 2014). Een uitstekende tip! Dit boek won veel prijzen en is deel 1 van een trilogie. Liu steunt overigens het regime in Beijing. Naar het begin van dit kwartaal
Gorinchem (24.019)

Vrijdag 19-01-2024
Vannacht valt er alweer sneeuw. Omdat de haven de afgelopen nachten was dichtgevroren levert de besneeuwde ijsvloer een mooi beeld op. Morgen een foto. Ik krijg bericht van de huisarts dat er een nieuw bericht in mijn dossier zit. Dat gaat over de fundusfoto's van mijn ogen, die eergisteren gemaakt werden. Ze zijn in orde; geen retinopathie. Het is een zonnige dag.
Ik ga vanochtend naar de werf in Numansdorp om te kijken hoe de boot erbij staat. Eerst ruiten krabben. Op de wegen is het vrij rustig. Ik arriveer tegen elf uur. Benno en Maarten kijken somber. Bereid je voor zeggen ze, je hebt een zware tegenslag. Benno neemt me mee naar de loods. De boot is verplaatst naar de schilderhal. Een hefplatform brengt ons op dekhoogte. Daar wordt het probleem me snel duidelijk. In het dek is het materiaal nog steeds kletsnat. In 2002 is bij Jeanneau-importeur Rob Krijgsman ons teak op het dek aangebracht met misschien wel duizend schroefjes (foto hier). Haastwerk bij de oplevering, veronderstelt Benno. Zo'n dek bestaat uit drie lagen; van boven naar beneden een laag glasvezel, een dikkere laag balsahout van ca. 1,8 cm, en weer een laag glasvezel. Balsa is de lichtste houtsoort die er is. De schroefjes zitten tot in het balsa geschroefd. Toen de naden van het teak gingen lekken, werd het balsa nat. En bleef nat en ging tenslotte rotten. Het vocht tast ook de glasvezelmatten aan en veroorzaakt een soort osmose (foto hier). De drie lagen van het dek konden gaan schuiven ten opzichte van elkaar. Dat zie je aan het cracqueleren in de laag epoxy op de glasvezel (foto hier). Het dek verliest zijn stevigheid en wordt zwakker. Nogal beduusd loop ik mee terug naar het kantoor. De bovenste laag glasvezel en de balsalaag moeten over het hele dek vervangen worden. Wat dat gaat kosten, weten ze nog niet. Maandag zullen ze het werk in kaart gaan brengen en een calculatie maken.
Nogal aangedaan rijd ik terug naar Gorcum. Daar arriveren juist Barbara en Nikita met Zaila. In de keuken stel ik Anna op de hoogte. Die is geschokt. We weten niet hoe we dit moeten oplossen. Hoe krijgen we die investering bij elkaar? Misschien de kapotte wasmachine niet vervangen? Een bijdrage aan Rob Krijgsman vragen? Na 22 jaar? Tja, hij was toen verantwoordelijk. Onze hypotheek verhogen? Of een afbetalingsregeling met de werf treffen? Maar is de boot het nog waard? En dat geld zien we bij verkoop nooit meer terug.
Koop je een nieuw schip en denkt dat alles in orde is. Krijgsman had nooit veel geluk met het afleveren van Dulce. Een jaar of vier na de oplevering bleek de kiel te kunnen 'wapperen'. De scheepshuid ter weerszijden van de kiel bleek te dun. Slechts 0,5 cm. Die kon daardoor plooien. Jeanneau haalde de boot op en bracht hem naar de fabriek in Frankrijk. Lees het vanaf hier op dit blog. Daar werden alle verbindingen met de spanten vernieuwd en de bodem verdikt tot 2,5 cm en werd ook een leemte onder de mastdoorvoer opgevuld. Een fabrieksfout. Dulce was niet de enige. Toen we na vijf weken de boot terugkregen bleek tot overmaat van ramp dat ze het teakdek hadden vernield met een hogedrukspuit. Op kosten van de onfortuinlijke Krijgsman werd dat toen hersteld. Enfin, hoe dan ook, we moeten komende week eerst maar eens horen hoeveel de schade bedraagt.
In een analyse schept De Volkskrant een beeld van een kabinetsformatie die dreigt te mislukken. 'Het rechtse kabinet komt maar niet van de grond, maar op nieuwe verkiezingen zit ook niemand te wachten'. Het bevestigt het beeld dat rechts-populisme tot niets constructiefs in staat is. Spil is vooral de VVD maar die partij is zwaar verdeeld. Een kabinet over links is voorlopig nog kanslozer. Niet alleen de liberalen maar ook Omtzigt en zijn NSC schijnen er ook niks voor te voelen. Nieuwe verkiezingen? Alle kans op dezelfde uitzichtloosheid. Ondertussen wordt er geen probleem opgelost, misschien met uitzondering van een begin aan een betere spreiding van asielzoekers. Zelfs dat is niet zeker. Naar het begin van dit kwartaal
Gorinchem (24.020)

Zaterdag 20-01-2024
Vannacht opnieuw een vorstnacht. De laatste of voorlaatste, geloof ik, daarna stijgen de temperaturen flink, er is een weeromslag op komst, we krijgen weer regen en wind en mogelijk zelfs een storm in de nacht van zondag op maandag en de dagen erna. Nog steeds ligt er sneeuw op de trottoirs en ter weerszijden van de sluis, alsook op het gras onder de grote esdoorn bij de geometrische beelden. En op de dunne, breekbare ijsvloer in de haven. Volgende week keert de herfst terug met temperaturen ver boven het 30-jarig gemiddelde, zeggen de meteorologen. Ach, er zijn nog twee maanden waarin de winter kan terugkeren.
In Amerika heeft extreme winterkou zich van kust tot kust genesteld. Een kleine week geleden schreef ik erover hoe een stagnerende lus van de poolwervel c.q. de straalstroom die arctische kou over het hele land uit laat vloeien. De kou verspreidt zich van de staat Oregon aan de westkust tot meerdere staten aan de oostkust. In Oregon is de noodtoestand uitgeroepen vanwege de kou en dodelijke stormen die de staat teisteren. Tienduizenden mensen zitten zonder stroom. Ook het zuiden van het land kent ongebruikelijk koude temperaturen. De verwachting is dat daar records gebroken gaan worden dit weekend. In sommige delen van het land komt de temperatuur niet boven de -35 graden uit. Er valt heel veel sneeuw en waait het hard. Door het winterweer zijn de afgelopen week al meer dan vijftig mensen overleden. In de stad Memphis in Tennessee braken door de kou zoveel waterleidingen dat de waterdruk in de hele stad daalde. Alle inwoners in de stad werden opgeroepen om eerst hun water te koken voordat ze het gebruiken.
Het is een prachtige, zonnige dag. Alleen nerds zoals ik blijven binnen met hun fascinatie voor fysische raadsels en dergelijke. Nou ja, als we van't zomer weer varen ben ik weer maanden buiten. In Cixin Liu's 'The Three-Body Problem' (Head of Zeus, 2014) lijkt de invariantie van natuurwetten opeens te zijn verdwenen. Daarmee verdwijnt de natuurkunde zoals we die kennen spoorloos. Dat de natuurwetten overal in de kosmos hetzelfde zouden zijn, is een beginsel dat voor het eerst werd geformuleerd door Galileo Galilei. Zo is bijvoorbeeld de snelheid van het licht in alle richtingen hetzelfde. Dat werd bewezen in het beroemde Michelson-Morley-experiment, uitgevoerd in 1887. Daarin werd de snelheid van het licht evenwijdig aan de baan van de Aarde vergeleken met de snelheid van het licht loodrecht op diezelfde baan. Men dacht dat de eerste lichtbundel door de rotatiesnelheid van de aarde een extra zetje mee zou krijgen. De snelheden bleken exact hetzelfde. Een raadsel. Die uitkomst werd later voor Einstein de basis van zijn relativiteitstheorie. Als die invariantie niet meer zou kloppen dan klopt er niets meer. Een origineel thema, ik ben razend benieuwd waar de Chinese auteur me heen voert. Naar het begin van dit kwartaal
Gorinchem (14.021)

Zondag 21-01-2024
Vandaag valt hij me meteen op, deze kopregel in De Volkskrant: ‘Een raketaanval op civiele doelen in West-Europa een waanzinnig idee? De Russen praten er constant over.’ Hij staat boven een interview met de Duitse onderzoeker en veiligheidsexpert Fabian Hoffmann, een PhD-student verbonden aan de Universiteit van Oslo. Hij benoemt een angst die me sinds de Russische inval in Oekraïne, bijna drie jaar geleden, niet meer verliet. 'Een reeks NAVO-topmilitairen waarschuwde nog onlangs voor het gevaar van een direct conflict tussen Rusland en de Navolanden. De toenemende onzekerheid over Amerika’s toekomstige betrokkenheid bij het bondgenootschap en de indruk dat het regime van Vladimir Poetin een permanent conflict met het Westen nodig heeft, voeden de urgentie'. Inderdaad, er is een grote kans op een systeemoorlog, lees hier en hier. Die kun je nauwelijks of niet vermijden. Afschrikking was altijd de kern van de NAVO-strategie, zowel nuclair als conventioneel. Na de ineenstorting van het Sovjetblok kwam daar de klad in door het gretig incasseren van het 'vredesdivident'. Europa bezuinigde enorm op zijn militaire vermogens. Dat zie je ook in de drastische vermindering van de idioot grote arsenalen van kernwapens bij de Amerikanen en Russen, waarmee de wereld meerdere malen vernietigd kon worden. Overigens zijn de huidige, afgeslankte arsenalen nog groot genoeg om de mensheid voorgoed uit te roeien. Hoffman bepleit nu een herstel van effectieve afschrikking, Dat biedt - als vanouds - de beste kans op het voorkomen van een direct conflict, zegt hij, maar het vereist behalve grote investeringen in militaire middelen ook maatschappelijke weerbaarheid en politieke wilskracht – 'en daar ontbreekt het aan'. Als voorbeeld noemt Hoffmann de ‘catastrofale’ weigering van de regering-Scholz om Taurus-langeafstandsraketten naar Oekraïne te sturen.
Volgens Hoffmann praten Russische generaals en opinieleiders in de media voortdurend over escalatie. Ze dreigen constant en in serieuze termen met een direct conflict dat begint met Russische langeafstandsraketten die civiele doelen treffen in West-Europa. Aan onze kant zijn we opgehouden daarover te denken, uitgezonderd op enkele defensieacademies. Veel mensen in het Westen denken: gooi het maar op een akkoordje met die Poetin, dat is veel goedkoper. 'Onze binnenlandse problemen en de opkomst van het populisme zijn een belangrijk signaal voor de Russen: we tonen ons verdeeld en intern zwak.' Hoffmann gelooft niet dat het uitgesloten is dat Rusland ons direct zal uitdagen.
Persoonlijk schat ik in dat Poetin voldoende realist is om geen MAD - wederzijds gegarandeerde vernietiging - te willen riskeren, maar ook de inzet van een beperkt, tactisch nuceair wapen in de slepende Oekraïense oorlog kan de wereld op een hellend vlak brengen. Hoe lang is Poetin nog aan de macht en wie zullen hem en zijn regime van kleptocraten opvolgen? Andere schatrijke criminelen, vrees ik, of hoge militairen met minder scrupules. Hoe lang kunnen de gewone Russen de oorlogseconomie volhouden? Hoe dan ook is het in mijn ogen verstandig dat Europa een dam opwerpt tegen de populistische dwaasheden van de verwende kiezers en zich snel militair verenigt en zijn conventionele capaciteiten flink versterkt. De interne vijanden moet men onder de knie zien te krijgen: Hongarije en Slowakije. De populistische premier Robert Fico wees gisteren op de publieke radiozender RTVS een NAVO-lidmaatschap van Oekraïne af en wil er desnoods een veto tegen uitspreken. Dat soort signalen wijzen op een verdeelde Europese defensie en moedigen het Kremlin aan. Ook bij ons vind je ze. Sinds het vertrek van partijleider Marijnisse hoort niet alleen populistisch rechts daarbij, maar evenzeer populistisch links. De nieuwe leider van onze SP Jimmy Dijck zei gisteren tegen De Volkskrant dat de onvoorwaardelijke steun aan Oekraïne moet stoppen. ‘De werkende klasse wordt als kanonnenvoer gebruikt, aan Russische en Oekraïense kant.’ De SP geeft de verdediging van de vrije democratie op. Naast domrechts hebben we nu ook domlinks.
Bij een systeemoorlog zijn meerdere kernmogendheden betrokken. In dit geval de VS, het VK en Frankrijk aan de ene kant, en Rusland, Noord-Korea en (op enige afstand) China en Iran. Het begint erop te lijken dat op de achtergrond de Val van Thucydides open is gegaan. 'The resulting structural stress makes a violent clash the rule, not the exception', zegt de Amerikaanse politicoloog Graham Allison in zijn boek 'Destined For War' uit 2017 over die Val. Volgens de definitie gebeurt dat wanneer een opkomende grootmacht (China) een bestaande grootmacht (de VS) dreigt te verdringen in zijn regionale of internationale hegemonie. Rusland is daarin niet eens de belangrijkste partij. Die economie is daarvoor te klein; het is alleen maar een grootmacht dankzij het grote kernwapenarsenaal, maar de opkomende economische en militaire wereldmacht China heeft de coulissen verlaten en geeft steeds meer steun aan Moskou en maakt er langzaamaan een vazalstaat van. Nog nooit werd een systeemoorlog uitgevochten door staten met kernwapens, behalve aan het eind van WO2, toen de Amerikanen als kersverse (en enige!) kernmacht Japan op de knieën dwong. Nu zijn er negen nucleaire machten (zie hierboven); zullen die in de komende systeemconfrontatie het gebruik ervan weten te vermijden? Daar heb ik een hard hoofd in. Verwacht een hoogtechnologisch Armageddon in een extreem opgewarmde wereld, een nieuw soort Leviathan die opstaat met AI-gestuurde vernietiging in zijn handen. Overdreven somberheid? Was het maar zo.
Vannacht nog lichte vorst, vandaag zet de dooi in. Er komt een langere periode met zacht en wisselvallig weer aan. Een groot deel van de sneeuw in de Duitse Middelgebergten zal daarom ook smelten, maar de hoeveelheid water, die dat samen met de regenval oplevert, zal niet heel groot worden, denkt Waterschap Rivierenland. Maar eerst krijgen we vannacht in het noorden en langs de kust een nieuwe storm, Isha. Naar het begin van dit kwartaal
Gorinchem (24.022)

Maandag 22-01-2024
Gistermiddag hadden we een gezellige housewarming party in het huis dat Nel M. & Frans R. kochten aan het smalle straatje tegenover ons op het Nonnenveld. Oud-Gorcummers, Anna kent Nel nog uit haar schooltijd. We ontmoetten ze eens in 2009 toen we in een haventje op het ruige bergeiland Ikaria lagen, in de Egeïsche Zee. 's Avonds gingen we uit eten in De Hoofdwacht met Michel & Barbara vanwege hun 30-jarig huwelijk. Hun jongste dochter Esri was ook mee en we hadden een fijne avond zoals de foto laat zien. Buiten woei Storm Isha mijn pet haast af.
Vanochtend is het grijs en het regent. We gaan naar de sportschool en als we eruit komen zijn de wolken deels weg en schijnt steeds vaker de zon. Anna haalt boodschappen in de stad. De wind neemt af. Storm Isha maakte veel schade op de Britse eilanden maar weinig bij ons. Op enkele plaatsen in het land woeien bomen om, wat tot verkeershinder leidde. Op de A2 bij Gouda waaiden glasplaten van een voertuig; de scherven op het wegdek leidden tot een file. De sterkste windstoten werden vanochtend in IJmuiden gemeten, zo’n 110 kilometer per uur. In de rest van het land woei de wind met zo’n 90 kilometer per uur. Alle windwaarschuwingen zijn inmiddels ingetrokken.
Storm Isha droeg wel bij aan een verlaging van de gasprijs. Doordat de storm de productie van windenergie flink aanjoeg, bereikte de Europese gasprijs het laagste niveau van de afgelopen zes maanden. Door de verhoogde windenergie hoeven gascentrales minder elektriciteit op te wekken. Daarnaast bracht de storm ongebruikelijke warmte voor deze periode van het jaar met zich mee. Het wordt bij ons in de middag een graad of tien.
De horrorstory rond PFAS gaat verder. Onlangs zat het gif in eieren van hobbykippenhouders verspreid over heel Nederland. Dus niet alleen in de omgeving van Chemours in Dordrecht. Nu blijkt dat nota bene deze gifstof door de boeren wordt toegevoegd aan hun bestrijdingsmiddelen. Dan werken ze beter. In Nederland spuiten en strooien boeren jaarlijks meer dan honderd ton aan PFAS-houdende pesticides op hun land. De populariteit ervan neemt bovendien toe. Pfas maakt dat pesticides langer blijven liggen en doorwerken. En het mag gewoon! Er is namelijk een uitzondering voor de landbouw. PFAS-pesticides bezorgen drinkwaterbedrijven nu al hoge kosten en kopzorgen. In 2022 zijn meerdere keren PFAS-houdende bestrijdingsmiddelen aangetroffen in de Rijn en de Maas in concentraties boven de veilige drinkwaternorm. Ondanks de grote zorgen over pesticides met PFAS vallen deze middelen buiten het aanstaande Europese PFAS-verbod. De Europese landbouwpolitiek staat toe dat de bevolking langzaam vergiftigd wordt. Ik vrees dat het onderwerp PFAS niet op tafel ligt bij de vier formerende partijen in Den Haag. Naar het begin van dit kwartaal
Gorinchem (24.023)

Dinsdag 23-01-2024
Hierbij de foto die ik eergisteren van de haven en ons huis maakte vanuit het keukenraam van het nieuwe huis van Frans R & Nel M. Zie je de zaak ook eens van boven. Na een zonnige ochtend met een graad of acht betrekt de hemel. In de rest van de dag zal het gaan regenen en waaien, vooral de komende nacht. Een nieuwe storm die de Britten Jocelyn hebben genoemd. Hij (of zij) zal daar opnieuw veel schade brengen, maar niet zozeer bij ons, lijkt het. Middag: Anna krijgt bezoek van haar vriendin van de Schuttersgracht.
De NRC valt het deze ochtend goed samen: de situatie in dit lachwekkende land. 'Nederland gaat een belangrijk zelf opgelegd stikstofdoel voor 2025 niet halen, zo blijkt onder andere uit een analyse van het RIVM. Daarmee overtreedt de regering de ‘stikstofwet’ uit 2021, en neemt de kans toe dat de rechter de overheid dwingt tot harde maatregelen zoals een krimp van de veestapel. Om dit te voorkomen zou de regering snel de stikstofuitstoot drastisch omlaag moeten brengen. Dit terwijl de formerende partijen overwegend negatief denken over hardere stikstofmaatregelen.' Het gaat om de Wet stikstofreductie en natuurverbetering die in 2021 werd ingevoerd. Ingevoerd maar niet uitgevoerd. In 2021 leed 72 procent van de natuur onder de neerslag van stikstof. De wet was één van de pogingen van het kabinet-Rutte III om de stikstofcrisis aan te pakken. Hij bepaalt dat vanaf 2025 in 40 procent van de Nederlandse kwetsbare natuurgebieden niet méér stikstof mag neerslaan. Dat doel is de facto onhaalbaar geworden omdat de regeringen sindsdien nauwelijks maatregelen troffen. De natuur in ons land verruwde en verkommerde en ging alleen maar verder achteruit. Slechts 32 boeren werden uitgekocht, terwijl de regering mikte op ongeveer 600. Het is een mengeling van onvermogen en onwil. Omdat de doelen van de wet wel juridisch zijn vastgelegd, is het stikstofbeleid vatbaar voor rechtszaken. Terecht. En dan? Een nieuw rechts-populistisch kabinet zal het desondanks niet aanpakken.
Meer idiotie. Ik word een oude mopperkont. Nieuwe auto's in Europa worden elke twee jaar gemiddeld een centimeter breder. Het is vaak nu al moeilijk om uit je auto te komen als je in een parkeervak naast een SUV staat. Die worden dus nóg steeds breder. en massiever. Veel SUV's zijn nu al twee meter breed, te breed om in de gebruikelijke parkeervakken van 2.40 meter in Europese steden te passen. Fietsers en voetgangers zijn ook de dupe van de nieuwe, zwaardere SUV's. Ook stoten ze meer broeikasgassen uit. Het dikke ego in zijn dikke auto. Voor bussen en vrachtwagens heeft de EU wel een maximum gesteld, maar voor personenauto's niet.
In de mailbox een rekening van mijn tandarts voor het trekken van een kies vorige week. Die zat al los en was er zo uit. Bovendien was het geen verstandskies achterin. Wat staat er op de declaratie? 'H35 el.nr. 15 Moeizaam trekken tand of kies met behulp van chirurgie'. Ik besluit de praktijk te bellen. Dan blijkt hoe het zit. De kies had een infectie aan zijn basis, had een kroon en een stift en twee wortelkanaalbehandelingen gehad. 'Eigenlijk had een kaakchirurg het moeten doen'. Ik had geluk dat hij er in een wip uitkwam, maar dat heeft voor de prijs geen effect. Oh.
Vanmiddag keurt de Eerste Kamer de spreidingswet goed met 45 van de 70 aanwezige stemmen. De senatoren van VVD, CDA, D66, ChristenUnie, PvdA-GroenLinks, Partij voor de Dieren, SP en Volt stemden voor de wet die een eerlijke verdeling van asielzoekers over alle gemeenten mogelijk moet maken. De tegenstand kwam van PVV, FvD, SGP, BBB, 50Plus en JA21. (NSC zit niet in de senaat). Van der Burg hoopt de wet nog deze week in het Staatsblad te publiceren en volgende week een besluit te nemen over de opvangcapaciteit per gemeente. Die moeten zich gaan voorbereiden op hun opvangtaak. De gemeente Westland toetert al meteen dat niet te zullen doen. 'Er is hier gewoon geen plek. We gaan ons er niet aan houden, zeker niet voor een Eerste Kamer die anders had moeten beslissen.' Ondertussen zitten de kassen in het Westland vol met arbeidsmigranten, die doorgaans in buurgemeenten als Den Haag slapen. De burgemeester probeert de zaak te sussen.
Tegelijk maakt de rechter in Groningen de zaak nog eens gecompliceerder. Doordat veel gemeenten geen asielzoekers willen opvangen blijft de opvang in Ter Apel te vol zitten. In het aanmeldcentrum mogen van de rechter niet meer dan tweeduizend asielzoekers verblijven. Het COA krijgt van de rechtbank vier weken de tijd om het aantal personen in het aanmeldcentrum onder de 2000 te brengen. Op dit moment zijn dat er 2.230. De opvangorganisatie beriep zich ter zitting op overmacht: te veel gemeenten stellen geen plekken beschikbaar. Gaat dat nu veranderen met de spreidingswet? De rechtbank erkende dat die niet meteen soelaas zal bieden. Dus moeten de vluchtelingen weer buiten in het gras gaan slapen? Tja, de rechter zit er kennelijk niet zo mee. Naar het begin van dit kwartaal
Gorinchem (24.024)

Woensdag 24-01-2024
In 2019 schreef ik in dit blog over de eerste foto van een zwart gat, die toen juist gepubliceerd werd. Vier jaar later verscheen de foto nog eens in de media, maar nu sterk verbeterd door generatieve AI (zie hier). Het ging om een foto die in april 2017 gemaakt was met de Event Horizon Telescope (EHT) van het kolossale zwarte gat in het centrum van het verre sterrenstelsel M87 op zo’n 55 miljoen lichtjaar afstand van hier. Nu verschijnt er in Astronomy & Astrophysics een nieuwe foto. Daarop zien we dat zwarte gat zoals het er op 21 april 2018 uitzag, een jaar en tien dagen later dan op het eerste beeld. Je ziet meteen het verschil. Het zwarte gat is de donkere plek in het midden. De helderste plek op de ring rond het zwarte gat wordt veroorzaakt door het materiaal dat met hoge snelheid om het zwarte gat heen kolkt. De heldere plek is zo’n dertig graden naar rechts verschoven en ligt nu op de locatie waar de wijzer van een klok op 5 uur zou staan. De verschuiving op de nieuwe foto vormt een bevestiging van de in 1915 door Einstein beschreven algemene relativiteitstheorie, die astronomen gebruiken om zulk gekolk te modelleren. Vanaf nu kan men met nieuwe foto's de activiteiten van het zwarte gat volgen. In de loop van dit jaar zal er weer een worden gemaakt.
Het is een veelbetekenend gebeuren. De Nederlandse VVD'er Malik Azmani, interim-fractievoorzitter van de liberale fractie in het Europees Parlement stelt zich niet kandidaat om fractievoorzitter van die partij te worden. Hij had aanvankelijk de beste papieren maar hij weet dat hij zal verliezen omdat er binnen de liberale EU-fractie veel weerstand bestaat tegen de formatiegesprekken tussen de VVD en de PVV voor het nieuwe Nederlandse kabinet. Bij de Duitsers en de Fransen is iedere vorm van samenwerking met radicaal-rechtse partijen taboe. Nu die partijen bij de komende Europese verkiezingen flinke winst dreigen te boeken, willen ze alvast zoveel mogelijk een dam opwerpen tegen hun invloed. Daarom liggen de formatiegesprekken in Nederland tussen de VVD en de PVV in Brussel zeer gevoelig.
Erdogan ging akkoord met het Zweedse NAVO-lidmaatschap; het Turkse parlement stemde gisteren vóór. In ruil mag hij Amerikaanse F16's kopen. Nu is alleen Orbán nog over als tegenstander. De Hongaar dacht een dag eerder er nog een slaatje uit te kunnen slaan. Hij stuurde de Zweedse premier Ulf Kristersson snel een uitnodiging om te komen onderhandelen over de toetreding. De Zweed had er geen boodschap aan. Hij zag geen reden om te onderhandelen. Vandaag laat Orbán telefonisch aan NAVO-chef Stoltenberg weten dat Hongarije 'nog altijd' achter het Zweedse NAVO-lidmaatschap staat. Zweden wordt het 32e lid.
Storm Jocelyn bracht op een aantal plaatsen in het land schade door omgewaaide bomen bij windvlagen. De wind draait in de loop van de ochtend en neemt vooral in het zuiden van het land in de ochtend snel af. Het was de derde storm van dit jaar. Deze slaagt erin om vanmorgen mijn pet in de haven te waaien. Hij zinkt meteen maar ik was niet van plan hem na te springen. Ik heb er nog een. Verder werd er gisteren voor het eerst een dagrecord gebroken; het werd 12 graden in De Bilt. Het blijft vandaag een grijze dag. Naar het begin van dit kwartaal
Gorinchem (24.025)

Donderdag 25-01-2024
Aanvankelijk leek Antarctica niet mee te doen aan de opwarming. Het areaal van zeeijs bij het zuidelijkste continent nam decennialang niet af. Dat is sinds ca. 2012 omgeslagen in een drastisch verval. Ook in 2023 daalde de hoeveelheid zeeijs daar snel. Wat is de betekenis daarvan? Niet alleen dat de de opwarming ook daar toeneemt, maar ook dat de albedo er minder wordt. Zeewater is donkerder dan zeeijs, kaatst minder zonlicht terug en absorbeert dus meer warmtestraling. Een positieve terugkoppeling. Meer opwarming zeewater > minder zeeijs > meer opwarming zeewater, enzovoorts.
Klimaatbeleid is notoir moeilijk. Het klimaat is een dermate complex systeem dat men vaak niet precies weet welke effecten maatregelen kunnen hebben. Dat is ook een probleem bij technofixes. Schepen die vloeibaar aardgas verstoken (LNG) stoten beduidend minder CO2 uit dan bij het gebruik van stookolie, wel een kwart minder In de eerste helft van vorig jaar werd al duidelijk dat boven scheepvaartroutes de concentraties vervuilende zwaveldioxide (SO2) sterk afnamen als gevolg van het gebruik van die schonere brandstoffen. SO2 heeft in de atmosfeer een koelend effect omdat het de opname van warmte in zee vermindert. Vorig jaar waren de oppervlaktetemperaturen van zeewater flink hoger dan normaal, met name in de noordelijke Atlantische Oceean waar drukke scheepvaartroutes zijn. Daarnaast blijkt uit een nieuw onderzoek van de Internationale Raad voor schoon vervoer (ICCT) dat zeeschepen die varen op vloeibaar aardgas veel meer van het broeikasgas methaan uitstoten dan verondersteld. De klimaatimpact van LNG is dertig tot zeventig keer zo groot als die van CO2. Het leven is niet gemakkelijk.
De ochtend komt met ochtendrood, maar het raakt al snel bewolkt. Sportschool, supermarkt. Op het middaguur komt Barbara langs met Zaila. Later komt Nikita er ook bij. Zaila toont steeds meer interesse voor mijn boekenkamer. Ze komt alsmaar kijken. "Tom...'
In het nieuws lees ik dat zangeres Melanie is overleden. Net als ik is ze uit 1947. Ze was een van de groten in onze jaren 60. Robert van Gijssel vertelt in De Volkskrant een mooie anecdote: 'Op het festival Woodstock in 1969, de apotheose van het hippietijdperk, zong een 22-jarige vrouw met een gitaar in de inmiddels stikdonkere nacht, in de stromende regen, met net één podiumlamp op haar gericht. Maar haar stem verlichtte de hemel toen zij haar lied 'Birthday of the Sun' inzette, met een paar rauwe slagen op een akoestische gitaar. ‘I found the birthday of the sun’, zong zij met een vocale oerkracht die Woodstock deed sidderen. ‘And all things change. Now I’m sure it’s the birthday of the rain.’' Naar het begin van dit kwartaal
Gorinchem (24.026)

Vrijdag 26-01-2024
Vanmorgen rijden we in de regen naar de werf in Numansdorp voor een bespreking met Benno en Maarten. Intussen hebben ze een vierkant stukje van het dek verwijderd op een van de plaatsen waar het altijd lekte, boven de garderobekast van Anna aan stuurboord. De balsablokjes zijn nu verwijderd en de bodem (van glasvezel) toont verschillende gaten en zelfs een scheur. Daar lekt het dus door. De balsablokjes ter weerszijden van het vierkant zijn zacht van het rotten (foto hier). Hier was het dus altijd kletsnat en dat bleef zo, ook als het niet regende. Zo is het over het hele dek, van voor naar achter. Dat is niet mis! We bespreken de werkzaamheden om het dek te vernieuwen. Die houden in dat het oude dek er helemaal af gaat en dat op de onderste glasvezellaag eerst vier nieuwe lagen laminaat worden aangebracht. Daarop komt geen balsa maar 10 mm dik schuimplaat als kermateriaal. Daarover tien lagen EBX600 met epoxy. Vervolgens het dek glad plamuren met epoxyplamuur, dan schuren en afwerken met vijf lagen epoxy-primer.
Dat hakt er financieel flink in! We besluiten tot een paar bezuinigingen uit ons oorspronkelijk plan, zoals de vervanging van de kapotte wasmachine. Dat kan een jaar later, zolang redden we het wel met het Mestic-machientje Het leggen van kunstteak laten we wel doorgaan; daar hadden we al een deel van aanbetaald. We besluiten de hele schadepost te claimen bij onze bootverzekeraar Unigarant. We rijden terug naar Gorcum. Ondertussen is de zon gaan schijnen. Anna gaat naar haar jeugdvriendin om het verhaal te doen. Ik ben de hele middag bezig met het aanmelden van de schadeclaim bij onze tussenpersoon en bij Unigarant. Natuurlijk ligt de oorzaak in een ver verleden, in 2002. Toen werd het teakdek ondeskundig aangelegd in opdracht van de Jeanneau-importeur. De honderden schroefjes dienden om het juist gelegde teak vast te drukken in de lijmlaag op het dek. De schroefjes zitten vast in het balsa. Is de lijm hard geworden, dan moeten al die schroefjes er weer uit en de gaten moeten gedicht met kit. Dat is niet gebeurd. Je kon het niet zien omdat ze onder de rubbers zaten. Ruim 20 jaar lang kon water langs de schroefjes doordringen in het balsahout. Dat werd nooit echt meer droog, ging rotten en werd zacht. Zo gaat de stijfheid uit de rompconstructie. Is 20 jaar te lang voor de verzekeraar? Dat zou lullig zijn; we hadden het niet eerder kunnen constateren, zou ik zeggen. Enfin, zolang de melding loopt staat het werk aan onze Dulce even on hold. Naar het begin van dit kwartaal
Gorinchem (24.027)

Zaterdag 27-01-2024
Ik heb er steeds op gehoopt de ontdekking van buitenaards leven mee te kunnen maken, Vijftien jaar geleden had ik daar meer vertrouwen in dan nu. Dat is een gevolg van ouder worden; er is voor mij minder tijd over waarin de wetenschap die vondst doet. Destijds - in 2006 - haalde ik kosmologen aan die zeiden 'the universe could be teeming with life'. In dit geval was dat de astronoom Barry Jones in 2004. Dat is alweer 20 jaar geleden en het is niet gevonden. Ik denk nu dat de meeste kans is dat men bewijzen van vroeger microbiologisch leven ontdekt in de bodemsedimenten op Mars, waar eens miljoenen jaren lang water was, bijvoorbeeld een oeroud, diep meer zoals er in de Jezerokrater ooit was, waar nu het Marswagentje Perseverance sinds 2021 over de schrale bodem rondrijdt. De zeswielige rover maakte daar in 2022 ondergrondse scans van de rotslagen tot 20 meter diepte. De resultaten staan deze maand in een artikel in Science Advances. De scans van de rotslagen vormden het onmiskenbare bewijs dat de door water meegevoerde bodemsedimenten in de Jezero Crater werden afgezet door een rivier. De barre planeet was dus ooit een bewoonbare en levendige habitat waar microbieel leven mogelijk kon ontstaan en welg tiieren. Nog vorige maand schreef ik over de epische tocht die het Marskarretje dit voorjaar zal maken naar de kraterrand en verder. Op zijn tochten verzamelt Perseverance bodemmonsters die hij op een strategische plaats deponeert. Ze moeten over nog onbepaalde tijd door NASA en ESA opgehaald worden met een Sample Return Missie en naar de aarde gebracht. Daar kunnen fossiele resten van leven in zitten. Wie weet leef ik dan nog. Als die fossielen niet op aardse vormen lijken, dan hebben we het bewijs dat ook buiten de aarde leven kan ontstaan. Ik zou het - geloof ik - een opluchting vinden, nu we zo'n zootje van onze eigen wereld maken. Plus een einde aan de beklemmimg dat we de enigen zouden zijn in het gigantische, onverklaarbare heelal.
De Noordzee is een afvalpuinhoop geworden. Zo sloegen er op Nieuwjaarsdag 2019 naar schatting 342 containers met in totaal 3 miljoen kilo aan spullen van het schip MSC Zoe overboord ten oosten van Ameland. Een deel daarvan werd uit zee gehaald door Rijkswaterstaat en vissers. Veel spullen spoelden aan en werden opgeruimd door Natuurmonumenten, Staatsbosbeheer en vrijwilligers. Ongeveer een kwart van de soms hagelnieuwe spullen in de containers is nooit geborgen en ligt nog onder water, bij elkaar zo'n 800.000 kilo troep. Veel ervan bestaat uit plastic, dat nooit meer weggaat en tot grote mileuschade leidt. De overheid heeft het nu officieel bestempeld als 'zwerfafval', dan hoeft het niet meer opgeruimd te worden. Dat is typerend voor deze samenleving. Wat zegt een woordvoerder van Rijkswaterstaat ervan? Dat het klopt. 'Het ministerie heeft een overeenkomst gesloten met de reder', zegt hij. 'De reder heeft het afgekocht. Het is nu dus zwerfafval, dat betekent dat er niet actief naar gezocht gaat worden'. Bizarre wereld.
Het is een mooie dag met veel zon. Een graad of zeven, acht. We doen wat boodschappen in de stad. Ik verzend de stukken met foto's van het rottende dek van Dulce naar de tussenpersoon van onze bootverzekering. In het begin van de middag komen Barbara en Nikita langs met Zaila. Aan het eind van de middag komen Tessa en Vajèn ook nog. Naar het begin van dit kwartaal
Gorinchem (24.028)

Zondag 28-01-2024
Deze cartoon buitelde de afgelopen dagen door de sociale media. Niet in de laatste plaats omdat hij (op X) werd geplaatst door Geert Wilders zelf, midden in een gevoelig formatieproces met drie andere rechtse en populistische partijen. Opmerkelijk omdat de PVV-leider er wordt getoond naast twee wereldwijde reactionaire coryfeeën als Trump en de Argentijnse president Milei, dit keer zonder cirkelzaag. Met zijn drieën pareren ze aanstormende rampen die de mensheid belagen: cultural marxism in combinatie met socialisme, open grenzen en klimaatverandering. Cultural marxism is een centrale term in het neofascistische en antisemitische jargon. Tegenwoordig gebruiken Baudet, zijn leermeester Paul Cliteur en de FvD hem regelmatig. De cartoonist Ben Garrison hoort ook in dat rijtje thuis. Zijn spotprenten hebben regelmatig een expliciet anti-Joodse inhoud. Hij is een fervente anti-moslim, een aanhanger van de omvolkingstheorie en inzake Covid19 was hij een overtuigde wappie. Het mag desalniettemin verbazen dat Wilders hem juist nu plaatst. Het wekt op zijn minst de indruk dat hij achter dit 'gedachtengoed' staat. Of is het ijdelheid, omdat hij er zelf op voorkomt? Met twee wereldwijd bekende rechts-populisten? Zijn weergave door Garrison lijkt trouwens helemaal niet. Aan de gewenste groei van vertrouwen kan deze post onmogelijk een bijdrage leveren.
De mensen in het globale Westen hebben zich decennialang kunnen wentelen in vrede, veiligheid en welvaart. Ze zijn postmodern geworden en daardoor ongeschikt voor de wereld waarin we nu leven, een wereld van macht en kracht, schrijft Rob de Wijk in een korte column in Trouw. Kernachtig samengevat en heel juist in mijn ogen. De Wijk heeft weinig fiducie meer in de mensheid. Het ene deel is agressief en crimineel en het andere verwend en passief. Wat er nog overschiet is arm en ellendig als ze niet wanhopig op de vlucht zijn. De Chinese SF-auteur Cixin Liu kan er ook wat van. In zijn magistrale boek 'The Three-Body Problem' (Head of Zeus, 2007/2015) schrijft hij '...the common people did not seem to have the comprehensive and deep understanding of the highly educated about the dark side of humanity.' Maar dat is een roman, dus fictie. Het eerste niet.
In zijn column in de NRC stelt Arnout Brouwers vast 'dat voor Europa het Amerika-loze tijdperk al is aangebroken, iets waar het ook dertig jaar na de Koude Oorlog nog absoluut niet op is voorbereid.' Zelfs als de grote deal tussen Democraten en Republikeinen, waarbij Oekraïne nog 60 miljard steun krijgt in ruil voor concessies inzake immigratie en bewaking van de Amerikaanse zuidgrens met Mexico, er alsnog zou komen. Want Donald Trump heeft gezegd die deal te zullen torpederen. Ik had dat gemist in onze kranten. Brouwers: 'Europa’s ultieme Gratis Bier-tijdperk loopt ten einde. Zoiets had een berichtje verdiend. Geen wonder dat Europese generaals hun samenlevingen proberen wakker te schudden.'
Opnieuw een fraaie, zonnige dag. Op een of andere manier heb ik een soort abonnement op de tandarts. Gisteravond zat er opeens een vulling los aan de achterkant van een voortand in mijn bovenkaak. Morgen maar weer bellen voor een afspraak. Vanavond komen Wiger & Arina eten. Dat kan ik nog wel, voorzichtig. Naar het begin van dit kwartaal
Gorinchem (24.029)

Maandag 29-01-2024
Het Britse MetOffice publiceerde gisteren een nieuwe recordtemperatuur in het Schotse Kinlochewe, waar het afgelopen zondag 19,6 graden Celsius werd. Steeds vaker weet ik niet meer hoe je de boodschap moet brengen dat we ons op toenemend hellend vlak bevinden. Moet ik ook soep tegen de Mona Lisa gooien? Misschien maakt dit plaatje, gebaseerd op het laatste IPCC-rapport AR6 2023, het duidelijk? In 2023 was de gemiddelde wereldtemperatuur de hoogste in 125.000 jaar. Dat was het laatste complete interglaciaal. De Parijse norm van +1,5 graden sinds het begin van het industriële tijdperk werd vrijwel bereikt. De verontrustende versnelling van de opwarming van onze wereld in de laatste 50 jaar is goed te zien. Zo is het dus, je vindt alles terug in dit plaatje, niemand die van zinnen is kan er nog omheen. We moeten ons gebruik van fossiele energie veel sneller stoppen als we de wereld leefbaar willen houden voor onze kinderen en kleinkinderen.
Maar de wereld komt nauwelijks of niet in beweging. De jaarlijkse COP's, de klimaatconferenties, zijn een aanfluiting geworden. De website Klimaatverandering noemt ze 'vooral een klucht'. 'De COPs zijn verworden tot een show waar de zwakste plannen met de grootste bombarie worden gepresenteerd. (...) Veel plannen zijn te vaag geformuleerd, of missen duidelijkheid in dekking of verantwoordelijkheid om daadwerkelijk getoetst te kunnen worden op hun impact.' Het is moeilijk om hoopvol te blijven, schrijft Arthur Oldeman op de website. 'Zo las ik dat een startup is begonnen met het verschepen van ijs uit de Groenlandse fjorden om als ijsblokjes in cocktails te belanden. Met als eindbestemming: Dubai, Verenigde Arabische Emiraten.' De wereld is krankzinnig aan het worden.
Het conflict tussen de EU en de Hongaarse president Orbán, die nieuwe steun aan het door oorlog verscheurde Oekraïne al sinds december dwarsboomt, loopt op een confrantatie uit. Pas geleden zei Orbán dat hij het steunpakket van 50 miljard euro komende donderdag opnieuw zal blokkeren. The Financial Times legde de hand op geheime documenten waarin staat dat Brussel de subsidiekraan wil dichtdraaien als Orbán niet overstag gaat. Zonder die steun, zo citeert de krant uit het plan, is het aannemelijk dat 'financiële markten en internationale bedrijven minder happig zullen zijn om in het land investeringen te doen’. Daarmee zou de munteenheid van Hongarije, de Hongaarse forint, in zwaar weer kunnen komen. De FT spreekt daarbij zelfs van het 'saboteren' van de economie van het Oost-Europese land. Het lijkt erop dat Orbán onder die druk zal toegeven. Internationale persbureaus melden vandaag dat nieuwe steun voor de Hongaarse leider toch bespreekbaar is. Mooi zo.
Vanmorgen een rozerode dageraad. Daarna een frisse, zonnige dag. Ik verleng bij het E-loket van de gemeente online onze parkeervergunning voor dit jaar. 's Middags zet de tandarts een nieuwe vulling in mijn voortand boven/links). Naar het begin van dit kwartaal
Gorinchem (24.030)

Dinsdag 30-01-2024
Mona Keijzer is een van die politici waar je alleen maar je schouders over op kunt halen. Zo'n prototype van een kortzichtig 'doe-maar-gewoon' mens. Ze was (of is?) premierskandidaat voor BBB. Nu vindt ze dat er serieus gekeken moet worden naar het terugsturen van Oekraïense vluchtelingen naar veilige delen van hun eigen land. Nee, zeg! Omdat de Russen niet weten door te breken op de fronten gingen ze overal in Oekraïne op grote schaal bombarderen en proberen ze infrastructuur te verwoesten en de bevolking murw te maken. Er bestaat geen veilig gebied in Oekraïne. Misschien kunnen we Mona beter terugsturen naar Volendam.
Het is een grijze, bewolkte dag. We gaan 's ochtends naar de sportschool, Verder geen nieuws. Vandaag arriveerde 'The Dark Forest' (Head of Zeus, 2008/2015), het tweede deel van de The Three Body-trilogie van de Chinese SF-auteur Liu Cixin. Ik begin er meteen aan. Hij vindt dat contact met een buitenaardse intelligentie een hachelijke zaak zou zijn; de grootste bron van onzekerheid voor de toekomst van de mensheid. 'Other great shifts, such als climate change and ecological disasters, have a certain progression and built-in adjustement periods, but contact between humankind and aliens can occur at any time.' Dat komt uit zijn nawoord van deel 1 van de trilogie. Naar het begin van dit kwartaal
Gorinchem (24.031)

Woensdag 31-01-2024
Op de dagelijkse weergave bij ClimateReanalyzer van temperatuurafwijkingen in de wereld zie je vandaag dat er in Canada sprake is van extreme opwarming en eveneens in het eigenlijke noordpoolgebied boven Groenland. In de westelijke provincie British Columbia meet men record-temperaturen. In Maple Creek, Saskatchewan, mat men zelfs 21,1 graden Celsius op de thermometer, meer dan op hetzelfde tijdstip in Key West in het tropische Florida. Een hittegolf in het midden van de winter. Normaliter zou het zeeijs in deze periode flink moeten aangroeien, maar dat gebeurt niet, de omvang ervan neemt al 6 dagen op rij af. Zo'n kortdurende afname is op zichzelf overigens niet abnormaal. Waarschijnlijk een uitzakker van de poolwervel en de steeds tragere straalstroom, een gevolg van doorgaande polaire amplificatie.
Vandaag verschijnt bij het KNMI de jaarijkse Staat van het Klimaat. Het rapport bevestigt wat de lezers van dit blog al wisten, namelijk dat 2023 wereldwijd het warmste jaar ooit gemeten was. Nederland had zelfs een dubbelrecord, het was tevens het natste jaar terwijl er nota bene ook nog een droogterecord werd gebroken. De Bilt noteerde tussen 13 mei en 20 juni namelijk de langst aangesloten periode zonder ook maar een spat regen. Die grilligheid demonsteert hoezeer ons klimaat verandert. Lees er hier meer over.
Vandaag kun je in de Staatscourant zien hoe de dit jaar benodigde 96.000 opvangplekken voor asielzoekers in het kader van de Spreidingswet verdeeld worden over de provincies en de gemeenten. Zuid-Holland moet de meeste plekken leveren: 19.776 omdat het tot dusver de minste opvang bood. Voor Gorcum komt het neer op 199 plaatsen, waarvan 17 voor amv's (alleenstaande minderjarige asielzoekers. Ik neem aan dat ons gemeentebestuur er niet zoveel moeite mee heeft, hoewel? Aan de Buys Ballotstraat wordt een tijdelijke opvang gebouwd met onderdak voor 150 mensen. Dat is aan de buitenrand van een bedrijventerrein. Er kwam wat protest van omwonenden, maar de gemeente zette het plan door. Gorinchem heeft ook de bewoners van de Gildenwijk beloofd dat de tijdelijke opvang van 300 statushouders in het oude belastingkantoor aan de Vroedschapstraat eind van dit jaar zal sluiten. Daarmee zette het zichzelf klem. Het gebouw functioneert al jaren zonder problemen. Dat pand kan natuurlijk goed gebruikt worden voor de resterende 49 asielzoekers.
Morgen, 1 februari, treedt de Spreidingswet in werking. Gemeenten die de komende vijf jaar meer dan het aangewezen aantal asielzoekers opvangen, krijgen een bonus van het ministerie van Justitie en Veiligheid (van mevrouw Yesilgöz). Het gaat om 2000 euro per opvangplek. De gemeente Westerwolde met Ter Apel kan miljoenen verwachten. Volgens de wettelijke verdeling hoeven ze er slechts 131 op te vangen.
Een overwegend grijze dag. Rond het middaguur af en toe zon. Naar het begin van dit kwartaal
Gorinchem (24.032)

Donderdag 01-02-2024
Sinds jaar en dag weet iedereen in de wereld dat we afhankelijk zijn van de regenwouden, maar de bewering dat het Amazonegebied verantwoordelijk is voor 20 procent van onze zuurstof, klopt niet. De regenwouden zijn niet 'de longen van de aarde', zoals je vaak hoort. Door fotosynthese nemen bomen weliswaar CO2 op en produceren ze zuurstof. Maar ze nemen net zoveel op als ze uitstoten. Ze gaan pas zuurstof produceren als ze groeien. En dat is in de Amazone niet het geval, het oerwoud wordt kleiner. Echter: de planten die in de plaats van die bomen komen, produceren die zuurstof ook, zei Amazone-onderzoeker Bart Kruijt van de Wageningen University een aantal jaren geleden. 'Zelfs als we alle bossen in de wereld weg zouden halen, hebben we niet ineens geen zuurstof meer'. De massale bosbranden zijn wel schadelijk, want daarbij komen de enorme hoeveelheden CO2 vrij die in de wouden liggen opgeslagen. Die blijven heel lang in de atmosfeer aanwezig en dragen sterk bij aan de opwarming. Het afbranden en verdwijnen van de bossen werkt bodemerosie en verwoestijning in de hand, terwijl unieke dier- en plantensoorten uitsterven en de biodiversiteit sterk afneemt.
Uit nieuw onderzoek blijkt dat het regenwoud in de Amazone de laatste jaren in de greep is van een uitzonderlijke droogte. Er valt weinig regen en temperaturen zijn al een jaar lang hoger dan normaal. De eerdere droogten van 2005 en 2010 die destijds alarmbellen deden afgaan, worden nu ruimschoots overtroffen. Velen denken dat de huidige En Niño een rol speelt in de recorddroogte, maar de onderzoekers rekenden uit met het US Drought Monitoring Classification System (USDM) dat het geen incident is. 'El Niño reduced the amount of precipitation in the region by about the same amount as climate change; however, the strong drying trend was almost entirely due to increased global temperatures, so the severity of the drought currently being experienced is largely driven by climate change.' De droogte brengt een vijftien jaar oude studie in herinnering, schrijft de klimaatredacteur van de NOS. Britse wetenschappers waarschuwden in 2009 in Nature Geoscience voor structurele verdroging van het Amazonegebied als gevolg van de mondiale opwarming, waardoor er op termijn geen regenwoud meer kan groeien. In plaats daarvan zal een savannelandschap ontstaan, met veel lagere biodiversiteit. 'Het Amazonewoud is heel erg belangrijk voor de mondiale biodiversiteit' , zegt hoogleraar ecologie Hans ter Steege van onderzoeksinstituut Naturalis en de Universiteit Utrecht. 'We schatten dat er ongeveer 16.000 boomsoorten voorkomen. Er leven alleen al 140 verschillende soorten primaten, er zijn 1800 soorten vogels bekend en honderden zoogdieren, reptielen en amfibieën. Van kleinere planten zijn er vele tienduizenden en de diversiteit aan insecten is letterlijk ontelbaar. (...) Veel soorten zullen niet meer kunnen overleven op de plaats waar ze nu voorkomen en omdat de verandering erg snel gaat, kunnen ze zich ook niet verplaatsen. Daar komt nog bovenop dat er bij verdroging van het regenwoud ook veel CO2 vrijkomt.'
Over de 'asieltsunami'. De aantallen asielzoekers die alsmaar door zouden stijgen. Maar de realiteit is anders. Vandaag meldt het CBS dat op basis van cijfers van de IND dat vorig jaar het aantal asielzoekers licht steeg, slechts met 8 procent naar 38.000. In 2022 waren het er 35.500. Het aantal nareizigers daalde echter met 7 procent. De meeste asielzoekers kwamen net als in de voorgaande jaren uit Syrië (13.000 aanvragen), gevolgd door Turkije (bijna 2900 aanvragen), Eritrea (ruim 2300) en Jemen (2000). De aantallen mensen die naar ons land vluchten fluctueren al jaren licht, het ene jaar omhoog en het andere omlaag. Zie o.a. hier. 'Nederland wordt één asielzoekerscentrum', roept Wilders al een jaar of tien. Even lang klopt er dus niets van. Het tekort in de opvang komt alleen maar door de onbezonnen afbouw van de capaciteit sinds 2025. Het is een door de centrumrechtse kabinetten onder Rutte zelf gecreërd probleem.
Vanochtend gaat de top van Europese leiders in Brussel toch unaniem akkoord met het steunpakket van 50 miljard euro voor Oekraïne. In een vooroverleg met onder meer de Duitse bondskanselier Olaf Scholz, de Franse president Emmanuel Macron en de Italiaanse premier Giorgia Meloni ging Orbän door de bocht. Plan B - de overige 26 betalen het zelf - hoefde niet uit de kast te komen. Orbán krijgt ook geen veto over de bedragen die de komende vier jaar aan Kyiv worden uitbetaald. Nu de VS nog!
Vannacht trok een regenfront over, vandaag is het een mooie, zonnige dag. Iets warmer dan gisteren; het voelt bijna als lente. Naar het begin van dit kwartaal
Gorinchem (24.033)

Vrijdag 02-02-2024
Dit plaatje komt oorspronkelijk uit een boek (2003) van Vaclav Smil, 'Energy at the Crossroads: Global Perspectives and Uncertainties', (The MIT Press). Het overzicht werd in 2018 geactualiseerd door Yinon M. Bar-On et al. Het toont het totale gewicht van alle soorten op het land levende zoogdieren in de wereld. Daarvan blijkt 67 procent gedomesticeerde huisdieren en dieren die voor voedsel door en voor de mensen worden gekweekt, en 30 procent is het gewicht van alle mensen bij elkaar. De overblijvende 3 procent is voor dieren die in het wild leven. We hebben over de hele wereld de megafauna afgeslacht en brengen een klimaatcrisis teweeg en de zesde golf van massaal uitsterven. Welkom in het Antropoceen!
Een immigratieplafond, gedwongen grenssluitingen, meer detineren, geen extra bescherming voor statusloze migranten die al decennia in het land verkeren, het zijn enorme concessies die president Biden aan de Republikeinen deed. Biden gaat zover omdat het een verkiezingsjaar is en zijn immigratiebeleid wordt door kiezers gewaardeerd op slechts 30 procent. De PVV zou er bij ons content mee zijn geweest, maar tot mijn stomme verbazing torpedeert Donald Trump het akkoord erover met de Republikeinen. ‘Dit is een verschrikkelijk voorstel’, spuwde hij afgelopen woensdag uit, hoewel alle details nog niet eens zijn onthuld. ‘Dit gaat niet gebeuren'. Zo'n akkoord kan hij niet gebruiken in zijn verkiezingsretoriek en de GOP lijkt daarin mee te gaan. Het toont de verwording van de Amerikaanse democratie. 'Een grensdeal die het aantal illegale migranten doet afnemen, zou politiek voordelig zijn voor Joe Biden’, zei een Republikeinse senator. Bizar.
Soms ben ik al die ellende zat. Dan denk ik maar aan iets dat Albert Camus ooit ergens schreef, ik meen in 'De Mythe van Sisyphus' (1942). Daarin stelde hij dat er eigenlijk maar één belangrijk filosofisch probleem bestaat, dat van de zelfmoord. Wie zichzelf niet van kant maakt, accepteert dat het leven en de wereld absurd zijn. Vlucht niet in religie. Sterf of zie het onder ogen. Ja, en probeer er dan maar kalm en stoïcijns bij te blijven. Dat lukt me niet steeds.
Een overwegend grijze dag. Sportschool. Stoïcijns tweemaal door het Biocircuit. Het weekeinde begint. Naar het begin van dit kwartaal
Gorinchem (24.034)

Zaterdag 03-02-2024
De update van de gemiddelde wereldtemperatuur in de troposfeer, sinds 1979 gemeten door satellieten, was over de maand januari 2024 +0,86 graden Celsius boven het gemiddeld niveau over de jaren 1991 - 2020. Ongekend hoog en je ziet dat het al voor de vierde maand op rij het geval is. De lineaire opwarmingstrend steeg nu naar +0,15 graden per tien jaar (+0,13 graden boven de oceanen en +0,20 boven de landmassa's). De afgelopen maand januari was wereldwijd de warmste in de Japanse JRA-55 dataset met 1,56 graden boven pre-industrieel niveau. Dat alles tegen de achtergrond van de opwarmingstrend plus de huidige El Niño.
Zuid-Amerika heeft voor deze tijd van het jaar te maken met uitzonderlijke hittegolven, meldt de NOS. In het zuiden van Chili en Argentinië, in de regio Patagonië, steeg het kwik eind januari naar meer dan 40 graden Celsius. De warme temperaturen hebben zich vervolgens ook naar de noordelijkere regio's verspreid, ook Colombia heeft te maken met hogere temperaturen dan gemiddeld. Verwacht wordt dat de komende dagen ook Paraguay en Brazilië te maken krijgen met de hitte. In Chili zijn er hevige bosbranden in de centrale kustregio's Valparaiso en Viña del Mar. Tien mensen kwamen om het leven, tientallen huizen gingen in vlammen op en duizenden hectares bos gingen verloren.
Gisteravond zag ik Op1. Caroline van der Plas kreeg alle gelegenheid om te foeteren op Exctinction Rebellion dat vandaag weer begint met het bezetten van de de A12 in Den Haag. Boos zei ze: 'Politieagenten worden uit de regio's naar Den Haag gebracht. Demonstranten worden opgepakt maar niet vervolgd. Agenten denken: wat doen we hier?' Precies! Wat doen die agenten daar? Bij een beheerste en vreedzame actie, terwijl elders - ook in Nederland - boeren meerdere snelwegen blokkeren, asfalt in de fik steken en mest op straat spuiten? Dat is geen protest zoals door XR, maar terreur. De politie doet er echter niets aan, ook vanmorgen niet, ze 'faciliteren' het zelfs en Caroline heeft daar 'alle begrip' voor. Bedenk dat de boeren vanaf het begin van de Europese eenwording, dus vanaf de jaren 50 van de vorige eeuw, de meest gesubisieerde sector in Europa is. Nog steeds gaat eenderde van het EU-budget naar de boerensector en dan voor 80 procent naar de grote agrarische bedrijven. De boerenprotesten zijn eerder een goed getimede driftbui van een geprivilegieerde boerenklasse dan de noodkreet van keuterboertjes, schrijft Caroline de Gruyter dit weekeinde in de NRC. Ondertussen mag FDF-voorman Mark van de Oever van Van der Plas openlijk op televisie kamerleden als landbouwminister Adema en Harm Holman (NSC) bedreigen. 'Er worden ook heel harde daden gepleegd richting de boeren. De boosheid is enorm op dit moment.' Veel politici veroordelen dat vandaag, ook Omtzigt (zie hier) en Yesilgöz. De formatie van een rechts-populistische regering staat toch al onder hoogspanning.
Om 13 uur blokkeren enkele honderden demonstranten van XR de A12 even voorbij de tunnelbak in Den Haag. Het gaat er gemoedelijk aan toe. De aanwezige politie begint met de ontruiming, de activisten laten zich wegslepen. Verderop staat een waterkanon klaar. Het is hetzefde scenario als vorig jaar. In oktober werd de reeks blokkades gestopt omdat de Tweede Kamer had ingestemd met het onderzoeken van scenario’s voor de afbouw van fossiele subsidies. Dat overzicht laat nog op zich wachten. Bovendien verwierp de Eerste Kamer in december een wetsvoorstel voor de beëindiging van enkele fossiele subsidies. Rob Jetten wil volgende week voorstellen naar buiten brengen om fossiele subsidies en andere belastingvoordelen af te bouwen.
Het is met bijna 12 graden een warme dag, tweemaal de normale waarde. Nu en dan valt er wat miezerregen. Anna gaat met Tessa op bezoek bij Nikita, die voor de tweede keer zwanger is. Een zusje voor Zaila op komst. Naar het begin van dit kwartaal
Gorinchem (24.035)

Zondag 04-02-2024
Dit is een dwergsterrenstelsel. Dat is geen groep van dwergsterren maar een klein sterrenstelsel. Die stelsels zijn klein en niet goed zichtbaar. Wel zijn ze de meest voorkomende sterrenstelsels in het heelal. Ze bevatten gaswolken, donkere materie en minder dan 100 miljoen sterren, terwijl bijvoorbeeld ons Melkwegstelsel naar schatting 200 tot 400 miljard sterren telt. Die hierboven werd bij toeval ontdekt op opnames van de James Webb ruimtelescoop (zie The Astrophysical Journal Letters, 31 januari 2024). Het werd vastgelegd bij een verkenning van een cluster van sterrenstelsels, die het PEARLS-project heet. Vandaar dat het mini-stelsel de naam PEARLSDG kreeg. Het staat op ongeveer 98 miljoen lichtjaren afstand en is bijzonder. Dwergsterrenstelsels zijn namelijk meestal satellieten van grote stelsels en ze zijn actief, ze vormen nieuwe sterren, maar deze is alleen in de ruimte. PEARLSDG behoort tot de ‘eenzame, rustige sterrenstelsels’ – een klasse van zeer zeldzame dwergstelsels. Mooi, zo'n eenzame wereld van sterren. Maar misschien zijn die toch niet zó zeldzaam.
Een grijze zondagochtend met miezerregen. De eerste wandelaars lopen langs, de eerste joggers snellen over de sluis. We zijn ongeveer halverwege de winter en het wordt weer een graad of elf, twaalf. Op Radio4 het programma 'Tussen hemel en aarde' van KRO/NCRV met doorgaans mooie, religieuze muziek, vaak Gregoriaans. Vaste prik op zondagochtend, nu met een ingetogen 'Gloria' van Ockeghem. Samen ontbijten, één eitje voor Anna, twee voor mij. Later gaat ze naar Vajèn kijken die twee wedstrijden zaalhockey moet spelen. Eén wordt gewonnen, éém verloren. Verder een rustige zondag. Naar het begin van dit kwartaal
Gorinchem (24.036)

Maandag 05-02-2024
Van het universum weten we vooral wat we niet weten. Slechts 4,9 procent bestaat uit gewone materie; van 95 procent is totaal niet bekend wat het is. Het onbekende 'spul' is verdeeld tussen vooral donkere energie (68,3 procent) en donkere materie (26,8 procent). 'Donker' is een benaming uit verlegenheid. Die onbevredigende situatie bestaat al decennia. Natuurlijk wordt nog altijd intensief naar oplossingen gezocht, onder meer in de snaartheorie. Soms verschijnen nieuwe theoretische concepten, zoals twee jaar geleden het scenario van een donkere dimensie dat twee aspecten heeft: een verklaring voor donkere materie en een nauwe verbinding tussen donkere materie en donkere energie. Dat komt me niet zo vreemd voor. Binnen de meest bekende versie van de snaartheorie, de zogenaamde M-theorie, bestaan zelfs 11 dimensies. Behalve de vier die wij kennen (3 ruimtelijke en 1 voor de tijd) zouden er nog 7 zijn die we niet kunnen 'ervaren' omdat ze als het ware opgerold zitten op zo'n klein formaat - om en nabij de Plancklengte - dat zelfs de deeltjesversneller van CERN in Zwitserland ze bij lange na niet kan laten 'zien'. Van die niet waarneembare extra dimensies zouden er 6 ruimtelijk zijn plus nog een extra dimensie voor de tijd.
Bij die extra dimensies zou er eentje significant groter zijn de andere, met een doorsnede van 1 micron in plaats van een honderd miljoen biljoen zo klein als een proton. Eén micron is een duizendste van een millimeter; ten opzichte van de andere zes opgerolde dimensies is dat gigantisch. Het nieuwe scenario stelt dat de deeltjes die de zwaartekracht belichamen in de nieuwe, donkere micron-dimensie worden gegenereerd. Zij zouden samen de donkere materie vormen en samenhang in de kosmos brengen. Ze 'lijmen' als het ware alle gewone en donkere materie aan elkaar. De naam van zo'n deeltje is het graviton, een deeltje zonder massa dat de snelheid van het licht heeft. Het werd bijna een eeuw geleden bedacht maar nooit gevonden. Er is ook geen enkele aanwijzing dat die donkere dimensie bestaat, maar volgens de opstellers zou het nieuwe scenario wel getest kunnen worden.
Men veronderstelt dat bij de deeltjesbotsingen meteen na de oerknal niet alleen de gangbare gravitons ontstonden, maar meerdere soorten andere gravitons waarvan er sommige wel een massa hebben. Donkere gravitons met een massa, zó klein dat ze in de extra donkere dimensie van micronformaat passen. Daarin vliegen ze rond als een quantumgolf. Ze zijn klein genoeg om uit de microngrote donkere dimensie 'weg te lekken' naar de 4 grote dimensies van onze 'gewone' ruimtetijd. Hun geringe energie/massa wordt in die enorme groottes nog veel meer 'verdund', maar toch hebben ze een gravitationele invloed en veroorzaken - de donkere energie. Het zou in elk geval verklaren waarom de zwaartekracht zoveel zwakker is dan de andere drie natuurkrachten: de electromagnetische kracht en de sterke en de zwakke kernkrachten.
Tja. Maar hoe moet men dit scenario testen? Enerzijds met metingen aan hele jonge sterrenstelsels, die juist beginnen met samentrekken en clustering uit een accretieschijf. De donkere gravitons zijn veel lichter dan de gewone materiedeeltjes en kunnen in het begin nog aan die clustering ontsnappen. Zo'n pril stelsel zou daardoor minder massa moeten hebben dan de kosmologische modellen becijferen. Dat verschil zou gemeten kunnen worden met behulp van de Euclid ruimtetelescoop, die afgelopen zomer gelanceerd werd. Hm. (Als ik het goed snap). Men zoekt anderzijds ook naar testen die in het laboratorium kunnen worden gedaan. Men zou afwijkingen kunnen vinden in de zwaartekracht tussen materie op afstanden van één micron of minder. Dat is nog niet gelukt. (met dank aan dit artikel in Quantamagazine).
Een vrijwel permanent bewolkte dag. Anna gaat in de buurt op bezoek bij een vriendin. Om twaalf uur loeien de alarmsirene's in de stad. Even later geven ze het alles-veilig-signaal. Oorlog is nog steeds op afstand. Naar het begin van dit kwartaal
Gorinchem (24.037)

Dinsdag 06-02-2024
Afgelopen weekeinde troffen twee 'atmosferische rivieren' achter elkaar de Amerikaanse staat Californië. Atmosferische rivieren (AR) zijn stromen van met vocht verzadigde lucht, afkomstig uit de evenaarszone (in dit geval Hawaï) die circuleren op een hoogte van ongeveer 1 tot 2,5 kilometer, 400 tot 600 kilometer breed kunnen zijn en tot enkele duizenden kilometers lang. schrijft Buienradar. Dergelijke stromingen komen aan de westkust van de VS elk jaar meermaals voor, en brengen doorgaans drie tot vijf dagen hevige regen of sneeuw met zich mee. In Los Angeles viel eergisteren 10,4 centimeter regen. Daarmee is een oud record van 6,5 centimeter uit 1927 gebroken. Straten in onder meer Los Angeles zijn ondergelopen en automobilisten zijn gestrand. Snelwegen zijn overstroomd of zijn onbegaanbaar door modderstromen. Bomen zijn omgewaaid. Honderdduizenden huishoudens zitten zonder stroom doordat elektriciteitsleidingen zijn geknapt.
Het vervelende van die atmosferische rivieren is dat ze lang kunnen blijven hangen. De hoeveelheid regen is excessief. CNN bericht dat tot heden al driekwart van de jaarlijkse hoeveelheid neerslag in Los Angeles viel. De zender spreekt van 'a firehose of rain', de ergste regenval in 140 jaar. Grote gebieden zijn overstroomd of bedekt met modder. Er vielen tot dusver drie doden.
Atmosferische rivieren zijn letterlijk rivieren van geconcentreerde waterdamp. Om even te vergelijken: deze rivieren transporteren gebruikelijk meer dan 10 keer de hoeveelheid water (in de vorm van waterdamp) dan de Rijn. Het Amerikaanse 'The Weather Channel' legt uit dat de intensiviteit van en de schade door atmosferische rivieren toeneemt. Als gevolg van de opwarming van het klimaat kan de atmosfeer steeds meer vocht bevatten, de zeespiegels stijgen en in dit jaar komt de extra invloed van de huidige El Niño er nog bij.
Hoe bizar de wereld is. Afgelopen zaterdag werden een paar duizend keurige demonstranten van XR bij de tunnelbak van de A12 door de politie opgepakt. Ze verzetten zich niet, ze staken het asfalt niet in brand en stortten geen mest op de weg. Gisteravond en vanmorgen deden de trekkerboeren dat wel op veel snelwegen in het land. Ze dumpten niet alleen mest maar ook puin en staken hooibalen, hout, plastic, banden en asbest in brand. Hier vlakbij Gorcum op de A15 botsten twee auto's op elkaar, vanwege dikke rook die over de snelweg trok. De slachtoffers zijn met onbekend letsel naar het ziekenhuis gebracht. Ook bij Veenendaal raakten twee jongens van 17 op een brommobiel gewond door boerenacties. De politie greep nauwelijks in en ruimde na afloop zelfs de rotzooi op.
In veel Europese landen protesteerden boeren met tractoren tegen Europese regels en de Europese Green Deal, die Europa in 2050 klimaatneutraal moet maken. Vandaag komt de Europese Unie bijeen om te praten over die regels, maar het eerste succes hebben de boeren al binnen: Ursula von der Leyen haalt het voorstel tot halvering van het pesticidenverbruik in de landbouw van tafel. 'Om de boeren tegemoet te komen', zegt de NRC. Vorige week besloot ze al de verplichte braaklegging van landbouwgrond te versoepelen. Beter het volk vergiftigd, het land overstroomd en de natuur verpest dan je zetel als commissievoorzitter verliezen. Deze gang van zaken tekent onze situatie. In een flits denk ik:
Conclusie 1: deze wereld gaat zichzelf niet redden.
Conclusie 2: als de wal het schip keert is het te laat.
Misschien volgt de lezer dit niet, maar ik heb het al zo vaak gedacht.
Gisteravond onze VVE-vergadering voorgezeten. Dat verliep goed. Onderwerpen: onderhoud van het pand en het maken van een uitgebreider huishoudelijk reglement. Bijvoorbeeld over de vraag of een bewoner zomaar een AirBnb of een Bed & Breakfast zou mogen beginnen. Goeie vraag. Niemand wil het op dit moment, maar je moet er wel over nadenken. Het is vandaag een grijze dag met flink wat wind. Anna gaat op Zaila passen. Vanaf vanavond zal het veel en lang gaan regenen, Naar het begin vn dit kwartaal
Gorinchem (24.038)

Woensdag 07-02-2024
Gisteravond zijn de talkshows gevuld met reacties op Pieter Omtzigt die uit de informatie is gestapt, althans uit de huidige fase met PVV, BBB en VVD. Vooral Humberto brengt veel inzicht want daar zit de NSC-leider zelf. Hij wordt bij de uitleg van zijn stap knap gehinderd omdat de 'duiders' aan tafel hem niet laten uitpraten, maar ik krijg het beeld dat Omtzigt het proces enorm zat was. Vooral vanwege Geert Wilders. De ergernis straalt van zijn gezicht. Zeker ook bij het vertellen dat informateur Plasterk belangrijke stukken over nieuwe financiële tegenvallers ruim een week onder zich hield. (Plasterk ontkent dat). Daarin zag Pieter een nooduitgang, de kans om eruit te stappen. Er is 2,5 maand verspild, de kabinetsformatie kan nu opnieuw beginnen. Daar kunnen ook andere partijen aan meedoen, wat Omtzigt betreft. Hij heeft nog steeds voorkeur voor een minderheidskabinet. Ik ben zelf niet zo geporteerd van die NSC, maar in elk geval kun je aan zijn interventie zien hoezeer Omtzigt als politicus een klasse beter is dan de andere drie partijleiders.
Wat nu? In de Kamer zijn niet voldoende andere partijen bereid om Wilders aan een meerderheid te helpen. De Volkskrant zet vanmorgen vijf opties die nu voorliggen op een rij:
1. Een rechts minderheidskabinet. 'De vraag is vooral of PVV, VVD en BBB het aandurven.'
2. Een extraparlementair kabinet. 'Bij andere partijen overheerst de scepsis, omdat Nederland er geen enkele ervaring mee heeft. Het zou een groot politiek experiment worden.'
3. Een middenkabinet van VVD, NSC, D66 en GroenLinks-PvdA. Samen 78 zetels in de Tweede Kamer. 'Nu toch weer aan zo'n avontuur beginnen, zou voor de VVD de hele strategie van het afgelopen jaar in één keer tot een mislukking maken. De kans dat Yesilgöz daaraan begint, is dus bijzonder klein'.
4. Een doorstart van de afgebroken gesprekken. Op wat langer termijn niet uitgesloten, waarschijnlijk niet meer met Plasterk.
5. Nieuwe verkiezingen ziet vrijwel niemand voorlopig zitten, behalve Wilders. Hij noemt Omtzigt nu 'een wegloper' - 'Omtzigt heeft het hazenpad gekozen' - en zou mogelijk nog meer zetels winnen.
Conclusie: een nieuwe regering zit er voorlopig nog niet in.
De Volkskrant heeft vanmorgen ook een interview met de schrijver António Scurati, auteur van een succesvolle romancyclus over de opkomst van Mussolini. In een ander boek, 'Fascisme en populisme' (Podium, 2024) stelt Scurati dat Mussolini niet alleen de aartsvader was van het fascisme, maar ook van het populisme. Scurati maakt zich zorgen over Nederland. Antiparlementarisme is in zijn ogen een van de fundamentele kenmerken van het populisme. Denk aan Wilders over 'het nepparlement'. 'Vooralsnog is er bij jullie een situatie waarbij 75 procent van de Nederlanders niet op Wilders heeft gestemd. Dat is de echte meerderheid en die meerderheid wil waarschijnlijk geen regering met daarin sterke antirechtsstatelijke elementen. Het argument dat het ondemocratisch is de verkiezingswinnaar niet te laten regeren, is een volslagen onzinnig argument, vooral bedoeld om zo snel mogelijk de macht te grijpen. (...) Dankzij jullie sterke democratische en libertaire tradities vertegenwoordigen jullie de top van de Europese beschaving. Dus dat er juist uit Nederland nu een walm opstijgt van isolationisme en anti-Europees sentiment, maakt mij oprecht verdrietig.'
Achter alle talkshows (en Arjen Lubach) aan kijk ik tot laat naar de documentaire 'A Compenssionate Spy' over de Amerikaanse natuurkundige Ted Hall die in 1944 geheimen over de bouw van de atoombom in het Manhattan Project doorgaf aan de Russen. Een fascinerende film. De VS bezat toen als enige het nucleaire wapen en Hall vreesde dat Washington misbruik zou maken van zijn monopolie. President Truman liet in die tijd uitrekenen hoeveel kernbommen op de Sovjet-Unie gegooid moesten worden om ervoor te zorgen dat die geen bedreiiging meer kon zijn. Ted Hall overleed in 1999 en komt in de film, die vooral leunt op intensieve gesprekken met zijn vrouw, over als een teruggetrokken, verlegen en wat naïeve man. Anders dan Julius & Ethel Rosenberg (die onschuldig op de electrische stoel belandden) en de spion Klaus Fuchs, werd hij nooit veroordeeld hoewel de FBI hem jaren vervolgde. Was hij een held? Dat lijkt me wel, maar de meningen verschillen nog steeds. Veel van de wetenschappers in het Manhattan Project twijfelden sterk over het maken van een wapen dat de hele beschaving kon vernietigen. Ze deden het vooral, net als Hall, om Nazi-Duitsland voor te zijn.
Het is een dag die allengs zonniger wordt. Even de stad in voor een boodschap en een middaglang lezen. Naar het begin van dit kwartaal
Gorinchem (24.039)

Donderdag 08-02-2024
Het jaar 2024 is meteen in januari begonnen met wereldwijd record-oppervlaktetemperaturen. Dat afgelopen januari de warmste was sinds het begin van de metingen, wisten we inmiddels. De maand was gemiddeld met 1,65 graden Celsius boven het pre-industrieel gemiddelde en ruim boven de 1,5 gradengrens van de Parijse Akkoorden. De laatste dag van de maand was met +1,93 graden de heetste.
Gisteren en vandaag kristalliseert het beeld over de stilgelegde kabinetsinformatie zich uit. Omtzigt is het zat om verder te gaan met de drie onbetrouwbare malloten van PVV, BBB en VVD. Verdergaan met een partijleider die openlijk een onbetrouwbare ultra is, met eentje die aan 'dyscalculie' zou lijden en eentje die alleen maar op rechts wil scoren, is niet te verdragen. En dat ook nog onder leiding van een informateur die een baantje als premier boven de partijen poogt veilig te stelllen. Dat begrijp ik volledig van de precieze cijferaar, die alle kansen op een Nieuw Bestuur zag verdampen. Wat moet hij zich in dat gezelschap ellendig en geïrriteerd gevoeld hebben! Toen de drie vlak voor de deadline zonder de imformateur bijeen kwamen om de komst van een nieuw ultrarechtse kabinet vast te nagelen, moest hij wel breken. Laat en hij deed het onhandig en warrig.
De vraag blijft hoe ver de NSC-leider al het populistische pad op was gegaan. Over grondwet en rechtstaat zou al overeenstemming bereikt zijn. Dat moet blijken uit het verslag dat Plasterk nu moet maken. Dat het land zozeer in financiële nood zou zijn, komt me vreemd voor. De inflatie is dalende, de staatsschuld is laag, de lonen stijgen en de recessie is miniem; alleen op langere termijn (2028) moet er structureel 17 miljard bezuinigd worden. Niks om over in paniek te raken, maar we weten natuurlijk niet hoeveel 'gratis bier' de andere drie wilden weggeven.
In de NRC denken Philip de Witt Wijnen en Pim van den Dool dat zijn vertrek een slimme zet van Omtzigt is. 'Playing hard to get is een beproefde onderhandelingstactiek. Je hoopt of verwacht dat de gesprekspartners je zó hard nodig hebben dat ze grotere concessies zullen doen om je weer terug aan tafel te krijgen'. Inderdaad doen de drie momenteel niks anders dan Pieter terug aan tafel vragen. Voor een terugkeer kun je eisen stellen, maar succes van zo'n gok is niet gegarandeerd.
Eveneens in de NRC denkt politicoloog Menno Hurenkamp dat er niet persé een centrumrechts kabinet gevormd moet worden. Als de middenpartijen zouden gaan regeren kun je toch ook de uitslag van de verkiezingen van 22 november serieus nemen? Verantwoordelijkheid nemen voor klimaat, stikstof, vergrijzing, arbeidsmarkt en volkshuisvesting. De fossiele subsidies verminderen, de veestapel halveren, pesticiden aanpakken, glastuinbouw afbouwen, distibutiecentra sluiten, al die zaken die ons land meer kosten dan opbrengen. Flink doorpakken in de multipele crises op moeilijke dossiers. Liever beleid dan retoriek. '...er zijn meer kiezers om serieus te nemen. Het gaat om meer dan tweederde van de kiezers die anders denken dan de PVV, of althans dan de PVV-leider. Al die kiezers hebben ook het recht om gehoord te worden, om daadwerkelijk geholpen te worden om een huis, baan of stageplek te vinden, of te weten waar ze hun mest dan wél mogen storten als het niet op de snelweg is'.
Een dag van eindeloze regen. Toch moet Anna erdoor om weer op Zaila te passen. Naar het begin van dit kwartaal
Gorinchem (24.040)

Vrijdag 09-02-2024
Carnaval in het zuiden. Terwijl het volk gaat feesten en politici in Haagse verwarring verkeren, is het na de warmste januari ooit gemeten nu voor de achtste maand op rij dat warmterecords wereldwijd worden gebroken. Het is bovendien voor het eerst dat de vaak genoemde 1,5 graad opwarming uit het klimaatakkoord van Parijs een heel jaar op rij wordt gepasseerd. Uit gegevens van de Europese klimaatdienst Copernicus valt op te maken dat het nu twaalf maanden op rij meer dan 1,5 graad warmer is dan in de pre-industriële tijd. Een heel jaar! Ook de gemiddelde zeewatertemperatuur is wereldwijd belachelijk veel hoger. Dat is opmerkelijk omdat zeewater traag opwarmt. Momenteel is het wateroppervlak over de hele wereld iets warmer dan de recordtemperaturen van augustus vorig jaar - maar het is februari. Zie hierboven. Ik kan het niet helpen dat het hier zo vaak over weerrecords moet gaan. We zijn op een hellend vlak. We kunnen de 1,5 graden opwarming bij de eeuwwisseling niet meer vermijden.
Persbureau Reuters meldt dat een meteoroloog van de Amerikaanse overheid voorspelt met 55 procent kans dat de huidige El Niño de komende maanden zal afnemen en dat een nieuwe La Niña in de tweede helft van dit jaar zal beginnen. De eerste geeft momenteel een boost aan de wereldtemperaturen, zijn opvolgster dempt wat meer. Dat patroon van afwisseling in de Stille Oceaan heet ENSO, de El Niño-Southern Oscillation. Een krachtige El Niño zoals de huidige wordt vaak snel gevolgd door een La Niña, zegt het Climate Prediction Centre van de NOAA. Het is een fluctuerend ritme op de doorgaande trend van opwarming. Zo kunnen we in 2024 weer onder de +1,5 graden komen - voor even.
Ik lees dat Van Agt is overleden. De Volkskrant karakteriseert hem raak in een kleurrijke necrologie als 'een ongrijpbare paradijsvogel'en 'een charmante pestkop met onnavolbare humor'. Wat had ik vroeger een hekel aan die man! Later werd hij allengs linkser en een fel strijder voor de Palestijnse zaak. Dries van Agt overleed 'hand in hand' met zijn vrouw Eugenie; beiden werden 93 jaar. Het herinnert me aan de samen gekozen van dood van André Gorz en Dorine Keir in 2007. Ze komen voor in deel 3 van mijn romancyclus.
Kernfusie wordt vaak aangemerkt als de definitieve oplossing voor al onze energieproblemen. En zonder gevaarlijk kernafval. Maar de realisatie ervan ligt nog decennia van ons af. Gistermiddag - lees ik in de NRC - werd bekendgemaakt dat het Europese fusie-experiment Joint European Torus (JET) begin oktober in 5,2 seconden 69,26 megajoule aan warmte-energie heeft geproduceerd. Dat is vergelijkbaar met het elektrische energieverbruik van een driepersoonshuishouden in twee dagen. Daarmee is het vorige record – in 2022 ook door de JET – verbroken met 10 megajoule. De reactor gebruikte hiervoor slechts 0,21 milligram brandstof, het gewicht van een fruitvliegje. Het gebeurde vlak voordat de reactor definitief werd stilgelegd. Hij zal worden opgevolgd door de veel grotere ITER, waar sinds 2013 in het zuiden van Frankrijk aan gebouwd wordt.
Na een grijs begin is vandaag een enkele keer weer wat zon. En het is zacht: 13 graden. Terwijl Anna boodschappen gaat doen bij de Plus ben ik op de sportschool. Een uur later haalt ze me weer op. Naar het begin van dit kwartaal
Gorinchem (24.041)

Zaterdag 10-02-2024
Hoe een zwart gat eruit ziet? Dat ligt eraan van welke kant je ertegenaan kijkt, blijkt uit nieuwe gegevens van NASA’s röntgen-ruimtetelescoop Chandra en de Very Large Array (VLA)-radiotelescoop in de VS. En van hoe snel het zwarte gat ronddraait. Hoe sneller het gat spint, hoe meer het de ruimtetijd en materie in de buurt meesleept en uit elkaar trekt. De onderzoekers bekeken het gulzige superzware gat Sagittarius A* in het centrum van onze Melkweg. Ze hanteerden een nieuwe methode, gebaseerd op de manier waarop materiaal naar het zwarte gat toe en daar deels weer vandaan geslingerd wordt. Daardoor wordt de ruimtetijd als het ware steeds platter gedrukt, zodanig dat het zwarte gat van opzij gezien steeds meer op een rugbybal lijkt. Hoe sneller het gat spint, hoe platter de bal. Van bovenaf blijft het gat er rond uitzien. Je ziet dat op de dwarsdoorsnede hierboven, dus van opzij, het gat zelf (zwart) nog steeds rond is. Het eromheen tollende gas en stof ziet er geel en wit uit. Het witgekleurde deel is het dichtst bij het gat en de binnenste rand ervan wordt platgedrukt. Dat is in de tekening zichtbaar gemaakt door het iets donkerder geel te maken. Het zwarte gat slokt de materie in zijn omgeving op, maar aan de boven- en onderkant spuwt het snelle jets van materiaal weg. Dat kost energie en dat doet het gat steeds een beetje langzamer draaien. Over onafzienbare miljarden jaren zal het tenslotte stilvallen en verdwijnen.
Vandaag een aardige dag, droog en met soms een bleek zonnetje. En opnieuw een graad of 13. Anna bakt een rabarbertaart. Ik heb hem juist geproefd: verrukkelijk! Om kwart over twee komt over het Eind het Gorcums carnavalsoptochtje langs. Duurt vijf minuten. Naar het begin van dit kwartaal
Gorinchem (24.042)

Zondag 11-02-2024
Al tientallen jaren maken meteorologen zich zorgen over het mogelijke vertragen van de AMOC, de Atlantic Merionodal Overturning Circulation, een oceaancirculatie waar de warme golfstroom deel van uitmaakt. Dankzij de AMOC hebben we in West-Europa een gematigd klimaat. Sinds die tijd wordt het steeds duidelijker dat de AMOC vertraagt; ik schreef er vaak over, voor het eerst hier in 2007 toen we voor de winter in het Portugese Lagos lagen. Verzwakking van de AMOC kan een kantelpunt passeren met catastrofale gevolgen voor het klimaat. Sommige klimaatwetenschappers vrezen dat dat inmiddels gebeurd is. RealClimate schreef afgelopen augustus er een overzichtsartikel over. Nu is er een nieuwe studie over verschenen van onderzoekers van de Universiteit van Utrecht. Lees ook de discussie over het onderzoek door oceanograaf Stefan Rahmstorf. Ze gebruikten het recente, zeer geavanceerde klimaatmodel CESM en lieten het een halfjaar draaien op de Snellius, de grootste supercomputer van Nederland. Het is de eerste systematische poging om een kantelpunt te vinden voor de AMOC met een gekoppeld oceaan/atmosfeer-model met een hele hoge resolutie.
Het nieuwe onderzoek bevestigt dat de AMOC bij voortgaande verzwakking een kantelpunt krijgt wanneer het water van de noordelijke Atlantische Oceaan verdund word door toenemende regenval en grotere aanvoer van rivieren en van smeltwater van het zeeijs in de arctische regio. Ook bevestigt de simulatie het feit dat de gangbare klimaatmodellen systematisch de stabiliteit van de AMOC overschatten. De nieuwe runs van CESM '..show how particularly northern Europe from Britain to Scandinavia would suffer devastating impacts, such as a cooling of winter temperatures by between 10 °C and 30 °C occurring within a century, leading to a completely different climate within a decade or two, in line with paleoclimatic evidence about abrupt ocean circulation changes.'
Op het plaatje hierboven, afkomstig uit het artikel van de Utrechters, zie je wat het betekent ten opzichte van de gemiddelde temperaturen over de periode 1750 - 1850. Heel veel kouder bij ons dan toen. NB: het plaatje geeft de uitkomsten van het CESM-model weer, niet de gemeten werkelijkheid!
Een drastisch kouder klimaat binnen enkele decennia in West-Europa als gevolg van het inzakken van de warme golfstroom, dat is nogal een voorspelling! De bekende populistische malloten en klimaatwappies zullen wel juichen: geen opwarming en eindelijk weer Elfstedentochten in Nederland! Ze bedenken niet dat een flink kouder klimaat grote gevolgen krijgt voor plantengroei, landbouw, energiegebruik en economie, terwijl de zeespiegelstijging bij ons en de opwarming elders in de wereld gewoon doorgaan. Tja, je kunt tegenwerpen dat het in de nieuwe studie slechts om een model gaat. Een model kan het mis hebben. Het probleem is uiteraard dat wanneer we het kantelpunt van de AMOC passeren en als we de gevolgen merken het te laat is om ze nog tegen te houden.
Hoelang de opwarming in West-Europa nog zal doorgaan? Geen idee. Voorlopig wordt het bij ons nog steeds warmer. Uit nieuw gepubliceerde onderzoeken in Nature Today, een site voor natuurnieuws, blijkt dat het begin van de bloeiperiode gemiddeld zelfs een maand eerder valt dan vijftig jaar geleden. Mensen met hooikoorts hebben er veel last van. In de periode van 1940 tot 1959 was het in januari en februari gemiddeld 2,1 graden. Nu is de gemiddelde temperatuur in die maanden al 5,4 graden.
De Volkskrant heeft een artikel over mensen in de Randstad die hun huis verkopen om te verhuizen naar hoger gelegen gebieden. De Veluwe of Overijssel. Buren lachten ze uit. Het zijn uiteraard jonge mensen, die nog zeker vijftig jaar te leven hebben. Ze hebben gelijk, maar op de Veluwe heb je dan weer bosbranden. Enfin wij doen het niet; we kunnen onze tijd hier wel uitdienen. Overigens staat ons pand naast de sluis op dijkhoogte, maar of dat voor de komende tijd voldoende hoog is?
Terwijl overal ter wereld leiders, landen en organisaties hem waarschuwen om de grensstad Rafah niet aan te vallen, zal Netanyahu dat hoe dan ook toch doen, zei hij in een interview met de Amerikaanse zender ABC News. Op de vraag waar de circa 1,4 miljoen mensen die in de stad aan de Egyptische grens opeengepakt zitten naartoe moeten, antwoordt Netanyahu dat zij naar de gebieden ten noorden Rafah kunnen, waar het Israëlische leger Hamas heeft verdreven. Hoe dat moet wil hij niet zeggen, 'We werken nu aan een gedetailleerd plan'. In de grensstad zit zo'n anderhalf miljoen gevluchte Gazanen op een kluitje bij elkaar en ten noorden van de stad is alleen maar verwoesting. Israël zal 8 decennia na de Holocaust een enorme catastrofe teweeg gaan brengen.
Het is vandaag droog en opnieuw meer dan 10 graden. Toeristen van een cruiseschip lopen langs in een rondleiding. Op de website van de staatsloterij blijkt dat we deze maand weer niks hebben gewonnen. Dat ware welkom geweest bij onze tegenvaller van het rotte dek van de boot. Nog niks van de verzekering gehoord. Naar het begin van dit kwartaal
Gorinchem (24.043)

Maandag 12-02-2024
Heeft de aarde als enige plek in het universum leven? Of is het heelal 'teeming with life', zoals velen denken? Het is een raar idee dat heel die gigantische kosmos op maar één rotsplaneetje in een uithoek leven kon voortbrengen gedurende de enorme zee van tijd sinds de oerknal. Wat zou onze aarde zó uitzonderlijk en speciaal maken, terwijl steeds meer plaatsen worden gevonden met vergelijkbare omstandigheden op exoplaneten? Zelfs in ons eigen zonnestelsel? Dat zou kunnen op de ijsmanen van de grote gasplaneten Jupiter, Saturnus, Uranus en Neptunus, manen waar onder een dikke, granietharde ijskorst zich enorme oceanen bevinden. Water is onontbeerlijk voor leven. Nieuw onderzoek onder leiding van Valéry Lainey van de sterrenwacht van Parijs wijst uit dat zelfs op het Saturnusmaantje Mimas een oceaan met vloeibaar water schuilgaat. Met een diameter van slechts ongeveer vierhonderd kilometer leek Mimas niet de meest voor de hand liggende plek om naar een oceaan te zoeken, schrijft EE op Astronieuws.
Het meest opvallende kenmerk van Mimas is een grote inslagkrater met een doorsnede van 130 km, genaamd Herschel, naar de man die het maantje in 1789 ontdekte. Herschel beslaat bijna 1/3 deel van de diameter van de gehele maan. Uit computersimulaties met baanafwijkingen en getijdenwerking blijkt dat de vermoedelijke oceaan op een diepte van twintig tot dertig kilometer onder de ijskorst van Mimas ligt. Ook blijkt eruit dat de oceaan pas vijf tot vijftien miljoen jaar geleden zou zijn ontstaan. Daarom zou er nog niets van de oceaan op de rotskorst erboven te zien zijn, zoals geijsers. Het bestaan ervan doet vermoeden dat er ook onder het oppervlak van andere kleine, ogenschijnlijk inactieve manen een oceaan kan schuilgaan. Legio mogelijjkheden voor het ontstaan en onderhouden van buitenaards leven. Wordt het raadsel van alles groter of kleiner als we het vinden?
Een aardige dag, wolken en zon en een graad of tien. Anna past weer op Zaila. Onze schadeclaim voor het dek van de boot ligt nu twee weken bij de verzekeraar. Naar het begin van dit kwartaal
Gorinchem (24.044)

Dinsdag 13-02-2024
Verveling ken ik niet en daar ben ik dankbaar voor. Vandaag zet ik eens op een rijtje waar ik eigenlijk mijn dagen aan besteed. Ik wil ook weten of het eigenlijk moeilijker gaat dan vroeger. Dat komt omdat ik nu dezelfde leeftijd heb als mijn moeder toen ze begon te dementeren - vasculaire dementie - en overal briefjes neerlegde om zaken die ze moest doen niet te vergeten. Die aandoenlijke papiertjes vonden we overal toen mijn broer en ik haar huis opruimden. Zoveel van dat soort notities maak ik (nog) niet, hoewel ik ook wel eens een lijstje voor mezelf maak van dingen die ik moet doen, maar dat komt me niet vreemd voor, ik deed dat vroeger al toen ik nog werkte, schreef to-do-lijstjes in mijn agenda's. Toch merk ik dat het moeizamer gaat, multitasken, de zaken gecoördineerd houden en uitvoeren. Soms zie ik er tegenop, maar niet meer dan vroeger. Wat doe ik op een gewone dag eigenlijk allemaal?
1. Het weblog slokt de meeste tijd op. Vaak ben ik er de hele ochtend mee bezig. Onderwerpen bedenken, de kranten lezen, feiten en achtergronden uitzoeken, een mening vormen. Dat gaat nog altijd zonder al teveel problemen. Soms wordt de post te lang, dan breek ik hem in tweeën en heb ik de volgende dag een makkie. Een enkele keer weet ik niks te verzinnen, dan begin ik gewoon wat te typen en dat levert niet zelden verrassingen op. Verder werk ik af en toe aan het oppoetsen van de oude jaargangen van het blog (lettergrootte, grotere afbeeldingen (zie foto hierboven) en foutencorrectie).
2. De middag is voor lezen, na het middagdutje. Dat kost inderdaad meer moeite: als het gaat over moeilijke wetenschappelijke of maatschappelijke ontwikkelingen en ik lees steeds minder literatuur. Fictie, dus. De werkelijkheid is me al boeiend genoeg. Bij fictie vind ik moeilijker om namen en intriges te onthouden. Dat merk ik nu bij het lezen van de dikke The-Three-Body-Problem trilogie van Cixin Liu. Ik ben nu tegen het eind van deel 2. Al die verwikkelingen en namen, veelal Chinese! Wie is (naam) ook weer? Ik heb dat overigens ook bij series op Netflix, zoals Breaking Bad die we net helemaal gezien hebben. Dan is een film die je in één keer uitziet gemakkelijker.
3. Aan het eind van de middag en na Nieuwsuur en de talkshows ben ik tegenwoordig weer aan het gamen. Het actie-adventuregame Elden Ring in dit geval, een prachtige en schier eindeloze wereld van raadsels, strategische keuzes en ontdekkingen. Maar ook lastig en soms frustrerend. Ik ben er urenlang zoet mee.
4. Met enige regelmaat vraagt de Poëzieroute tijd en inzet: vergaderingen voorbereiden en voorzitten, klussen doen zoals het bijhouden van de website, overleg voeren met derden over geld en lokaties, publiciteit, nieuwe bestuursleden zoeken, de staat van de gedichten op de route controleren en een enkele rondleiding doen. Tegenwoordig ben ik het enige bestuurslid dat in Gorcum woont. Gelukkig doet Joop H. de financiën.
5. Wat overblijft: regelzaken zoals onze financiën en verzekeringen, in maart de belastingaangifte, de vele zaken rond de boot, de sportschool, klusjes in huis enz.
Niet echt weinig, als je het overziet. Het is allemaal mogelijk omdat Anna de verantwoordelijkheid neemt voor het bestieren van het huishouden. Daar ben ik haar enorm dankbaar voor.
Er komt geen meerderheidskabinet op rechts, hoe graag Wilders het ook zegt te willen. Omtzigt wil onder voorwaarden alleen gedogen. Dat was al een dikke maand geleden duidelijk, maar Plasterk ging desondanks door. Tijd verknoeid, ik heb er geen woorden voor. Het onvermogen van de populisten inclusief Yesilgöz laat pijnlijk zien dat het om een beduidend minder garnituur politici gaat. Ze ontberen karakter, invoelingsvermogen, wijsheid en souplesse. Rechts is door versplintering een politieke grabbelton geworden, schrijft Tom-Jan Meeus vanmorgen in de NRC. 'Tactisch voor een deel verslaafd aan onoplosbare problemen. Inhoudelijk van alles wat. En van veel weinig. Weinig democratisch benul. Weinig politiek geweten. Weinig ervaring. Weinig consistentie'. Het debat morgen in de Tweede Kamer is cruciaal.
Weer een aardige dag. Een graad of tien in de middag. We gaan naar de sportschool. 's Middags een tijd bezig met het vergaren en verzenden van agenda en stukken voor de bestuursvergadering van de Poëzieroute aanstaande vrijdagmiddag. Naar het begin van dit kwartaal
Gorinchem (24.045)

Woensdag 14-02-2024
Buiten hangt klamme miezerregen over de haven. Natuurlijk zit ik vanaf 10.15 uur voor het scherm te kijken naar de live-uitzending van het kamerdebat over het rapport van Plasterk. Willders begint en krijgt veel interrupties van de niet-betrokken partijen. Wilders is goed op dreef, moet ik zeggen, maar even na half twaalf trekt hij met het voorstel van Kim Putters als nieuwe informateur de angel uit het debat. Het konijn uit de hoge hoed. Een brede en korte ronde van enkele weken over de vorm van een nieuw kabinet is een slim en logisch voorstel, al begint het proces daarmee helemaal van voren af aan. Weliswaar is alles weer mogelijk, maar je hoeft niet te verwachten dat er iets anders uitkomt - een meerder- of minderheidskabinet over centrumrechts - en daarom is het slim. Frans Timmermans heeft dat goed door en vraagt direct aan Omtzigt: 'Hoe kun je een kabinet gedogen als je geen vertrouwen in die partij hebt?' Maar de NSC-leider is nog niet aan het woord. Grappig, na Plasterk is Putters de tweede PvdA'er waar Wilders mee komt.
Na de lunchpauze worden twee zaken duidelijk. Yesilgöz wil nu meer dan gedogen; ze wil deelnemen aan een kabinet op rechts. Dus opnieuw met de PVV in zee. En Omtzigt? De stap van de VVD-fractieleider haalt hem niet over. Hij wil dat meer partijen dan de rechtse drie ondersteuning geven aan een minderheidskabinet of een extraparlementair kabinet. Vreemd, hij kent de uitkomst immers, misschien willen enkele resterende rechtse splinters dat, maar alle andere partijen weigerden immers aan een regering deel te nemen met de PVV. Dus de informatie van Putters kan eigenlijk alleen hetzelfde opleveren, zoals ik hierboven al zei: een minderheidskabinet PVV-BBB-VVD met gedoogsteun van NSC. Een overbodige excercitie. Rob Jetten adviseert de vier partijen 'relatietherapie'. Inderdaad. Dit is ons parlement.
Vanochtend staat mijn Valentijnskaart bij Anna's ontbijtbordje. Nooit enig jaar vergeten en ze is er altijd blij mee. Later overkomt me de volgende stap in de decompositie van mijn gebit. Bij het tandenpoetsen raakt een kroon los de op één na achterste kies linksboven. Zo schiet het op. Ik bel maar weer de tandarts en kan morgen aan het eind van de ochtend terecht. De kroon is nog heel; die moet ik meenemen, zeggen ze. Naar het begin van dit kwartaal
Gorinchem (24.046)

Donderdag 15-02-2024
The New York Times brengt uit verschillende bronnen het bericht, onder meer uit de mond van Mike Turner, de voorzitter van het House Intelligence Committee van het Amerikaanse Congres, die op X zegt dat de Russen in de ruimte kernwapens zouden willen stationeren om satellieten van andere landen uit te schakelen. Natuurlijk schrik je van zo'n bericht. Hoe serieus moet je het nemen? Of de waarschuwing iets te maken heeft met een Russische raketlancering vorige week is niet duidelijk. Toen ging een geheime capsule van het Russische leger de ruimte in. Het gebruik van kernwapens in de ruimte zou een flagrante schending zijn van het kernwapenverdrag uit 1963. Deskundigen zijn sceptisch. Een nucleair wapen is er niet voor nodig, je kunt een satelliet ook gemakkelijk met een conventionele raket vernietigen, zegt er een. Daarom denkt een ander dat het de zoveelste stap van Poetin is om de verhoudingen met het Westen op te fokken.
In mijn eerste jaren als dokter - in de jaren 70 - werd het al gezegd: kalm aan met antibiotica en gebruik niet de meest recente. In die tijd kon je goed uit met sulfapreparaten. Ook in mijn tijd in Afrika. De reden was het gevaar van de ontwikkeling van resistentie. Ik meen dat de medici in Nederland zich goed aan het advies hielden, maar in het zuiden van Europa en in de rest van de wereld niet. Sindsdien voeren we een bewapeningswedloop met de vele soorten bacterieën en virussen en hun nog tallozer varianten, een race die we in toenemende mate lijken te verliezen. Het Europese Centrum voor Ziektepreventie en Ziektebestrijding (ECDC) waarschuwde gisteren voor de opmars van een gevaarlijke variant van de Klebsiella pneumoniae-bacterie. Het is een gewone bacterie, een commensaal die natuurlijk aanwezig is in de mond, darmen en op de huid, maar de ST23-variant is wel gevaarlijk. Vooral voor kwetsbare mensen, met name ouderen en mensen met longproblemen. Klebsiella veroorzaakt bij de mens vooral urineweg- en luchtweginfecties. Hij is toenemend resistent tegen antibiotica, zelfs tegen de middelen die gebruikt worden om de zwaarste infecties te bestrijden zoals de carbapenemen, aldus het ECDC. Gezonde mensen worden over het algemeen niet ziek en raken de bacterie op den duur vanzelf wel weer kwijt. De verspreiding in Europese ziekenhuizen neemt toe, vooral van de gevaarlijkste subvariant ST23-K1. De aantallen lijken nog mee te vallen; in 2021 was de ST23-variant in vier Europese landen gesignaleerd, in de nieuwe risicoanalyse al zeker in tien landen. Het aantal gemelde besmettingen steeg in die periode van 12 naar 143. Maar micro-organismen ontwikkelen zich veelal supersnel, kijk maar naar Covid19. De K1-subvariant van deze Klebsiella is hypervirulent.
Informateur Kim Putters gaat uitzoeken wat een extraparlementair kabinet eigenlijk is. Daarvoor heeft hij alle tijd want de politici en dus ook de fractieleiders hebben volgende week vakantie. Ik kan Putters helpen: een extraparlementair kabinet is een kabinet van partijen die elkaar niet zien zitten, maar die wel samen de instroom van vluchtelingen willen beperken.
Eerst nog wat regen, later wordt het droog en ruim 15 graden. Deze donderdag breekt een warmterecord, want in De Bilt meten ze 15,3 graden en daarmee is het oude datum-warmterecord van 15,1 graden uit 1998 gebroken. Met die 15,3 graden is het meteen ook de eerste officiële lentedag van 2024. Vorig jaar was dat overigens al op 1 januari het geval; het werd toen 15.6 graden. Normaal valt voor de periode 1994 - 2024 de eerste lentedag op 11 maart.
Ik ga aan het eind van de ochtend naar de tandarts en die plakt de losgeraakte kroon terug op de basis van mijn voorlaatste kies linksboven. Geen garanties, zegt hij, voor zolang het duurt. Voor mij geen harde noten meer en dergelijke. Vloeibaar voedsel hoeft nog niet. Naar het begin van dit kwartaal
Gorinchem (24.047)

Vrijdag 16-02-2024
De verloren zonen en dochters van het heelal, ik heb er altijd een zwak voor gehad. Hemellichamen, door botsingen en andere heftige gebeurtenissen uit hun planeten- of sterrenstelsels geschoten en sindsdien op een eenzame koers door de kosmos. Nu hebben onderzoekers van de Universiteit van Mexico er zelf twee ontdekt, een tweeling die om elkaar heen buitelend door het universum zwerft. Tweelingobjecten als deze zijn niet zeldzaam. Dit tweetal heeft ongeveer net zoveel massa als onze planeet Jupiter. Enorme bollen van gas die nergens bij horen, op weg in de intergalactische leegte. Het tweetal werd ontdekt bij waarnemingen van de Orionnevel – een bekend stervormingsgebied – met twee radiotelescopen in de VS en de Webb-ruimtetelescoop. Dergelijke tweelingen zijn er meer in de ruimte; ze worden Jupiter-mass binary objects genoemd of kortweg JuMBO’s. Er zijn er tot dusver 40 van gevonden. Wie weet zwermen er ijsmanen omheen net als bij onze gasplaneten. Ijsmanen met grote ondergrondse oceanen van vloeibaar water, waar leven in kan ontstaan.
Gaat Netanyahu met grondtroepen de grensstad Rafah aanvallen en een massaslachting veroorzaken onder de anderhalf miljoen Gazaanse vluchtelingen die er op elkaar gepakt zitten? Ze kunnen nergens meer heen. De hele wereld roept Israël op ervan af te zien. Nu zijn er aanwijzingen dat Egypte toch een opvangkamp bouwt in de Sinaïwoestijn. Tot dusver weigerde president Sisi dat te doen, wetende dat hij er nooit meer vanaf zal komen. Maar zijn regime zit economisch aan de grond en het is niet onwaarschijnlijk dat hij een zak geld van de VS krijgt om gecontroleerd een beperkt aantal vluchtelingen te kunnen toelaten. Hoe dat moet als er een massale stormloop op de grensmuur komt, is niet duidelijk.
Oekraïne vecht ook voor onze vrijheid en democratie. Deze week nam de Tweede Kamer een motie aan van de leden Podt (D66) en Boswijk (CDA) om, 'voor de veiligheid en stabiliteit in Europa, Oekraïne zo lang als nodig is te steunen en minimaal op hetzelfde niveau'. Wie stemden tegen? Behalve de SP, Ja21, DENK en FvD ook PVV en BBB. We weten wat we krijgen met een populistisch-rechts kabinet. Die partijen leveren ons uit aan de schurken en de oorlogsmisdadigers van het Kremlin. Op de valreep lees ik: de Russische oppositieleider Nalvany is overleden, schrijven Russische persbureaus op basis van de gevangenisdienst van het land. Gedood door Poetin. Details ontbreken nog.
Het is grijs, regenachtig en zacht. Vanmiddag heb ik de bestuursvergadering van de Poëzieroute bij lid Marcel V. in Werkendam. En vanavond is de jaarvergadering van onze buurtvereniging Knake in De Sociëiteit op het Eind. Naar het begin van dit kwartaal
Gorinchem (24.048)

Zaterdag 17-02-2024
Steeds opnieuw zie je alarmerende grafieken op de sociale media, waarin getoond wordt hoe extreem hoog de temperaturen in de wereld de afgelopen maanden oplopen, zowel op land als in de wereldzeeën. Het is een gevolg van een aantal factoren die tijdelijk hun bijdrage leveren, zoals de huidige El Niño, recente vulkaanerupties en de 25e cyclus van verhoogde zonneactiviteit. De huidige El Niño zal deze en de volgende maand waarschijnlijk pieken en opgevolgd worden door een koelende La Niña. De 25e zonnecylus loopt nog wel een aantal jaren door, maar zal daarna afnemen. Het effect van het gebruik van schonere brandstof op de scheepvaartroutes vermindert de koelende invloed van zwavelaerosolen. Dat effect zal wel blijven. Vulkaanerupties zijn onregelmatige fenomenen. Een ander incident werd deze week bekend. Een explosie in een boorput in Kazachstan heeft geleid tot een ‘super-emissie’ van het krachtige broeikasgas methaan. Dat is 34 keer krachtiger dan CO2. Uit waarnemingen van een satelliet met het Nederlandse meetinstrument Tropomi aan boord is gebleken dat 205 dagen lang grote hoeveelheden broeikasgas de atmosfeer in kolkten. Volgens wetenschappers is de uitbraak een van de grootste ooit waargenomen. Zeven maanden lang spoot in totaal zo'n 127 kiloton methaan in de atmosfeer; dat is ongeveer de hoeveelheid broeikasgas die 700 duizend benzineauto’s in een jaar verspreiden.
Er is door de student van klimaatwetenschapper en oceanoloog Stefan Rahmstorf dus een mix van incidentele invloeden verwijderd uit de curve van 1950 tot nu, zowel positieve als negatieve. Bijvoorbeeld de heftige El Niño van 1998 en de huidige. Onder al die invloeden zie je in de curve hierboven dat de opwarming door fossiele emissies blijft doorstijgen en dichter bij het einde zelfs versnellen. De student van Rahmstorf uit Potsdam heeft dat zichtbaar gemaakt door de invloed van de El Niño, de vulkaanerupties en zonneactiviteit uit de temperatuurcurve te filteren. Dan zie je wat er werkelijk gebeurt: voortgang en versnelling van de structurele opwarmingstrend. 'Yes, it appears that the rate of global warming has increased'.
Gisteren werd het op de bestuursvergadering van de Poëzieroute en op de jaarvergadering van onze buurtvereniging KNAKE duidelijk dat de gemeente tegenwoordig een moratorium hanteert op nieuwe beelden en teksten in de binnenstad. Men vindt dat er genoeg van zijn. Dus geen nieuwe gedichtlocaties voor de Poëzieroute, waar de projecten rond onder meer Truus Gerhardt (de zus van Ida) voorlopig op langere baan geschoven moeten worden. De plaatsing van een abstract beeld door KNAKE op het Nonnenveld zal ook niet doorgaan. Ik snap het eigenlijk wel; van enige wildgroei was wel degelijk sprake.
De moord op Navalny. Bronnen binnen Kremlin zeiden tegen MoscowTimes journalist Petr Kozlov: 'De baas wilde hem dood dus is hij nu dood', meldt Derk Sauer op X. Waar zijn lichaam nu is wordt niet bekend gemaakt. Gisteren meldde het Russische gevangeniswezen dat Navalny was overleden tijdens 'een wandeling'. Daarmee wordt 'luchten in de gevangenis' bedoeld. Ondertussen werden minstens 273 mensen gisteren en vandaag in 21 steden in Rusland aangehouden bij herdenkingsbijeenkomsten voor Navalny, meldt mensenrechtenorganisatie OVD Info. Ordediensten werkten mensen in de Russische hoofdstad tegen de grond bij een plek waar rouwenden bloemen en berichten hadden achtergelaten ter nagedachtenis aan de oppositieleider. Honderden bloemen en kaarsen die vrijdag in Moskou werden neergelegd ter ere van Navalny zijn ’s nachts grotendeels door de autoriteiten verwijderd. Het is de grootste arrestatiegolf bij politieke gebeurtenissen sinds september 2022.
Nu weer een lentedag, zacht (+13 graden) met veel zon. Drukte op de sluis. Boodschappen. Vanavond gaan Anna en ik romantisch tafelen. Muziek, kaarsen en lekker eten thuis. Naar het begin van dit kwartaal
Gorinchem (24.049)

Zondag 18-02-2024
Zeven maanden geleden was het veronderstelde, ondraaglijk grote aantal 'nareizigers' een van de motieven voor de VVD om het kabinet te laten vallen. Het gaat om de komst van familieleden van asielzoekers met een verblijfsvergunning.'Nareis op nareis', foeterde Yesilgöz. Ze wekte daarbij de indruk dat dit eindeloos zo kon doorgaan. Volgens haar ging het om duizenden gevallen, zei ze tegen de Volkskrant. 'Het verhaal ging een eigen leven leiden', schrijft de persvoorlichter Martijn van der Linden van Vluchtelingenwerk nu op X. 'Meerdere politieke partijen namen het klakkeloos over en het werd een van de belangrijkste asielthema's in de verkiezingen'. Het gezinsherenigingsbeleid moest op de schop. Sterker nog, er was een hele stelselwijziging nodig'. Als je in de cijfers duikt, blijkt de uitkomst onthutsend te zijn. Hoe vaak komt het namelijk voor? Gemiddeld waren er van 880 nareis-op-nareisverzoeken slechts een schamele 350 goedgekeurd in de afgelopen vijf jaar. Dat zijn er hooguit 70 per jaar. Dan is er nog bijvoorbeeld voor kinderen uit gebroken gezinnen nog een andere procedure via een beroep op artikel 8 van het Europees Verdrag voor de Rechten van de Mens. Dat waren er de afgelopen vier jaar circa 1000; daarvan werden er 250 goedgekeurd. Slechts 1 procent van alle ingewilligde nareisaanvragen was in de afgelopen vijf jaar een nareis- op nareisaanvraag, zegt de IND. Nareis-op-nareis-op-nareis (oftewel de 'gestapelde gezinshereniging' van Yesilgöz) komt waarschijnlijk nooit voor. 'Nu de beeldvorming zijn werk heeft gedaan is het resultaat: Draagvlak voor gezinshereniging ernstig beschadigd . Aangenomen motie om het gezinsherenigingsbeleid voor jongvolwassenen strenger te maken. Nog geen zicht op een kabinet dat problemen kan oplossen die wél bestaan. zegt Van der Linden'. Ik krijg steeds meer een hekel aan dat zelfingenomen, koude mens Yesilgöz.
Een grijze zondag met regen die niet van ophouden weet. Dat is wel even anders dan de lentedag van gisteren. Het wordt een graad of tien. Er zijn nauwelijks wandelaars of lopers op de sluis. Iedereen blijft binnen. Een goede dag om deel 2 'The Dark Forest' (2008) van Cixin Liu's geweldige 'The Three-Body-Problem' trilogie uit te lezen. Ik ben er zwaar van onder de indruk. Deel 3 'Death's End' uit 2010 ligt klaar. Naar het begin van dit kwartaal
Gorinchem (24.050)

Maandag 19-02-2024
Er ontstaat altijd oorlog in de geschiedenis van de mensheid. Het statensysteem raakt altijd weer uit zijn evenwicht. Oorlog lijkt het natuurlijke systeem om de ontwikkeling van de mensheid te reguleren. In iedere oorlog worden macht en bezit opnieuw verdeeld. Dat is een van de centrale elementen in 'De onvermijdelijkheid van een nieuwe wereldoorlog' van Ingo Piepers (Prometeus, 2020). Een belangrijk mechanisme is dat van escalatie door wat Piepers het Veiligheidsdilemma noemt: 'het probleem in een anarchistisch statensysteem is dat veiligheid van de ene staat onveiligheid van een andere staat kan betekenen'. Het veiligheidsdilemma werkt als een positief terugkoppelingsmechanisme. Preventieve maatregelen van staat A wordt als dreiging waargenomen door staat B, die daarom zelf ook preventieve maatregelen gaat nemen die weer als dreiging worden waargenomen door staat A, enzovoorts. Voorbeelden van preventieve maatregelen zijn het vergroten van de militaire capaciteit en de vorming van allianties met andere staten, zoals na WO2 de NAVO en het Warschaupact. Het is een zelfversterkende spiraal van wreedheid.
Ik moest eraan denken toen ik vanmorgen een bericht las over een stammenstrijd in Papua-Nieuw-Guinea (PNG). Daarbij waren minstens 49 mensen gedood. Laat nu in Piepers' boek de oorlogsregulatie in Nieuw-Guinea een voorbeeld zijn van hoe het ook kan, met minder slachtpartijen en kleine aantallen doden. Hij wijdt een heel hoofdstuk aan de oorlogscycli in de hooglanden van PNG. Die zijn verankerd in de cultuur van die stammen en ze hebben een regelmaat van zo'n twaalf jaar en een sterk ritueel karakter. De cycli leidden zonder veel slachtoffers tot een herverdeling van macht en land. En vrouwen, want hoe meer vrouwen een stam heeft, hoe meer kinderen en hoe meer macht - maar zonder veel doden, kleinschalig en in een beperkte periode die met grote verzoeningsfeesten werden afgesloten. Zo ging het millennia. Is het nu over?
Het bloedbad vond plaats in de Highlands-regio, in de provincie Enga. De politie spreekt van een slagveld met tientallen doden op de weg en langs de rivier. Mogelijk liggen er nog meer lichamen in de bossen, omdat de politie denkt dat een deel van de betrokkenen gewond is weggevlucht nadat ze in de hinderlaag waren gelopen. De schaalvergroting van de oorlog in PNG komt door een andere factor, die Piepers eveneens noemt en die ook in Europa een grote rol speelde: ontwikkeling van technologie. Steeds betere en slimmere wapens maken meer slachtoffers. Het gebied van de bergstammen in PNG stroomt vol met (automatische) wapens en munitie. Een grote vooruitgang en het einde van de idylle, welkom in de beschaving.
Het is een overwegend grijze maandag. Later komt er nog regen bij. Naar de sportschool en daarna begonnen in 'Death's End' (2010) - als dat zou kunnen! Het is het derde deel van de 'The Three-Body-Problem' van Cixin Liu. Het begint meteen met de val van Byzantium in 1453 en de vraag of de aanwezigheid van leven onze planeet heeft veranderd. Om de donder wel! Zonder leven, in dit geval de cyaonobacterieën ofwel de blauwalgen, was er niet eens genoeg zuurstof geweest voor het ontstaan van complexere levensvormen. 'Thus, the earth that we live on now is a home constructed by life for itself. It has nothing to do with God'. Maar heeft het leven dezelfde invloed op het hele universum gehad? De gesprekspartner van een van de hoofdpersonen antwoordt '..if we are talking about the universe, life is exceedingly rare and its impact on the evolution of the universe can be ignored'. De ander houdt haar mond maar ze twijfelt. '..she knew that life was not so rare in the universe. In fact, the universe was downright crowded. How much has the universe been changed by life! A wave of terror threatened to overwhelm her'. Overigens staat op de voorflap dat Obama destijds erg enthousiast over het boek was. Naar het begin van dit kwartaal
Gorinchem (24.051)

Dinsdag 20-02-2024
De wereld was meteen geschokt en verontwaardigd maar Trump deed er drie dagen over om te reageren. Hij spreekt niet eens van de moord op Navalny, maar van diens dood en zijn reactie gaat er verder helemaal niet over. Die gaat alleen over Trump zelf en wat hij denkt. Geen veroordeling van Poetin, wel de suggestie dat het in Amerika veel erger is dan in Rusland. De man is een verraderlijke protofascist, die een grote kans heeft op herverkiezing als president van de VS. Vind je het raar dat Poetin het Westen niet serieus neemt?
De reacties van Rusland op de dood van Navalny vertonen opvallende inconsistenties. De verklaringen van Russische autoriteiten spreken elkaar tegen. Direct na de bekendmaking van zijn dood vrijdag meldde de Russische gevangenisdienst dat hij 'onwel werd tijdens een wandeling'. Medewerkers van de strafkolonie waar Navalny overleed, vertelden later zijn moeder dat hij was overleden aan ‘het syndroom van een plotselinge dood’. Ze wordt niet bij het lichaam van haar zoon toegelaten. Kremlin-woordvoerder Dmitri Peskov deed door Navalny’s weduwe geuite beschuldigingen af als ‘ongefundeerd en vulgair’. Een moeder die haar zoon wil begraven. Nu is er blijkbaar nog twee weken onderzoek nodig. ‘Ze liegen en rekken tijd’, aldus Navalny’s woordvoerder Kira Jarmysj. De sporen van de moord moeten worden uitgewist. In De Volkskrant staat vanmiddag een Open Brief van Ilja Jasjin, ook een gevangene in een Russisch strafkamp en lid van de oppositie. Hij moet een straf van 8,5 jaar uitzitten en vernam pas gisteren over de dood van Navalny. 'Voor mij is het niet de vraag: wat is er met Navalny gebeurd? Ik twijfel er niet aan dat hij is vermoord. Drie jaar lang stond Aleksej onder controle van de veiligheidsdiensten, die in 2020 al een mislukte aanslag op zijn leven hadden georganiseerd. Nu hebben ze dat afgemaakt.'
De steun aan het strijdende Oekraïne stagneert, de Republikeinse partij wil een groot hulppakket niet in het Huis van Afgevaardigden behandelen, Het Oekraïense leger moet de stad Avdiikva opgeven en de meeste politici in Europa durven uit angst voor de boeren niet over te schakelen op een oorlogseconomie. Hét voorbeeld voor een moedige stap is Denemarken. Het land erkent dat Oekraïne aan de rand van verlies balanceert en doneert zijn complete artillerie-voorraad aan Kyiv. Estland schroeft de productie van munitie sterk op. Wat gebeurt bij ons? Nederland vindt het om de een of andere reden niet nodig om zelf munitie te gaan produceren, zegt Arrnout Brouwers op X. 'Alles met het excuus van "doelmatigheid" - maar was je er twee jaar geleden mee begonnen, hadden Oekraiense soldaten nu van je besluit kunnen profiteren'. Onze politici zijn op crocusvakantie en de informateur spreekt met wetenschappers.
In Quantamagazazine staat een onthutsend artikel over grote taalmodellen, zoals ChatGPT, en hoe snel die groter worden en zichzelf nieuwe vaardigheden leren. Bij veel taken gaat de ontwikkeling geleidelijk maar het komt ook voor dat de modellen langere tijd lijken te stagneren tot ze onverwacht opeens een grote sprong vooruit weten te maken. Ook andere testruns laten dat soort sprongen zien. De onderzoekers spreken van 'doorbraakgedrag' en noemen het met een populair woord 'emergentie'. Men probeert uit te vinden hoe dergelijke sprongen tot stand komen. 'How do we not get surprised by the next generation of models?' Inderdaad, dat is de vraag.
Een droge dag, vandaag, met soms wat zon. De wind is zuid, het wordt 11 graden en er hangt een rare, chemische lucht over haven en wal. Of is het een brandlucht? Waar dat vandaan komt? Naar het begin van dit kwartaal
Gorinchem (23.052)

Woensdag 21-02-2024
Door het lezen van de 'Three-Body-Problem'-trilogie van Cixin Liu kom ik weer eens bij de Fermi-paradox terecht. In een discussie anno 1950 over de waarschijnlijkheid van buitenaardse beschavingen in het megagrote universum merkte de natuurkundige Enrico Fermi op: 'So where are they?' Ik schreef er graag en vaak over. Het lemma op Wikipedia over de paradox geeft een scala van redenen waarom we nooit ook maar iets hebben gemerkt dat er andere intelligenties in het universum zouden bestaan. Cixin Liu denkt dat het komt omdat ze elkaars bestaan schuwen en erop uit zijn ieder contact te vermijden. Dat is verreweg de meest verstandige koers.
De auteur poneert twee axioma's:
(1) Overleven (survival) is de meest primaire behoefte van een beschaving.
(2) Beschaving groeit en dijt voortdurend uit, maar de totale materie in het heelal blijft gelijk.
Hm, Ik denk dat een beschaving zichzelf ook te gronde kan richten, maar dat terzijde. Wanneer een beschaving een zekere drempel van wetenschap en technologie overschrijdt, aldus Liu, zal hij beginnen zich te verspreiden in zijn galactische omgeving. Inderdaad, kijk naar het voorbeeld van de ontdekkingsreizen op aarde. Die werden gevolgd door een meedogenloze koloniale uitbuiting. Intelligente beschavingen in de ruimte kunnnen al miljoenen tot miljarden jaren geleden ontstaan zijn. De kosmos kan er sindsdien mee volgepakt zijn. Onze eigen technologische ontwikkeling is pas 300 jaar oud en reizen door de ruimte doen we pas 60 jaar. We zijn in kosmisch opzicht een baby, een laatbloeier. De technologische ontwikkeling gaat ten opzichte van de voorafgaande miljarden jaren wel ineens supersnel, alsof hij gelanceerd wordt. In een vingerknip. Dat is een technologische explosie, die potentieel in elke intelligente vorm van leven los kan barsten - en hem gevaarlijk voor anderen kan maken - en wij zijn misschien inderdaad een laatbloeier, vele andere waren ons voor.
Bedenk dat een beschaving 'goed' of 'kwaad' van aard kan zijn. Uit op coöperatie of op beheersing en verovering. SteL twee civilsaties A en B liggen op een afstand van 100 lichtjaren van elkaar. Degene die zonder het te weten enig signaal uitzendt in de richting van de andere, maakt daarbij zijn bestaan bekend. Dan weet beschaving B ook in welke richting beschaving A te vinden is en kan naar A op zoek gaan. Als B 'goed' is en voldoende technologie heeft kan het met A contact maken en gaan samenwerken. Als B 'slecht' is kan het A veroveren en tot slaaf maken of uitroeien.
Op dit punt introduceert Liu het begrip 'keten van verdenkingen' (chain of suspicion). A en B kunnen niet weten of de ander 'goed' of 'kwaad' in de zin heeft. Dan kun je je maar beter voorbereiden op het ergste - 'kwaad' - en je bewapenen, zelfs als er nog helemaal geen contact is. Maar als de ander (B) die wapens waarneemt, kan hij denken dat A een 'slechte', agressieve beschaving is en A aanvallen en vernietigen. Bij onzekerheid is vernietigen altijd de veiligste koers. Alle intelligente samenlevingen in het heelal doen er het best aan zich koest te houden, geen contact op te nemen en te hopen dat ze niet ontdekt worden. Natuurlijk zou na ontdekking communicatie mogelijk de onzekerheid tussen A en B kunnen oplossen, maar dat is geen vaststaand gegeven. Dus: beter duiken en je stilhouden. Ziedaar de verklaring van de Fermi-paradox. Een zeer Darwiniaans beginsel.
Liu vergelijkt die situatie met een donker woud, waar diverse jagers zonder licht in rond zwerven. Jij bent er een van. Stel je hoort verderop een takje knappen of je ziet een lichtje. Dan gaat de chain of suspension werken. Om in het woud te overleven kun je maar beter meteen schieten, voor de ander je opmerkt en kan schieten. In Liu's woorden: 'The universe is a dark forest. Every civilization is an armed hunter stalking through the trees like a ghost, gently pushing aside branches that block the path and trying to tread without sound. Even breathing is done with care. If he finds other life - another hunter, an angel or a demon, a delicate infant or a tottering old man, a fairy or a demigod - there's only one thing he can do: open fire and eliminate them. In the forest, hell is other people. An eternal threat that other life that exposes its existence will be swiftly wiped out. This is the picture of cosmic civilization. It's the explanation of the Fermi Paradox'.
En, gaat Liu verder, in dat donkere woud heeft een onnozel kind dat 'mensheid' heet, een kampvuur gebouwd en staat ernaast te schreeuwen: 'Hier ben ik!' Heeft iemand het gehoord? 'That's guaranteed.' We hebben misschien nog het geluk dat we met het zonnestelsel aan de verre rand van de Melkweg zitten.
Deze woensdag is een grijze dag. Met 11 graden is het zacht. Vanmiddag gaat het vanuit het westen regenen. Morgen opnieuw regen. Het wordt dan een stuk onstuimiger met een vrij krachtige tot harde zuidwestenwind. Tegelijk wordt het erg zacht, 10 tot 13 graden. Naar het begin van dit kwartaal
Gorinchem (24.053)

Donderdag 22-02-2024
Vanmorgen is het droog als we naar de sportschool gaan, vanmiddag komt er regen, de barometer loopt snel terug en vanavond en vannacht krijgen we te maken met storm Louis. Aan zee kan het tijdelijk stormen en dan is er kans op zeer zware windstoten van 100 tot 110 km/uur. Ook rond het IJsselmeer kunnen de windstoten snelheden van ruim 100 km/uur bereiken. Het KNMI stelt code geel in. Het is ook nog extreem zacht met 13 à 14 graden. Storm Louis treft vooral de Golf van Biskaje. Hij slingert zich grotendeels om ons land heen, zoals je op de prognose hierboven ziet. De depressiekern ligt met een druk van 956 hPa over de Noordzee en trekt snel door naar Noorwegen.
's Middags bezoek van Barbara, Esri en Zaila. Nikita komt langs om haar dochter op te halen. Straks op bezoek bij buren Lourens & Joke.
De dwaasheid rond Ter Apel stijgt ten top. Gisteravond dacht het COA het maximum van 2000 asielzoekers te halen. De gemeente Biddinghuizen sprong in de bres en het leek te lukken, maar kennelijk kwam er voor middernacht toch nog een buslading vluchtelingen aan. Daardoor waren er 32 teveel en moet het COA de gemeente een boete van 15.000 euro betalen. Dat gaat ten koste van het budget waarmee het COA opvang moet regelen. Dus nog minder geld voor opvangplaatsen, dus meer boetes tenzij de staat alsnog bijspringt. Extra noodopvang, bijvoorbeeld in hotels, is veel duurder dan reguliere opvang. Het COA wordt betaald door de staat, die niet zorgt voor voldoende opvangplaatsen. De staat wordt betaald uit onze belastingen dus wij betalen die boetes uiteindelijk. Het zijn de VVD en populistisch rechts die een meerderheid in de Tweede Kamer hebben en het er bewust op aan laten komen, want eerst moet de instroom minder worden. Het is een bewust gecreërd probleem, want in eerdere jaren werd de capaciteit van de opvang fors verkleint. Dat kan niet zomaar want internationale verdragen en zo. Dus blijft de wantoestand groeien, de cirkel is rond, nee het is geen cirkel, het is een stijgende spiraal van ellende. Ik vrees dat het een opzettelijke strategie is: door het probleem te verergeren probeert rechts zijn zin door te drijven.
(Aanvulling: later blijkt dat de overheid de dwangsom van 15.000 euro rechtstreeks zal uitbetalen aan de gemeente Westerwolde, waar Ter Apel ligt. Het COA wordt er dus niet armer van).
De val van Adiivka laat zien dat er een gevaarlijke toestand rond Oekraïne ontstaat, veroorzaakt door de haperende leveranties van wapens en munitie door het verdeelde westen. Dat gebrek is niet zomaar opgelost. Poetin gaat zijn kaarten verder uitspelen. Er gaan vandaag geruchten dat het ministaatje Transnistrië zal vragen om officiële annexatie door Rusland. Dat hebben ze overigens al vaker gevraagd, maar nu wordt beweerd dat Poetin het over een week officieel zal aankondigen. In het langgerekte staatje langs de rivier de Dnjestr liggen sinds de jaren 90 troepen van het 14e Russische leger. Het staatje is volgens internationaal recht formeel nog onderdeel van de republiek Moldavië die kandidaat-lid van de EU is en het lidmaatschap van de NAVO heeft aangevraagd.
In de NRC concluderen Bob Deen en Dick Zandee van Instituut Clingendaal dat Europa zich feitelijk reeds in een semi-oorlogssituatie bevindt. 'Dat vraagt om een semi-oorlogseconomie waarbij de defensie-industrie anders wordt aangestuurd. Onze veiligheid is te belangrijk om geheel aan de markt over te laten.' Sterker, in mijn ogen verraadt de markt momenteel nogal de strijd tegen staatsterreur en agressie van het Kremlin, getuige het massale schenden en omzeilen van de sancties. Bijvoorbeeld via Kyrgizistan. Daarmee steunen grote sectoren van ons bedrijfsleven de oorlog van Poetin. We kunnen dat niet blijven negeren. De EU moet zo snel mogelijk een commissaris voor Defensie aanstellen, die de wapenproductie in de Unie moet opvoeren. 'Verzekerde langetermijnorders, voorrang bij de toelevering van grondstoffen en de heroprichting van staatsbedrijven moeten tot de opties behoren. In de nieuwe Europese Commissie moet een commissaris voor Defensie de verbinding leggen tussen behoeftes – van Oekraïne en van de lidstaten – en het opschalen van de wapenproductie.' Naar het begin van dit kwartaal
Gorinchem (24.054)

Vrijdag 23-02-2024
Storm Louis bracht gisteravond zware tot zeer zware windstoten. Op de Houtribdijk werd een zeer zware windstoot van 114 km per uur genoteerd. Aan zee en op het IJsselmeer is op enkele momenten ruim windkracht 9 gemeten. Vanaf 22 uur gold code oranje voor het hele land. In Drachten woei een zijgevel van een hotel af. Bomen vielen op auto's en huizen. Vanochtend is het weer rustig, de waarschuwingen zijn ingetrokken, het wordt een dag met heel wat zon. Wat minder opviel is dat gisteren in de Bilt het record voor de hoogste minimumtemperatuur op een 21 februari (sinds 1901) werd gebroken. We tellen nu acht warmterecords dit jaar tegen nul kouderecords in de uitgebreide reeks. Ik heb de indruk dat de warmterecords niet veel stijgen; het zijn de kouderecords die steeds minder voorkomen.
Na vier eerdere mislukkingen maakte gisteren de eerste onbemande commerciële maanlander Odysseus een zachte landing op de maan. De landingsplaats ligt op de zuidpool. Aan boord zijn zijn zes instrumenten van ruimteorganisatie NASA en experimenten van verschillende universiteiten en een doos met 125 glimmende beeldjes van Jeff Koons, als onderdeel van een kunstproject.
De geniepigheid van het Kremlin. Aanhangers van de Russische oppositieleider Aleksej Navalny die werden opgepakt toen zij na zijn dood bloemen legden in verscheidene steden, hebben een oproep voor het leger gekregen. Zo kregen acht sympathisanten van Navalny die in Sint-Petersburg waren opgepakt, een oproep voor militaire dienst in hun handen gedrukt voordat ze door de politie werden vrijgelaten. De mannen die de papieren uitdeelden, dreigden ‘hun vingers te breken’ als ze niet zouden tekenen voor de oproep, vertelde een van de arrestanten tegen de nieuwssite Rus.News. Uiteraard worden ze naar het front in Oekraïne gestuurd. Het zullen niet de meest gemotiveerde soldaten zijn.
Met de terugkeer van Trump keert ook het debat over een Europees kernwapen terug, schrijft de filosoof Vooral in Duitsland waar de Groenen, nota bene een partij die is groot geworden in de strijd tegen kernenergie, die eind vorig jaar het debat aanzwengelden over een Europees kernwapen. Voormalig minister van Buitenlandse Zaken Joschka Fischer stelde dat Europa zich moet afvragen of de EU een eigen nucleaire afschrikking nodig heeft voor het geval Trump herkozen wordt en de NAVO opbreekt. Wat als de VS hun nucleaire paraplu boven Europa inklappen? Het Franse kernwapen zou het eerst in aanmerking komen, meent Kerres, want dat van de Britten is door de Amerikaanse Trident-raketten te afhankelijk van Washington. 'Parijs is heer en meester over zijn eigen kernwapens die dan ook geen deel uitmaken van de NAVO-afschrikking. NAVO-bondgenoot Frankrijk is geen lid van de Planning Group'. Voorstanders van een Europese oplossing stellen dat een Europees wapen als afschrikking geloofwaardiger is omdat Europeanen meer belang hebben bij de verdediging van Europa dan Amerikanen. Kerres neemt geen stelling in. 'De Europeanen eerst maar eens proberen de basale 155 millimeter granaat op grote schaal te produceren om dan later eventueel de hoge kunst van de nucleaire afschrikking ter hand te nemen'. Tja, dan kan het natuurlijk te laat zijn. Naar het begin van dit kwartaal
Gorinchem (24.055)

Zaterdag 24-02-2024
Deze oproep tot militaire steun aan Oekraïne verschijnt vandaag op de sociale media. Hij wordt onderschreven door een overgrote meerderheid van de partijen in het parlement, zelfs de BBB, maar je ziet meteen dat de Poetinvriendelijke PVV niet ondertekent (en ook Baudet en Ja21 niet). Het onderwerp kwam nog niet veel aan de orde bij de informatie. Misschien werd het gemeden; de vier partijen keken nauwelijks over de grens en richtten zich bij uitstek op het eigen land: de rechtststaat en de asielzoekers 'die over Nederland heen lopen'. Maar de haperende strijd van Kyiv zou bij de formatie wel eens de olifant in de kamer kunnen zijn, schrijft Bas Heijne vandaag in de NRC. 'De Russen moeten in de pan gehakt worden, maar reken niet op ons'. 'Wie gelooft oprecht dat een regering waarin hij (Wilders) domineert ook maar een vinger zal uitsteken om ons land tegen (die) tomeloze agressie te beschermen? Hoe dan? Het wordt tijd dat de andere rechtse partijen hun conclusie trekken. Voor het te laat is.' Vandaag is Wilders weer op X bezig de steun aan Kyiv te ondergraven. Hij hekelt dat de demissionaire regering een veiligheidsakkoord voor tien jaar heeft gesloten met Oekraïne. In dat akkoord staan afspraken over militaire steun, samenwerking op het gebied van de defensie-industrie, steun tegen cyberaanvallen en hulp bij de wederopbouw.
Na de inname van Avdiivka wanen de Russen zich al zeker van de uiteindelijke zege. Oud-president Medvedev zegt in een lang interview aan de vooravond van twee jaar 'militaire operatie' dat hij in 2024 de overwinning verwacht. 'De voortekenen zijn niet slecht.' Medvedev voorspelt de inname van 'de Russische stad' Kyiv, 'zo niet nu, dan over enige tijd'.
In zijn redactioneel commentaar schrijft de NRC dat het angstige, afwachtende Westen zich zich de precaire situatie van Oekraïne zwaar moet aanrekenen: 'Maar aan het begin van het ‘derde’ oorlogsjaar heeft Moskou militair de overhand, ondanks alle blunders op het slagveld. En de Europese landen moeten zich de precaire positie van Oekraïne zwaar aanrekenen. De tijd die het steenrijke Westen nog heeft om het belegerde land uit Russische handen te houden tikt snel weg. Het zal inmiddels duidelijk zijn dat een verdere Russische opmars niet alleen rampzalige gevolgen heeft voor de Oekraïense soevereiniteit, maar ook voor de veiligheid van de rest van Europa, inclusief het NAVO-grondgebied.' Iemand moet Wilders en zijn kornuiten minstens duidelijk maken dat we bij een Russische overwinning hier een stortvloed van miljoenen Oekraïense vluchtelingen kunnen verwachten.
Caroline de Gruyter trekt het vanmorgen breder in haar column in dezelfde krant. Er komen steeds meer sombere verhalen uit Oekraïne; niemand kan nu nog achterover leunen, vindt ze. Ze noemt de huidige toestand 'een klassieker', de aftakeling van veel grote rijken begon steeds met het verlies van buitenposten. Op drie fronten wordt het westen bedreigd: Oekraïne, het Midden Oosten en Taiwan. Op twee ervan wordt al gevochten. Als die drie grenzen het beginnen te begeven, interpreteert de uitdager dat als aanmoediging om door te stoten, omdat het centrum zichzelf kennelijk niet wil verdedigen. 'Als de poging van Vladimir Poetin om Oekraïne in te lijven in een herrezen Russisch rijk inderdaad een test is van de Amerikaanse wil om zijn invloedssfeer te verdedigen, wordt het signaal nu duidelijk: Washington wil niet vechten. Het stuurt zijn bondgenoten aan de frontlinie, die voor het Westen vechten en doodgaan, niet eens genoeg wapens. Voeg daarbij het feit dat de VS elke controle heeft verloren over zijn bondgenoot langs die àndere frontlinie – Israël – en de trend wordt duidelijker. Driemaal raden welke les China, lonkend naar Taiwan, hieruit trekt.'
Vandaag is er wat zon, regent het wat en dat is dat. Voor het eerst sliepen er afgelopen nacht minder dan 2000 asielzoekers in Ter Apel; het waren er 1935. De vorige beide nachten waren het er meer en moest het COA c.q. de staat c.q. de belastingbetaler dwangsommen van 15.000 euro betalen. Naar het begin van dit kwartaal
Gorinchem (23.056)

Zondag 25-02-2024
Het is nu al duidelijk: dit is de warmste februari ooit gemeten sinds 1901. De gemiddelde temperatuur in De Bilt komt uit tussen 8,1 en 8,3 graden. Daarmee wordt het oude record van 7,6 graden uit 1990 met zekerheid gebroken. Normaal is het in februari gemiddeld 4,2 graden; dat is gemiddeld over de periode 1994-2023. In de top 10 van warmste februarimaanden staan inmiddels vijf maanden uit deze eeuw. Naast 2024 zijn dat 2002, 2014, 2020 en 2022. We hadden vrijwel steeds zuidenwinden die de ene na de andere depressie aanvoerden met veel regen. Daardoor wordt het ook een van de natste februari's. Gemiddeld over het land viel 110-120 mm en daarmee komt februari 2024 op een vierde of vijfde plek terecht in de lijst met natste februarimaanden sinds 1906. Recordhouder blijft februari 2020 met landelijk gemiddeld 144 mm. Februari was bijzonder somber met 50-60 uur zon tegen 96 normaal.
De Volkskrant heeft een reportage over de Mexicaanse axolotl, een wereldwijd een geliefd aquariumdier. Maar 'de vrolijk ogende salamander', het unieke diertje dat in staat is een poot weer aan te laten groeoen als een vijand hem afbijt, is bijna uitgestorven in zijn laatste habitat: de vervuilde kanalen van natuurpark Xochimilco in Mexico-Stad. Een team biologen zet alles op alles om het ‘watermonster’ te redden. Wetenschappers telden in 1998 in het gebied nog duizend axolotls per vierkante kilometer. In 2014, de laatste census, waren er 35 per vierkante kilometer over. In de afgelopen kwarteeuw is de vervuiling in het park in razend tempo toegenomen. De stad rukt op, steeds meer afval en rioolwater belanden in het natuurgebied. Maar de grootste dreiging vormt het stadstoerisme: de laatste waterwegen van Mexico-Stad zijn verworden tot een plek om te feesten. In de weekenden vullen de kanalen zich met kleurrijke trajineras, platbodems vol beschonken en luidruchtige dagjesmensen. Zo lopen wetenschappers en milieufreaks redderend en reddend achter de rampen van onverschillige globale grootkapitalisme aan. Onbegonnen werk, uiteindelijk, maar ja wat moet je?
Een zondag met gaandweg steeds meer zon, vooral 's middags. Dat lokt vele Gorcummers naar buiten te gaan. Op de sluis een drukte van belang. We krijgen Barbara, Tessa en Vajèn op bezoek. Naar het begin van dit kwartaal
Gorinchem (24.057)

Maandag 26-02-2024
De James Webb ruimtetelescoop levert nieuwe kennis van de vroege geschiedenis van het heelal. Zozeer dat het ernaar uit begint te zien dat gangbare theorieën herzien moeten worden. Een internationaal onderzoeksteam onder leiding van Karl Glazebrook van Swinburne University of Technology in Australië publiceerde deze maand in Nature nieuwe spectroscopische gegevens van de Webb-ruimtetelescoop van een populatie van sterren van meer dan 11 miljard jaar geleden, die omvangrijker is dan ons Melkwegstelsel en volgens Astronieuws eigenlijk niet zou mogen bestaan. Zoals het zeer oude stelsel op de foto hierboven, dat we waarnemen als een rode schijf zoals het er 11,5 miljard jaar geleden uitzag. Het antieke stelsel bevat massieve sterren die toen al 1,5 miljard jaar oud moeten zijn geweest. Dat brengt de leeftijd op 13 miljard jaar, terwijl het universum zelf 13,8 miljard jaar oud is. 'Dat lijkt onmogelijk, omdat er op dat moment nog niet genoeg donkere materie was samengeklonterd om de vorming van deze sterren mogelijk te maken'. Er worden steeds meer van die zware, oude sterrenstelsels gevonden. Ze worden 'rustig' genoemd omdat de vorming van nieuwe sterren er allang geleden gestopt is, terwijl stervorming overal elders in het heelal gewoon bleef doorgaan. Waarom stopte de stervorming? Was er geen sterrenstof meer? Geen idee. Enfin, de auteurs van het artikel hebben er zin in. 'This observation may point to the presence of undetected populations of early galaxies and the possibility of significant gaps in our understanding of early stellar populations, galaxy formation and/or the nature of dark matter', schrijven ze.
Het is een vreemde gedachte dat die stelsels vele miljarden sterren bevatten, die zeer oude planetenstelsels kunnen hebben. Onze eigen aarde kent pas leven sinds iets meer dan 4 miljard jaar. Zodra onze planeet was afgekoeld ontstond het haast meteen. Zou in 13 miljard jaar tijd, dus in driemaal zoveel tijd, niet ergens in die stokoude oerstelsels leven hebben kunnen onstaan? Misschien zelfs beschavingen die in de onafzienbare hoeveelheid tijd ook weer vergingen? Misschien wel meerdere keren? De mens bestaat pas 200.000 jaar en onze beschaving circa 5000, de technologische revolutie 300 jaar. In kosmisch opzicht is dat niets, een oogwenk en nu al hebben we onszelf nu al in gevaar gebracht. Het onderzoek gaat verder zoals het altijd doet.
Het is een haast onmogelijke vraag, maar wie weet woonruimte in Amsterdam, Haarlem of omgeving? N, de 35-jarige dochter van een buurvrouw op het Eind, gaat in Amsterdam werken en zoekt een kamer per 1 april. Het hoeft geen grote kamer te zijn, als ze maar ergens kan beginnen en van daaruit verder zoeken. Ze is drukker van haar vak en gaat werken bij de vermaarde drukkerij van Rob Stolk. Mijn generatie kent Rob Stolk als bekend lid van de Provo-beweging in de jaren 60. In 1976 begon hij de drukkerij die uitgroeide tot een hoogkwalitatief bedrijf dat opdrachten doet voor talrijke kunstenaars, fotografen, musea, uitgeverijen en vormgevers, nationaal en internationaal. Het is voor N. een prachtige kans om verder te groeien in haar vak. We kennen haar als een aardige, sociale en rustige dame. Mocht een van de lezers ergens iets weten, neem dan s.v.p. contact met me op via het Gastenboek of via tomzijlstra@cs.com.
Het is een kille regendag. Vandaag gaat Kim Putters verder met zijn informatie. Hij spreekt onder meer met Van der Plas. Die heeft een brief bij zich waarin staat dat ze 'een volkskabinet' wil. Ja, hoor.
We wachten al vier weken op bericht van onze verzekering wat betreft de schadeclaim voor de boot. Ik stuur een reminder naar de tussenpersoon, die op haar beurt een herinnering naar Unigarant stuurt. We doen steeds stommer dingen. Ditmaal is het Anna. Ze doet boodschappen in de binnenstad en keert terug met de gekochte spullen in het verkeerde boodschappenkarretje. Het lijkt wel op het goede, het is zwart maar toch anders. De beugel is anders en er is een stukje af. Ze belt de Coöp (die tegenwoordig in een Plus verandert) en krijgt het telefoonnummer van de eigenares. Terug naar de Westwagenstraat waar ze in de winkel het foute karretje omruilt voor het goede met de aankopen bij de Marokkaanse groenteboer er nog in. 's Middags nog steeds regen; het is troosteloos weer. Naar het begin van dit kwartaal
Gorinchem (24.058)

Dinsdag 27-02-2024
In oktober vorig jaar dreigde het al. Toen werd het vogelgriepvirus aangetroffen bij zeevogels op South Georgia. Nu heeft het ook het Antarctisch schiereiland bereikt. Het werd aangetoond bij dode kleine jagers, een zeevogelsoort in de omgeving van het Argentijnse onderzoekstation Esperanza Base. In maart 2020 was ik nog op dat station met de Bark Europa. In Zuid-Amerika raakten onder meer pinguïns besmet. Of de mensen op de Argentijnse basis de quarantaineregels hebben verwaarloosd, weet ik niet, het virus kan ook door besmette vogels naar Antarctica zijn gebracht, hetzij vanuit Vuurland, hetzij vanaf South Georgië. De verspreiding is vrijwel wereldwijd, alleen heeft het Australië nog niet bereikt. Nu wordt gevreesd dat de vogelgriep massale sterfte aan zal richten onder pinguïns op de Zuidpool. Die leven daar dicht op elkaar in enorme kolonies. 'Het wordt een slagveld met miljoenen doden', voorspelde ecoloog Marcel Klaassen eerder bij de NOS. Volgens experts is aan de huidige variant van vogelgriep bijna niets meer te doen.
Klimaatverandering? De Zoogdiervereniging, waar klaarblijkelijk ook mensen lid van mogen worden, heeft het jaar 2024 uitgeroepen tot het Jaar van de hermelijn. Goed initiatief, want de hermelijn verdwijnt stilletjes uit Nederland. Dat komt niet alleen omdat er steeds minder prooidieren zijn: muizen en konijnen, maar ook omdat het dier een witte schutkleur heeft - maar er zijn geen witte winters meer. Die witte schutkleur is nu geen voordeel meer. Uit foto's is duidelijk geworden dat hermelijnen in Nederland nog steeds wit worden rond 1 december en pas begin maart weer langzaam verkleuren naar hun zomervacht. Hun DNA-schakelaar reageert niet op temperatuur maar op daglengte. Die verandering blijft doorgaan. Hoe treurig. Maar misschien redt evolutie wel als bruinblijvende hermelijnen tijdig een selectievoordeel krijgen.
Klimaatverandering? Extreme regenval leidt tot gaten en verzakkingen op begraafplaatsen in Brabant. Het zand rond de graven wordt door het water weggespoeld en daardoor ontstaan kieren, gaten en verzakkingen. Per graf zijn zo'n vier kruiwagens aan zand nodig om de gaten op te vullen. Het is dit jaar natter dan ooit in de provincie Brabant; 60 procent meer dan gemiddeld.
Macron zei gisteren iets bijzonders op een Europese veiligheidsconferentie over steun aan Oekraïne van 20 Europese leiders in Parijs. 'Er is nu geen eensgezindheid om grondtroepen te sturen. Maar in de dynamiek mag niets worden uitgesloten. We zullen alles doen wat nodig is, zodat Rusland de oorlog niet kan winnen'. Een proefballonnetje? Een defensie-expert van het HCSS veronderstelt dat het mogelijk zou zijn bij een vredesakkoord of bij een staakt-het-vuren. Rusland zou een zuidoostelijk deel van Oekraïne bezetten en de NAVO een westelijk deel. De facto een opdeling van het land. Dat NAVO-troepen nu zouden gaan meevechten acht hij echter uitgesloten. Kort voor de top zette de Duitse bondskanselier Scholz een streep door het beschikbaar stellen van Duitse Taurus-kruisraketten aan Oekraïne. Deze raketten kunnen volgens Scholz alleen met hulp van Duits personeel worden ingezet. Duitsland zou daardoor direct bij de oorlog betrokken raken en dat wil hij niet. Overigens stelde Rutte namens Nederland honderd miljoen euro extra beschikbaar voor wapens en vooral munitie.
De Franse president oogste weinig bijval voor zijn opmerking. Regeringsleiders van Zweden, Polen, Tsjechië en Slowakije lieten meteen weten dat zij niet van plan zijn hun soldaten naar Oekraïne te sturen. Ook anderen zoals Rutte en de Belg DeCroo waren terughoudend. Mychajlo Podoljak, een adviseur van de Oekraïense president Zelensky, reageerde verheugd op de uitspraken van Macron. ‘Dit toont bewustzijn over de risico’s die voor Europa dreigen als gevolg van een militaristisch, agressief Rusland’, zei Podoljak tegen Reuters. Kremlinwoordvoerder Dmitri Peskov waarschuwde zoals steeds dat het sturen van troepen naar Oekraïne een oorlog tussen Rusland en de NAVO-lidstaten onvermijdelijk maakt.
Ondertussen is de formele toetreding van Zweden tot de NAVO na het (laatste) akkoord van Hongarije een feit. Daarmee krijgt de NAVO een strategische parel in handen, schrijft De Volkskrant, het eiland Gotland. Het eiland ligt 'als een grondgebonden vliegdekschip' midden in de Oostzee op 140 kilometer van de Baltische Staten en 280 kilometer van Kaliningrad, de zwaar bewapende Russische enclave. We waren er eens in de oude hoofdstad Visby met Dulce in de zomer van 2004.
Na de regen van gisteren hebben we vandaag een mooie, zonnige dag. Samen braaf naar de sportschool. Werklieden van een schoonmaakbedrijf zijn begonnen in opdracht van de havendienst alle kades en trappen met hogedrukspuiten schoon te spuiten. Ze ruimen ook de berg van donkere herfstbladeren op die de gemeente deze herfst liet liggen. De verbouwing van het voorzieningengebouw vordert. Vandaag halen ze alle dakpannen weg. Er komen pannen terug met zonnecellen. Naar het begin van dit kwartaal
Gorinchem (24.059)

Woensdag 28-02-2024
We ontwaken door geraas buiten. In de grijze ochtend staan de mensen van het schoonmaakbedrijf de sluis schoon te spuiten. Foto van gemaakt. Later licht een schuchter zonnetje ze bij en tovert een gloed van gouden druppels op de spuitwolken. Ik vergeet er een foto van te maken. Ik schreef eerder dat we steeds vaker stomme dingen doen. Nu ik weer: als je twee bakjes koffie maakt met de Senseo zet je er twee kopjes onder en drukt op de knop voor twee; ik zet er twee kopjes onder en druk op de knop voor één. Wist je dat je dan twee halfvolle kopjes met lauwe koffie krijgt?
Door de binnenstad loop ik naar het stadhuis. Een afspraak voor een nieuwe ID-kaart, de huidige verloopt deze maand. Ik geef de dame van de balie mijn oude en ze kijkt op haar scherm. 'U heeft helemaal geen ID-kaart', zegt ze verbaasd, 'volgens het systeem werd hij in 2015 ingenomen'. 'Toch ligt hij nu voor u', zeg ik. Raadsel. Ze gaat weg om het aan haar chef te vragen. Als ze terugkeert heeft ze een oplossing gekregen. Ze gaat de kaart administratief niet vervangen maar een nieuwe voor me aanvragen (alsof ik er geen had). Volgende week kan ik hem ophalen.
In de middag trekt bewolking binnen. Anna gaat naar haar vriendin op de Schuttersgracht.
Ik herinner me goed dat Geert Wilders in december erg boos was toen 1e Kamerfractie van de VVD vóór de Spreidingswet stemde. Had Yesilgöz haar partij wel in de hand?, foeterde hij. Afgelopen weekeinde deed Wilders een concessie wat betreft steun aan Oekraïne. Daar viel met hem over te praten. Maar een dag of wat later stemde de PVV-fractie in de 1e Kamer tegen extra steun aan Oekraïne. Heeft Geert zijn partij wel...? Ach, Geert heeft helemaal geen partij. Vanochtend, voor een gesprek met Putters, maakt hij zich ervan af met een flauwe smoes: er was nog niet over gesproken tijdens de informatie. 'Mijn handreiking was dat wij willen praten over andere vormen van steun. Maar er is nog geen gesprek geweest’. Dus gewoon een stukje onderhandelingstaktiek. Naar het begin van dit kwartaal
Gorinchem (24.060)

Donderdag 29-02-2024
Schrikkeldag. In Nieuw-Zeeland kunnen ze vandaag niet tanken bij benzinestations. De software kent de datum niet. In Eisinga's planetarium in Franeker is het elke vier jaar een extra klusje. Op de zolder van het gebouw moet iemand het datumwiel los koppelen en een dagje terugzetten, dus naar 28 februari. Dan gaat het weer goed. Het gebeurt al eeuwen zo. Met de planeten in het planetarium hoeft niks te gebeuren. Die draaien hun rondjes en hebben niks met onze tijdrekening te maken. Zo is het in het echte planetenstelsel ook. Het is een regenachtige dag en de tank van ons autootje is nog halfvol. We rijden naar de sportschool en de AH op Oost. Regen druilt de hele dag door.
Het nadenken over natuurkundige paradoxen is een probaat middel om in slaap te vallen. Vannacht dacht ik na over het probleem van Einstein met spiegels die reizen met de snelheid van het licht. Wat zie je in zulke spiegels? Het stond laatst in de NewScientist. Ik dacht altijd dat je er niks in zou zien. De fotonen van het licht die tegen het spiegeloppervlak slaan hebben zelf ook de lichtsnelheid. Dus kunnen ze niet - zeg maar - terugketsen, want sneller dan het licht kan niet. Met andere woorden: van een lichtflits zie je geen spiegelbeeld. Anderen denken dat het licht de spiegel nooit kan bereiken, maar dat is in het geval dat de lichtflits achter de spiegel aan vliegt. Die kan hij natuurlijk nooit inhalen. Maar leuker vind ik de paradox als het licht naar de spiegel toe vliegt en terugketst met c (c is de term voor de lichtsnelheid). Hij kan het oppervlak niet verlaten, dus niet meer zichtbaar worden. Einstein ziet dus zijn spiegelbeeld niet.
Weer anderen beweren dat de lichtdeeltjes - de fotonen - die tegen de spiegel ketsen weliswaar een extra impuls krijgen door de aanstormende spiegel, die ze normaliter met hogere snelheid doet terugketsen. Maar die energie (lichtsnelheid!) moet ergens blijven (wet van behoud van energie). Maar dat kan met de snelheid en die is al maximaal, dus wordt de impuls omgezet in een hogere, bijna oneindige frequentie en amplitude. Het licht schuift dus op in de richting van paars en ultraviolet in het spectrum. Theoretisch, want je kunt het namelijk nog steeds niet zien.
NewScientist presenteert iemand die beweert de definitieve oplossing te hebben voor het probleem. Een spiegel die beweegt met de snelheid van het licht zou volgens de paradox tegelijk zowel een oneindige intensiteit en amplitude hebben als doorzichtig zijn en helemaal geen licht meer afgeven. De nieuwe verklaring verscheen onlangs in het wetenschappelijk tijdschrift Physical Review E. Allereerst kan de spiegel die Einstein zich voorstelde volgens de auteurs niet bestaan. Er zou namelijk een oneindige hoeveelheid energie nodig zijn om een gewone glazen spiegel met de snelheid van het licht te laten bewegen. Die spiegels kun je dus niet eens maken. Tot zover niks nieuws.
Daarom ontwikkelen ze een alternatief: een spiegel gemaakt van plasma’s, oftewel mengsels van ionen en elektronen. Zulke spiegels zijn al geproduceerd in experimenten met ongelooflijk krachtige lasers. 'Wanneer deze lasers op bepaalde materialen worden gericht, creëren ze plasma’s met lokale verstoringen. Die verstoringen reflecteren licht als een spiegel en bewegen extreem snel door het plasma, bijna net zo snel als het licht.' Ik begrijp uit het artikel dat die spiegels niet twee-, maar driedimensionaal zijn. Het spiegelend oppervlak is tweedimensionaal maar erachter zou gewoon plasma zitten (en ervoor ook?). De eigenschappen van zulke spiegels kunnen variëren en de uitkomsten ook. 'In sommige scenario’s wordt het licht intens gereflecteerd. In andere scenario’s wordt het licht doorgelaten. In weer andere scenario’s vormt het licht een golf waarvan de pieken en dalen niet vooruitbewegen, maar alleen in de buurt van de spiegel op en neer gaan.' Het gaat me boven de pet waarom dat de paradox van Einstein zou oplossen. Helaas legt NewScientist dat niet uit. Er komen wel experimenten met die lasers en mogelijk nieuwe soorten van beeldvormingstechnieken. Hierboven een afbeelding uit het stuk, waar ik ook geen touw aan kan vastknopen. Ik viel in slaap met het artikel over mijn hoofd. Naar het begin van dit kwartaal
Gorinchem (24.061)

Vrijdag 01-03-2024
Poetin dreigde gisteren weer met zijn atoomwapens als er NAVO-troepen in Oekraïne gestationeerd worden.Macron suggereerde dat een dag of wat terug. Het is de typische reactie van de crimineel die de rode knop in handen heeft gekregen: zit me niet in de weg of ik gebruik geweld! Hij weet dat het westen daar doodsbenauwd voor is. Deterrence, afschrikking. Het westen heeft daar geen antwoord op. Tegelijk weten beide partijen dat het voor het grootste deel bluf is. Ook de crimineel beseft dat zijn land na de first strike met de resterende nucleaire wapens van de VS vernietigd zal worden en dat de rest van de wereld door de fallout en een nucleaire winter terug naar het stenen tijdperk gestuurd wordt. Begin dus nooit een kernoorlog, niemand wordt er wijzer van. Van afschrikking en bluf wel. Dus moeten die geloofwaardig zijn, moet de dreiging reëel zijn en derhalve moet de wereld voortdurend op de rand van de afgrond wankelen.
Vandaag is het geboefte bezig de begrafenis van de vermoorde Navalny te versjteren en een grote opkomst te verhinderen. Zo had de familie gisteren nog geen lijkwagen kunnen vinden en slaagden ze er niet in om een zaal te reserveren in een uitvaartcentrum. Daarom is de uitvaart vandaag in een kerk. Bij de kerk zijn hekken geplaatst en posters opgehangen die het maken van video’s en geluidsopnamen verbieden. Ook voert de politie patrouilles uit rond de kerk en de begraafplaats waar Navalny na de uitvaart zal worden begraven. Een maand voor zijn dood schreef hij: 'De poetinistische staat is niet duurzaam. Op een dag zullen we naar zijn plek kijken, maar zal hij er niet meer zijn. De overwinning is onvermijdelijk. Maar voorlopig moeten we niet opgeven en vasthouden aan onze overtuigingen.' Op Valentijnsdag, 2 dagen voor hij stierf, schreef hij aan zijn vrouw Joelia: 'Schat, alles wat wij hebben is als in een lied: we worden gescheiden door steden, de knipperlichten van vliegvelden, blauwe sneeuwstormen en duizenden kilometers. Maar ik voel dat je elke seconde dichtbij bent, en ik hou steeds meer van je'.
De uitvaart is waardig. De Volkskrant heeft een liveblog. Velen nemen afscheid. De Russische politie probeert de mensenmenigte onder controle te houden. Volgens Navalny’s team zijn duizenden mensen op de been. In de kerk gaat het deksel nog één keer van de kist af. De ouders van Navalny kussen voor het laatst zijn gezicht. Bij de kerk zijn westerse diplomaten aanwezig zoals de ambassadeurs van de VS en Frankrijk. De kerk waar de dienst gehouden wordt heeft volgens persbureau Reuters 'gedoneerd en enthousiast reclame gemaakt voor de oorlog in Oekraïne', waar Navalny tegen was. De tocht van de lijkwagen naar de begraafplaats vindt plaats onder grote publieke belangstelling. Langs de route die de lijkwagen aflegt, scanderen de aanwezigen teksten als ‘geen oorlog’, ‘wij zullen niet vergeven’ en ‘Rusland zal vrij zijn’. Poetin wordt ‘een moordenaar’ genoemd. Er zijn geen aanhoudingen. Voor de toegang van het kerkhof moeten de mensen door grote metaaldetectoren. Ze werpen handen aarde op de kist, nadat die in het graf is gelegd.
Joelia Navalnaya heeft met een bericht op X afscheid genomen van haar overleden man. Ze is niet bij de uitvaart omdat ze in Rusland het gevaar loopt gearresteerd te worden. Ze schrijft: ‘Ik weet niet hoe ik zonder jou verder moet, maar ik zal mijn best doen om je trots te laten zijn op mij. Ik weet niet of dat lukt, maar ik zal het proberen.' Naar het begin van dit kwartaal
Gorinchem (24.062)

Zaterdag 02-03-2024
Na 100 dagen is de kabinetsformatie op rechts een aanfluiting geworden. Geert Wilders wordt steeds zenuwachtiger. Gaat het door hem gedomineerde kabinet aan zijn neus voorbij? Hij is al tien keer over zijn schaduw gesprongen, zegt hij op X. Hij weet immers zeker dat 'het volk' een rechts kabinet wil. Yesilgöz heeft zich in een onmogelijke positie gemanoeuvreerd. Op een rijtje:
1. Een rechts meerderheidskabinet met de PVV komt er niet (Omtzigt doet niet mee);
2. Een minderheidskabinet met PVV, BBB en NSC dat de VVD kan gedogen, komt er niet (Omtzigt doet niet mee);
3. Een breed extraparlementair kabinet met CDA en SGP erbij komt er niet (wens van Omtzigt, maar CDA en SGP doen niet mee);
4. Een beperkt extraparlementair kabinet van alleen PVV, BBB en NSC komt er niet (Omtzigt doet niet mee);
5. Een centrum-links kabinet met GroenLinks/PvdA en D66 komt er niet (Timmermans is niet alleen taboe voor Wilders maar ook voor Yesilgöz);
6. Nieuwe verkiezingen worden een ramp voor VVD en NSC. Die wint de PVV.
Deze week diende Van der Plas tijdens het landbouwdebat bijna een motie van wantrouwen in tegen VVD-stikstofminister Van der Wal, omdat die volgens haar stukken achterhield. De Telegraaf brengt in een podcast van Wouter de Winter een onthutsend beeld van binnenuit, vooral over Omtzigt: onhandelbaar, 'geen land mee te bezeilen', woedeaanvallen, schreeuwen, huilen, weglopen. De Winter noemt Omtzigt 'niet mee te werken' en deze informatie 'hopeloos'. Tja, of is het gewoon riooljournalistiek à la de Telegraaf?. Over twee weken moet het verslag van Kim Putters klaar zijn. Ik vermoed dat Dilan Y. haar langste tijd als VVD-leider heeft gehad. En Omtzigt misschien ook bij NSC. Ondertussen ligt de politiek al sinds afgelopen zomer vrijwel stil.
Bij het graf van Aleksej Navalny de Borisov-begraafplaats in het zuidoosten van Moskou worden ook vanochtend nog bloemen gelegd. Vanochtend kwam zijn moeder onder politiebegeleiding terug om te rouwen om haar zoon. Ze werd vergezeld door Navalny's schoonmoeder. Samen zetten ze schaaltjes met eten bij het graf en keken ze toe terwijl mensen bloemen legden. Er ligt nu een ware bloemenzee. Ook elders in Rusland en in andere landen zijn bloemen neergelegd ter nagedachtenis aan de oppositieleider. De begrafenis was gisteren de grootste politieke manifestatie in jaren in Rusland.
Het geloei van de luchtsirense op de eerste maandagen van de maand gaat vanaf 2025 verdwijnen. Het wordt dan vervangen door een NL-alert via de mobiele telefoon. Tja, ik heb het mijn hele leven lang gehoord. De vraag is of iedereen het kan ontvangen, met name digibete ouderen. En uiteraard vertrouwt de overheid voortaan op digitale systemen die uit kunnen vallen door storingen en sabotage. Is dat verstandig? De Russen kunnen die signalen gemakkelijk jammen. Naar het begin van dit kwartaal
Gorinchem (24.063)

Zondag 03-03-2024
Wat zon en veel wolken, soms wat miezer en ruim 14 graden. Vandaag is het druk, er is een wedloop over de stadswallen. Gelukkig gaan de hardlopers via de Peterbrug over de haven en niet via het voetgangersbrugje langs ons huis over de sluis. Aan de overkant lopen ze in drommen langs op de Kriekenmarkt en de Altenawal. Daar is het smal, bij de trappen moeten ze massaal langzaam lopen. Gisteren werd in Beuningen het eerste kievitsei gevonden. De vinddagen worden geleidelijk vroeger zoals je kunt zien op de grafiek die Datagraver bijhoudt. Het is niet de vroegste vinddag; dat was 28 februari in 2019, maar nu zit er een schrikkeldag bij, dus het verschil is niet groot. Je ziet dat het tienjarig gemiddelde alleen maar daalt. Het eerste kievitsei mag worden gevonden, maar niet geraapt. Vroeger overhandigde men het aan de commissaris van de koningin, weet ik nog. Vanmiddag gaan we naar de verjaardag van Zaila, die twee jaar wordt. Nikita & Denzel vieren het in de Roots Dance Studio waar Nikita in haar v rije tijd les geeft.
Voor de tweede dag op rij staat er een lange rij mensen voor het Borisov-kerkhof im Moskou. Ze willen eer betuigen aan het graf van Navalny. Helden in een gewelddadig, crimineel regime. Naar het begin van dit kwartaal
Gorinchem (24.064)

Maandag 04-03-2024
Er staan de laatste dagen weer vaak grafieken en curves boven het blog en dat is niet voor niets. Allereerst de update over februari van de gemiddelde wereldtemperatuur, gemeten in de lagere atmosfeer door satellieten. Die blijft voor de vijfde maand absurd hoog: een bizarre +0,93 graden Celsius boven het gemiddelde van de periode 1991 - 2020! Dat was het in oktober 2023 ook, in november was het +0,91, in december +0,83 en in januari +0,86 graden. Zonder twijfel is de uitkomst mede door de invloed van de El Niño zo hoog. De piek daarvan is veel hoger dan die van de zware El Niño van 1998, waaruit je kunt afleiden dat de opwarming sindsdien volgens de trend doorging en zelfs versnelde. De lineaire opwarmingstrend sinds 1979 is nu +0,15 graden per 10-jaarsperiode, te verdelen over +0,13 boven de oceanen en +0,20 graden boven de continenten. Klimaatverandering dreigt niet alleen, het is er al.
Gistermiddag een gezellige 2e verjaardag van Anna's achterkleindochter Zaila in Roots Dance Studio vlakbij de A15 op Oost. Veel kinderen; op zo''n feest merk je niks van het teruglopend kinderaantal in Nederland. Alleen was de muziek snoeihard. Dat deden we vroeger zelf ook het liefst, maar gesprekken kun je nauwelijks voeren. Na een kleine twee uur haakten we af. Hier een drietal foto's.
Gisteren was het een heerlijke lentedag. Die bracht het derde warmterecord van het jaar. Het was in De Bilt officieel de warmste 3e maart ooit gemeten. Het vorige record was 14,7 graden en werd gemeten in 1930. Uiteindelijk werd het gistermiddag zelfs 15,9 graden. Het is vandaag met 12 graden frisser dan gisteren. Op verzoek van Anna ga ik naar de kapper. Naar het begin van dit kwartaal
Gorinchem (24.065)

Dinsdag 05-03-2024
Inderdaad, alweer een grafiek en een belangrijke. Hij stond vorige week prominent in een rubriek in de Financial Times. De Climate Graphic of the Week. Niet de eerste de beste krant. De grafiek is van het Europese klimaatbureau Copernicus en hij toont dat de gemiddelde wereldtemperatuur voor het eerst een jaar lang de grens van 1,5 graden opwarming doorbrak (sinds het begin van de industriële revolutie). '..the global mean temperature for February 2023 to January 2024 was the highest ever at 15.02 C, 1.52 C above the 1850-1900 pre-industrial period. (...) January marked the eighth month in a row that temperatures were the warmest on record, as heatwaves, wildfires and flooding devastated many regions. Last year was the hottest on record.' De wereld moet in het jaar 2100 onder die grens zien te blijven, volgens het Parijse klimaatakkoord uit 2015. De overschrijding werd door klimatologen eerst rond 2050 verwacht, later in 2033 (door Copernicus) en is dus nu een feit. Daarbij komt dat wereldwijd de oppervlaktetemperaturen van het zeewater hoger zijn dan ooit gemeten. Zie de presentatie hieronder - ook van de FT - en late vooral op het stukje curve van 2024 rechtsboven:
Het ziet er somber uit en dat doet het al decennia. Is er nog hoop? Serieus? Klimaatactiviste Gretha Thunberg schreef in haar juist verschenen Klimaatboek: 'We hebben dringend behoefte aan hoop. Maar hoop draait niet om doen alsof alles weer goedkomt. […] Voor mij is hoop niet iets wat je wordt geschonken, maar iets wat je moet verdienen, moet creëren.'
Het is een grijze dag met druilregen. In de ochtend ga ik alleen sporten. Het RIVM waarschuwt tegen mogelijke voedingssupplementen als ibogaïne (tabernaniboga iboga) dat zonder veel succes wordt gebruikt bij chronisch alcoholisme, huperzia serrata uit de wolfsklauwfamilie en ashwagandha, dat in veel online drogisterijen te koop is. Je kunt er goed ziek van worden en sommige zijn zelfs dodelijk. Ik toets de namen in Google en - verdraaid - je kunt ze zo bestellen. Naar het begin van dit kwartaal
Gorinchem (24.066)

Woensdag 06-03-2024
Het succesverhaal van de James Webb ruimtetelescoop gaat onverminderd verder. Men poogt steeds verder terug in de tijd te kunnen zien in de richting van de oerknal. Onlangs werd de telescoop gericht op Abell2744 (ook wel Pandora's Cluster genoemd), een gigantische sterrenhoop op vier miljard lichtjaren afstand. De enorme, geconcentreerde zwaartekracht van de cluster vervormt de ruimte tot een grote zwaartekrachtlens, waarmee objecten ver achter Abell2744 beter zichtbaar zijn. Zo ontdekte men acht extreem zwakke sterrenstelsels, die je anders niet kon zien, zelfs niet met alleen de geavanceerde Webb-telescoop. Opmerkelijk: ondanks hun geringe lichtintensiteit produceerden deze stelsels veel meer ultraviolet licht dan verwacht; wel viermaal zoveel. Men denkt dat deze intensieve straling afkomstig is uit het tijdperk van de re-ionisatie van het heelal, waardoor het heelal doorzichtig werd.
Vroeger dacht ik dat zichtbaar licht al mogelijk was na het ontstaan van de Kosmische Achtergrondstraling (de CMB), 380.000 jaar na de oerknal, toen het heelal voldoende afkoelde om de ziedend hete plasme om te zetten in stabiele atomen. Maar die atomen - vooral waterstof, helium en wat lithium - bestonden nog in de vorm van electrisch geladen ionen, atoomkernen met meer of minder electronen (minder = kation = positieve lading, meer = anion = negatieve lading). Astronomen noemen die periode na de CMB de 'dark ages' van het heelal. Er waren nog geen sterren en sterrenstelsels gevormd en de verder afkoelende CMB was het enige 'licht'. Pas na 150 tot 800 miljoen jaar slaagde de geïoniseerde materie erin tijdens her-ionisatie voldoende samen te klonteren tot de eerste primitieve sterren en - vanaf 400 miljoen jaar - de eerste sterrenstelsels van waterstof en helium. Die begonnen de ultraviolette straling - het eerste licht! - uit te zenden die de onderzoekers met de Webb nu waarnemen. We komen steeds dichterbij het begin.
Grappig, de sluiers van poollicht die we in deze tijd soms kunnen zien (door de toegenomen zonneactiviteit) zijn niets anders dan dit soort licht, door de zonnedeeltjes die botsen op de atomen hoog in de aardatmosfeer en ze ioniseren en re-ioniseren. De energierijke deeltjes stoten electronen naar een hoger energieniveau, waarna ze bij terugvallen naar een lager energieniveau quantumpakketjes licht uitzenden. Dat zien we als Aurora borealis.
Wolken en zon na een uurtje mist, een frisse lentedag. Een korte wandeling gemaakt. Terwijl de kabinets(in)formatie opnieuw lijkt te stagneren grijpt de meerderheid van domrechts in de Tweede Kamer steeds vaker de macht. (Ik spreek voortaan van domrechts in navolging van Thomas van der Dunk).
Met veel moeite kwamen de EU-commissie en het Europarlement een sterk afgezwakte Natuurherstelwet overeen, die de kwakkelende natuur moet redden. Alleen de lidstaten moeten er nog over beslissen; geen unanimiteit vereist, een formaliteit. Het is beter dan niks. Wat doen BBB en NSC? Die laten met ruime meerderheid een motie aanemen die wil dat onze regering in Brussel tegenstemt. Een laatste en vruchteloze poging tot blokkade, waar zelfs regeringspartij VVD voor stemde. De demissionaire regering en de eigen VVD-minister zijn vóór die herstelwet, hoewel de minister in haar rol als kamerlid voor de motie (en tegen de wet) stemde. Van der Wal stemde dus tegen haar eigen beleidsdoelen om de natuur te verbeteren en tegen het voornemen van Nederland om die afgezwakte wet te steunen. Dezelfde spagaat die de partij bij de Spreidingswet maakte. Nederland slaat een modderfiguur, het kan de natuurherstelwet niet eens tegenhouden en oogst alleen maar irritatie in Europa. Domrechts aan de macht. Naar het begin van dit kwartaal
Gorinchem (24.067)

Donderdag 07-03-2024
Niet eerder werd er in Nederland zo veel stroom geproduceerd als in 2023: 120 miljard kilowattuur. Dat is één procent meer dan het jaar daarvoor. Vrijwel de helft bestond uit duurzame stroom. Vooral windenergie is verder gegroeid, terwijl de daling bij fossiele bronnen verder doorzet. Er is vorig jaar 35 procent meer windenergie geproduceerd. Dat komt met name door het opvoeren van het vermogen van windmolens op zowel land als ter zee. Ook de sterke opkomst van zonnepanelen is terug te vinden in de cijfers. Met zon werd vorig jaar 24 procent meer stroom opgewekt. De stroomopbrengst van biomassa is juist teruggelopen, met name doordat er minder is gestookt. De productie van fossiele energie is met 12 procent gedaald. Vooral met kolen werd minder energie geproduceerd, zo'n 38 procent minder. Dat komt doordat wind- en zonne-energie vergeleken met kool veel goedkoper is geworden. De export van stroom is ook naar recordhoogte gestegen. Het grootste gedeelte ging naar Duitsland, België en het VK.
De NRC vraagt zich deze week af of het meest pessimistische scenario van opwarming intussen aan de kant kan. Dat heet Rcp 8,5. Daarin kan de opwarming oplopen naar een fatale 2,5 tot 4,8 graden. De afkorting staat voor Representative Concentration Pathway. De Rcp's worden voor het eerst gebruikt in het vijfde IPCC-rapport (2014). Sindsdien zijn ze verfijnd en verbeterd. De conclusie van NRC luidt: 'Dat de aarde flink opwarmt, zoals rcp8,5 voorspelt, is dus nog steeds mogelijk, hoewel de kans klein is. Tegelijkertijd is de vooruitgang in klimaatbeleid niet te negeren. In het meest gunstige geval, als alle tot nog toe gestelde doelen worden gehaald, zal de opwarming van de aarde uitkomen op 1,8°C, volgens Climate Action Tracker'. In 2100, bedoelt men. Te hoog en zonder eventuele kritische kantelpunten en een mogelijk hogere klimaatgevoeligheid.
Ook bij ons energiegebruik is een verschuiving te zien. In 2023 gebruikten we iets meer stroom maar flink minder gas. We betalen nu voor gas en stroom 195 euro per maand. Koken doen we vooral met de airfryer en de electrische oven, minder met het gasfornuis. Natuurlijk hielp de zachte winter ook flink mee. Verder eten we de laatste tijd beduidend minder vlees, nu er betere plantaarige alternatieven in de winkel liggen. Vleeswaar op de boterham hadden we al eerder afgeschaft; daar doen we nu vaker humus of pindakaas op.
De dag vangt stralend aan. De lente breekt volop uit. Eindelijk een einde aan al dat vocht. De oostenwind maakt het fris en er komt later meer bewolking dan gisteren. Op de haven zijn de spuitgasten nu bezig met het remmingwerk en de kademuren. Op tijd zien we de glazenwasser; door al dat spuiten heeft zijn werk bij ons even geen zin. Bovendien wordt binnenkort de gevel van ons pand schoongemaakt. We gaan op Oost naar de sportschool en de AH. Vervolgens loop ik door de binnenstad naar het stadhuis om mijn nieuwe ID-kaart op te halen. Geldt tot in 2034. In elk geval vandaag genoeg beweging gehad. 's Middags krijgen we bezoek van Barbara en Zaila. Na een bevalling te hebben gedaan komt ook Nikita erbij. Naar het begin van dit kwartaal
Gorinchem (24.068)

Vrijdag 08-03-2024
Deze foto neem ik over van de ESO, de European Southern Observatory, omdat ik hem zo mooi vind. Hij toont de planeetvormende schijf van een jonge ster in het sterrenbeeld Taurus op 500 lichtjaren afstand. Het is een foto die is samengesteld met de gegevens van twee instrumenten. De gele kleur correspondeert met infraroodwaarnemingen die verkregen zijn met het Spectro-Polarimetric High-contrast Exoplanet REsearch (SPHERE)-instrument van ESO’s Very Large Telescope (VLT). De blauwe gebieden komen overeen met waarnemingen met de Atacama Large Millimeter/submillimeter Array (ALMA), waarin ESO partner is. De opname komt uit een van de grootste inventarisaties van planeet-vormende schijven die ooit zijn gedaan. De onderzoeken omvatten waarnemingen van meer dan tachtig jonge sterren, waar omheen mogelijk planeten aan het ontstaan zijn. Tot op heden zijn meer dan vijfduizend exoplaneten ontdekt, die om andere sterren dan de zon draaien, vaak in stelsels die duidelijk verschillen van ons eigen zonnestelsel.
Domrechts stemde in de Tweede Kamer deze week, op initiatief van de VVD (of hoort die tegenwoordig ook bij 'domrechts'?), voor de bouw van vier kerncentrales. Grote kerncentrales. Niet alleen domrechts overigens, ook Volt stemde voor. Alle vier centrales moeten al vanaf 2040 energie gaan leveren. Iedereen kan weten dat het helemaal niet mogelijk is. In een analyse stelde netbeheerder Tennet in opdracht van het minsterie van economische zaken dat er met moeite hooguit één kerncentrale past in Zeeland (Borssele) en géén op de Maasvlakte. Daar wil het demissionaire kabinet namelijk al waterstofinstallaties bouwen. BBB wil er zelfs één in Groningen, mits er minder windmolens worden gebouwd.
Vandaag een zonovergoten dag. Door de noordoostenwind wordt het niet warmer dan hooguit een graad of tien. In de ochtend zitten we in de dampen van de spuitgasten van de haven. Als ze bij ons klaar zijn, spuiten ze voorzichtig met een zachte straal de ramen, muren en deuren van ons gebouw schoon. Nog steeds hebben we niets gehoord van Unigarant, onze bootverzekeraar, over de schadeclaim voor het verrotte dek van Dulce. Dat is vervelend want het vaarseizoen nadert. We dienden formeel op 1 februari de claim in. Nu zijn we bijna zes weken verder zonder ook maar iets gehoord te hebben. Op de website staat: 'Normaal gesproken krijgt u binnen vijf werkdagen een reactie'. Bij het tabblad voor watersportverzekeringen staat: 'Het is drukker dan normaal. Wij doen ons best om binnen 10 werkdagen te reageren' (vetgedrukt door Unigarant). Onze tussenspersoon VLC & Partners stuurde ze op 26 februari een reminder. Vanmiddag belde ik dus maar eerst met de verzekeraar. Na een keuzenmenu krijg ik iemand aan de lijn die zegt onze schadeclaim niet te kunnen vinden! Ik ben VLC. Die gaan er nu op hoge poten achteraan. Naar het begin van dit kwartaal
Gorinchem (24.069)

Zaterdag 09-03-2024
De zoveelste malle situatie in de vorming van een kabinet op rechts met de PVV. Ogenschijnlijk zijn de vier partijen eruit om een extraparlementair kabinet te gaan vormen. Maar wát is dat precies? 'Als alle partijen ministers leveren en strakke afspraken maken over financiën, buitenland en rechtsstaat, is er in feite gewoon sprake van een meerderheidskabinet', schrijft De Volkskrant vanochtend. Dat was expliciet nooit de bedoeling van NSC en VVD. Terwijl Wilders ondertussen op voorhand driekwart van zijn partijprogramma in de ijskast heeft gezet, is er nog geen begin gemaakt met de inhoud van een regeerakkoord. Wat moet er met de uit-de-handlopende staatsfinanciën gebeuren? Met de steun aan Oekraïne? Met de expats waar het bedrijfsleven niet zonder kan? Het schijnt dat Omtzigt al is begonnen met het polsen van potentiële bewindspersonen in kringen van oud-CDA'ers. 'Hoe Omtzigt zich tot zijn eigen ministers wil gaan verhouden, is een van de grote vragen waar Putters nog antwoord op moet zoeken'.
Maandag gaan de vier partijen weer in landgoed De Zwaluwenberg zitten. Wilders gaat ondertussen ongenaakbaar zijn gang. Eind april zal hij hij Cpac-Hungary conferentie toespreken, een ultraconservatief evenement in Boedapest waar populistische en extreemrechtse politici van het Vlaams Belang en de Spaanse partij Vox zijn uitgenodigd. De Hongaarse premier Viktor Orbán is de hoofdgast en Geert wordt prominent naast hem aangekondigd. 'Een hele eer' zegt hij op X. Wie weet is hij dan al premier, hoewel die kans klein lijkt.
Ondertussen staan BBB, VVD en NSC er slecht voor in de jongste peilingen. In de laatste Peilingwijzer: PVV 50 zetels (plus 13), de VVD 18 (min 6), NSC 10 (min 10), BBB 7 (0). Ze worden electoraal overvleugeld door de PVV, die als enige van het lange formatieproces profiteert. Dat zal Geert willen verzilveren, hetzij in een regeerakkoord, hetzij in nieuwe verkiezingen. Wie met Wilders in zee gaat, komt er slecht vanaf, leerden we van Rutte 1. De partijen ter linkerzijde zien het allemaal nogal apathisch aan. Ze roeren zich nauwelijks. NRC-columnist Tom-Jan Meeus suggereert in zijn nieuwsbrief 'Machtige Tijden' dat de oppositie - GL/PvdA, D66, PvdD, Volt etc. - er goed aan zou doen om een voorbeeld te geven en alvast een schaduwkabinet te formeren dat de strijd aan kan gaan. 'Manifesteer je als blok tegenover Wilders en een kabinet met de PVV''. Een prima idee, ontleend aan een recent voorstel van Joop van den Berg, oud-directeur van het wetenschappelijk instituut van de PvdA, om de passiviteit van de oppositie te doorbreken.
Opnieuw een lenteachtige dag, fris door de noordoostenwind. Er is meer bewolking dan gisteren en het wordt 13 graden. Voor de dochter van een buurvrouw op het Eind vonden we via via een betaalbare kamer in Haarlem, vlakbij het station. De drukkerij van Rob Stolk waar ze komt te werken in Amsterdam is per spoor goed bereikbaar. Een gelukstreffer. Moeder en dochter zijn er erg blij mee. Vandaag vieren we de verjaardag van Esri (19). Naar het begin van dit kwartaal
Gorinchem (24.070)

Zondag 10-03-2024
Dit plaatje is bedoeld om u ongerust te maken en te beseffen dat zich wel erg rare ontwikkelingen in ons klimaat voltrekken. De afgelopen maand februari was de negende maand op rij dat wereldwijde warmterecords sneuvelden. De ene na de andere. Dat begon al voordat de opwarmende effecten van de huidige El Niño zich voluit ontplooiden. De afgelopen winter was de warmste ooit gemeten in Canada: 5,2 graden boven wat normaal was in de laatste dertig jaar. Dat geldt ook voor de VS, maakte NOAA dezer dagen bekend.
Tijdens de achter ons liggende drie wintermaanden zijn de oceanen op de noordelijke hemisfeer verontrustend warm gebleven. In de komende decennia zullen de oceanen definitief veranderen in permanente warmwaterbakken met wereldwijde gevolgen: nog meer zeespiegelstijging, heftiger orkanen, water dat voor het meeste zeeleven te heet is. 'If we continue down the path we’re on, Earth’s oceans may be irrevocably transformed over the next several hundred years', zegt de paleo-oceanografe Sandra Kirtland Turner van UC Riverside in Californië deze week in The Atlantic. 'The oceans we knew are already gone'. De opwarming versnelt en is niet langer lineair, alsof de klimaatgevoeligheid is toegenomen. Dat kan gebeuren wanneer het weerkaatsend vermogen, de albedo van de aarde, afneemt. Oorzaak: het snelle afsmelten van het zeeijs aan de polen (polaire amplificatie). De instorting van de Atlantic Meridional Overturning Circulation (AMOC), waar de warme golfstroom een deel van is, is een van belangrijkste kantelpunten in het klimaatsysteem van de wereld. Ik heb dat op deze plaats al meer dan 15 jaar lang betoogt. Aanvankelijk schatte men in dat het rond AD 2300 zou gebeuren, maar recente studies wijzen uit dat het veel eerder kan zijn. Misschien beleven we de aanzet tot die omslag nu wel. Europa moet rekening houden met een nieuwe ijstijd, zegt BNR op zijn website. Ze kunnen het altijd leuk brengen, die commerciëlen.
Het is zondagochtend. Terwijl ik dit schrijf hoor ik uit de kamer dat Anna naar Rick Nieman kijkt. Mona Keyzer leutert over asielzoekers in Nederland. "Ik weet niet waar ze heen moeten', zegt ze. alsof dat ons grootste probleem is.
Gezllige verjaardag van Esri, gisteravond. We lopen er heen en later brengt ze ons even met de auto thuis. Het is een omfloerste zondag waarop niks gebeurt. Naar het begin van dit kwartaal
Gorinchem (24.071)

Maandag 11-03-2024
De hele dag regen, een lagedrukgebied trekt over het land. Op sommige plaatsen in het oosten en het zuiden kan wel 30 mm vallen. Ik bel meteen 's ochtends de tussenpersoon van onze bootverzekering. De medewerkster vertelt dat ze al contact had met Unigarant. Ze konden niet verklaren waar onze schadeclaim was gebleven. Ze hebben een nieuw dossier aangemaakt en beginnen deze week meteen met de afhandeling. We gaan sporten en boodschappen doen. 's Middags gaat Anna op bezoek bij onze bovenste buurvrouw. Na drie uur wordt de regen eindelijk minder, maar later op de avond zal het weer harder gaan regenen. Even na vieren belt er iemand van een bureau, nautisch expertisebureau Vijzelaar in Alkmaar, dat op verzoek van Unigarant de schade aan de boot gaat opnemen. Daar mag ik bij zijn. Nu komt er vaart in.
Het is de elfde dag na de begrafenis van Navalny. Nog iedere dag komen mensen op het kerkhof langs om bloemen op zijn graf te leggen. Iedere dag worden ze ook weer weggehaald.
Europa is niet voorbereid op de snel groeiende klimaatrisico's, zegt het Europese klimaatagentschap EEA in een nieuw analyserapport. We passen ons onvoldoende aan. Europa warmt sneller op dan de rest van de wereld en veel effecten van die opwarming zijn nu al merkbaar: overstromingen als die in 2021 in Duitsland, België en Nederland, wekenlange hittegolven en recordtemperaturen, mislukte oogsten door langdurige droogte. Extreme hitte, droogte, natuurbranden en overstromingen zijn een groot gevaar voor voedselzekerheid en financiële stabiliteit, schrijft NOS Nieuws erover. En tegen dat gevaar moet Europa zich beter wapenen, waarschuwen de wetenschappers die aan de analyse meewerkten. Vooral in Zuid-Europa, laaggelegen kustgebieden (waaronder Nederland) en overzeese Europese gebieden zijn de gevaren groot, blijkt uit de analyse. Dat is niets nieuws, het IPCC schreef het al over het sneller opwarmen van Europa in zijn VIe Assesment Rapport van augustus 2023. Onder Timmermans waren de Europese ambities groot, maar de Greendeal is een een slap aftreksel geworden. Brussel is verlamd door de komende verkiezingen en de angst voor populistische overwinningen. 'Waarom hebben we altijd een crisis nodig voor we gaan handelen?', zegt een van de onderzoekers tegen de NOS. Tja, zo is het meestal met den mensch, die kijkt niet verder, de wal moet eerst het schip keren als het kalf verdronken is, zo ongeveer. Naar het begin van dit kwartaal
Gorinchem (24.072)

Dinsdag 12-03-2024
Vandaag naar Utrecht. Vertrek om halftien. De laatste rest file staat waar de A27 van 3-baans naar 2 banen versmalt. Om tien over tien zijn we bij Tine in Nieuwegein. Huis zonder Paul, al bijna een halfjaar. Liever koffie in de stad, zegt Tine. We laten de auto staan en nemen vlakbij de sneltram. Op de Graadt van Roggenweg langs weer nieuwe, ongeïnspireerde hoogbouw. De tram duikt de oude Daalsetunnel in. Die heb ik nog zien bouwen, zeg ik, maar volgens Tine kan dat niet. Ja, zeg ik, ik kwam naar Utrecht in 1965, toen hadden we nog het oude station en de stationswijk. Liep je dan naar de binnenstad dan kwam je langs dat prachtige Jugenstilgebouw van levensverzekering De Utrecht. Alles gesloopt voor Hoog Catharijne. Klopt, zegt Tine, maar de tunnel was er al wel. Zou het? We weten het niet zeker meer. De tram stopt onder het station en we lopen door het glanzende spiegelparadijs voor consumenten en zwervers naar de Oudegracht. Bij de ingang van HC zit een ineengedoken, langharige blanke jongen bij een bordje. 'Ik heb honger' staat erop. Honger is eeuwig, dat was bij het oude HC ook al zo. Het Vredenburg is klein en tezeer ingesloten door oude en nieuwe bebouwing. Alle allure is weg. Op de hoek van de Oudegracht en de Zakkendragerssteeg drinken we koffie op de plek waar vroeger Alberts' Corner was. Langs het raam lopen grijze paren voorbij en jonge studenten van dezelfde leeftijd als toen ik de stad leerde kennen.
We treffen het met het weer, de hemel is grijs maar het blijft droog. We splitsen ons. De dames gaan voor een nieuwe spijkerbroek voor Anna naar De Rode Winkel in de Lange Elisabethstraat, de enige plek waar ze volgens Anna goede spijkerbroeken verkopen. Vroeger kocht ik daar mijn doktersjassen; die zijn allang uit het assortiment. Ik ga zelf naar de bekende winkel voor hoeden en petten, Jos van Dijck in de Bakkerstraat. Daar koop ik al bijna vijfentwintig jaar mijn petten. Ze hebben er nog een, 'maar we krijgen weer nieuwe!' verzekert de verkoopster me. De pet is een maatje te groot, maar als ik hem op zet zit hij toch goed. Ik keer terug naar De Rode Winkel waar Anna inmiddels een goede jeans aan heeft. Meestal koop ik dan een overhemd, maar nu nietl Er liggen wel leuke maar ze zijn veel te duur, 190 euro per stuk! Gaan we niet doen.
We lopen met zijn drieën de Steenweg af. Winkels uit onze tijd zijn er nauwelijks meer. Ja, de Hema, die is er nog, Druk is het niet op deze dinsdag. Op de hoek met de Choorstraat begeven de dames zich verwachtingsvol in het boetiekje dat Cocon heet. Ik loop door naar de Vismarkt, waar het antiquariaat Aleph vol boeken en cd's me alle lust ontneemt ooit nog eens een boek te kopen. Volkomen zinloos. Geldt ook voor CD's. Hier is niets wat niet verschenen is, denk je bij jezelf. Alles wat je zou willen hebben is hier al. Ik aarzel bij een cd-cassette met alle vioolsonates van Beethoven. Die heb ik al in een andere uitvoering. What is the use of it? Als je die koopt dan ligt hij hier binnen een jaar of tien weer. Ik dwaal tussen de hoog opgetaste rijen en stapels door naar de uitgang en verlaat onverrichterzake de winkel. Later bedenk ik natuurlijk dat het onzin is, ik zou er misschien nog jaren van kunnen genieten, maar het is te laat.
Even verder is de enorme kookwinkel van Betsie die alles heeft op culinair vlak, bijna even ontmoedigend als het antiquariaat een eindje terug. Ik vind er Tine en Anna die ook niks kochten. Noch hier, noch bij Cocon. Ouderen zijn slechte consumenten. We gaan als vanouds lunchen bij Graaf Floris. Tine fotografeert ons op de Vismark). We vinden een tafeltje achterin (foto hier). Ernaast zit een eenzame grote, oude man een boek te lezen, dat hij zozeer dubbel vouwt dat het op een marteling lijkt. Dit zou verboden moeten worden, net als dierenmishandeling. Anna kijkt me aan en ik zeg er niets van.
De lunch is lekker en gezellig. Natuurlijk missen we Paul erbij; het voelt onaf en incompleet maar toch zijn we blij onze vriendin weer gezien te hebben. Even na twee uur zijn we met de sneltram weer in Nieuwegein. Net voor de files via de A2 en de A27 naar Gorcum terug. Een paar uur later begint het te miezeren. Naar het begin van dit kwartaal
Gorinchem (24.073)

Woensdag 13-03-2024
Hebben we - ruim dertig jaar na het einde van de Koude Oorlog - in 2022 weer op de rand van een kernoorlog gebalanceerd? Dat vraagt New York Times-journalist David Sanger zich af in zijn boek 'New Cold Wars' dat volgende maand uitkomt. De Volkskrant schrijft er vanmorgen over en ook over 'The Return of the Great Powers' van CNN-veiligheidsdeskundige Jim Sciutto dat deze week verscheen. Sinds de eeuwwisseling bewegen de grootmachten zich in de richting van een herschikking van de machtsverdeling in de wereld. Een nieuwe systeemoorlog, zou Ingo Piepers het noemen, even fataal als onvermijdelijk. Ik schreef daar onlangs over.
Zo'n oorlog met allesvernietigende kernwapens wordt niet noodzakelijk gevoerd, want nog steeds is de afschrikking groot, maar er kan wel mee gedreigd worden en dat is bepaald gevaarlijk. Het gebeurde in oktober 2022 door Poetin die toen zei dat Rusland ‘alle beschikbare middelen’ zou gebruiken om Russisch grondgebied te verdedigen. De bezette gebieden in Oekraïne rekende Moskou toen expliciet ook tot Rusland. Het Kremlin verloor toen veel terrein, met name bij Charkiv en Cherson, en dreigde een tactisch kernwapen in te zetten. Als Moskou inderdaad zo’n vergaande militaire stap zou nemen, moest de Amerikaanse vergelding dramatisch zijn, aldus Amerikaanse regeringsfunctionarissen. In dit geval werkte de afschrikking kennelijk. President Joe Biden stuurde CIA-directeur William Burns naar Turkije voor een onderhoud met diens Russische collega. Amerika’s hoogste militair, chef-staf Mark Milley, belde zijn tegenhanger in Moskou, generaal Valeri Gerasimov. Ook zou de steun van China ingeroepen zijn om het Kremlin te ontmoedigen naar kernwapens te grijpen, De Russen bonden in, verlieten Cherson en kozen voor een langdurige stellingenoorlog.
De nucleaire ramp werd eind 2022 weliswaar afgewend - maar niet voorgoed. Vandaag zei Poetin in een interview op de nationale televisie dat Rusland klaar is om kernwapens in te zetten als zijn bestaan, soevereiniteit en onafhankelijkheid bedreigd worden. Maar hij zei erop te rekenen dat de VS niet te ver zal gaan en beschreef Joe Biden als een president met een lange ervaring, die terdege de grote gevaren snapt van escalatie. Daarom zal de wereld niet snel naar een nucleair conflict afglijden. Poetins bluf en dreiging zijn duidelijk en klassiek. 'Vanuit militair-technisch oogpunt staan we klaar'. Tactische kernwapens waren tot dusver op het Oekraïens slagveld niet nodig. Zijn herverkiezing als president begint over een paar dagen.
Hoe zal het verder gaan met het verdeelde Europa? Zal Rusland ook de defensie van de EU en de NAVO op de proef stellen, direct of indirect, in de komende jaren? ‘Oorlog is terug in Europa en is opnieuw de arbiter geworden van ambities en disputen op dit continent’, zegt Francois Heisbourg vandaag in De Volkskrant. Hij is verbonden aan het International Institute for Strategic Studies (IISS). 'Het kan wreed uitpakken, bijvoorbeeld als Trump de verkiezingen wint, of als Poetin de oorlog uitbreidt. Of zachter, als de Amerikaanse draai naar de Pacific een geleidelijker proces wordt. Maar in alle gevallen zijn we meer op onszelf aangewezen, strategisch en in termen van budget'. Wat ik interessant vind is dat Heisbourg zegt dat veel landen, met name in het mondiale Zuiden, Rusland niet eens als grootmacht zien. 'Rusland vergaart geen grote mondiale macht als het wint.' Inderdaad, dat is het maffe van Poetins oorlog, dat hij uit een voorbije tijd lijkt te stammen, die van koloniale oorlogen. Is het dan wel een systeemoorlog? 'Als Rusland de oorlog in Oekraïne wint, verhuist het probleem naar ons', stelt Heisbourg, want 'als een EU-land ten onder gaat, ontploft de EU. (...) Estland is niet groot. Als de Amerikanen zich terugtrekken, zoals ze wellicht doen onder Trump, zouden Frankrijk of Groot-Brittannië dan echt kernwapens inzetten bij een invasie van Estland? Ik weet het niet, maar Poetin zal het zich afvragen.’ Het is duidelijk: Heisbourg twijfelt daaraan.
De essentie is dat Europa en de VS zwak zijn door interne verdeeldheid. Macron is dan wel gedraaid en zou nu NAVO-troepen willen inzetten in Oekraïne, maar kanselier Scholz wil dat beslist niet. Zelfs de Taurusraket durft hij niet te leveren. Als Kyiv niet méér steun krijgt zal het sowieso de oorlog verliezen. De wereld ziet ook hoe zwak de VS is bij het intomen van Netanyahu in Gaza. Dat moedigt Poetin aan. Volgens Piepers is de nieuwe systeemoorlog er al. In zijn boek 'Van verval naar vernieuwing' (Politica Scripta, 2023) becijfert hij de duur van die oorlog, die volgens hem met de Russische inval in Oekraïne van start ging, op ongeveer 17 jaar. Dat is tot om en nabij 2040 - in een opwarmende wereld, die in dezelfde tijd linea recta afstevent op toenemende klimaatrampen, die op zich tal van nieuwe conflicten en vluchtelingenstromen teweeg zal brengen.
Een grijze, stille dag. Gisteravond kregen via Messenger bericht dat een schade-expert van Vijzelaar Expertise morgen om 13 uur op de werf in Numansdorp zal zijn om de schade aan onze Dulce op te nemen. Daar gaan we dan naar toe. Naar het begin van dit kwartaal
Gorinchem (24.074)

Donderdag 14-03-2024
Vandaag naar de werf in Numansdorp voor het gesprek met de expert voor bootschades van Vijzelaar Expertise. Ik was er om kwart voor één. Dulce bleek terug geplaatst te zijn naar de grote loods en ze was afgedekt met plastic. De expert kwam om tien over één. Ik voerde het gesprek samen met Benno, die duidelijk is over wat zijns inziens de oorzaak is van het rottende dek: uitgebreide lekkage door teakdek, dat in 2002 in opdracht van de toenmalige Jeanneau-importeur Rob Krijgsman veel te haastig en ondeskundig was gelegd. De circa duizend schroefjes in de polyester deklaag had men domweg laten zitten. Ze waren er niet uitgehaald en de gaatjes waren niet met kit gedicht. Er zaten ook geen dopjes van teak op. Op termijn wordt het dek lek als een gieter. Ik geloof dat de expert dat ook wel zag, toen we later aan boord gingen kijken. Wolter-Jan kwam er ook bij staan. Het kan zijn dat hij de lekkage voor een deel ook toeschrijft aan slijtage van het ruim 20 jaar oude dek. Maar voor welk deel? Een vervelend punt en daar kun je dan over gaan dimdammen. Ik geloof niet zo in dat slijtageverhaal; zoalng de gelcoat onder het teak intact blijft, lekt het dek niet. Het zijn juist de duizend schroefgaatjes waardoor de coating ging lekken. Op verzoek zoek ik later thuis wat foto's van het dek op. Natuurlijk hadden we de toestand ervan tevoren niet nauwkeurig vastgelegd, want de schade - die we niet verwachtten - bleek pas toen het eraf gehaald was. Nu moeten we afwachten. Het concept-rapport krijgen we niet te zien. Dat stuurt hij naar Unigarant, die het waarschijnlijk aan ons doorstuurt.
Rusland blijkt onlangs te zijn begonnen met het op grote schaal storen (jammen) van de signalen van het GPS-systeem. Opmerkelijk. Het GPS-signaal in de Baltische staten en Polen viel bijna 48 uur lang helemaal weg. Tot in Duitsland ontstonden problemen met het bepalen van de precieze locatie. Een woordvoerder van de Europese Commissie wijst in De Volkskrant op de grote impact van GPS-verstoringen. ‘Uitgebreide gps-jamming kan potentieel het functioneren van economieën, burgers en overheidsbeleid verstoren. De luchtvaartsector wordt bijvoorbeeld rechtstreeks getroffen'. En natuurlijk de militairen van NAVO-landen, die GPS ondermeer nodig hebben voor precisiegeschut en raketten. Deskundigen zeggen dat het epicentrum van het jammen in de enclave Kaliningrad zit. Wat beoogt het Kremlin daarmee? Voorbereiding voor een aanval op Europa? Volgens militair deskundigen gaat het erom de NAVO te jennen. ‘Ze willen met de verstoring testen wat de NAVO-landen voor tegenmaatregelen nemen.’
Hoe gaatsie met de formaatsie? Wilders gaf het premierschap op, net als de drie andere fractieleiders. Waarschijnlijk hield Omtzigt het tegen. Dan geen van allen. Tom-Jan Meeus zegt op X: '‘Vanaf nu is regeren onder de PVV in Den Haag niet langer taboe. Dat is de echte stap die deze week gezet is’. FvD-senator Paul Cliteur is boos op X: 'Schandalig. Dus je kan een geweldige verkiezingsoverwinning behalen en dan kaltgestellt worden door de manipulatieve spelletjes van Ontzigt'. Ontzigt! Geert zelf fulmineert vanmorgen woedend als hij bij informateur Putters aankomt: 'Het is staatsrechtelijk onjuist en ondemocratisch dat ik geen premier wordt, ondanks dat mijn partij de grootste is'. Dat gaat een stevig kabinet worden. Overigens is er staatsrechtelijk niks onjuist aan. Duidelijk is dat NSC maar ook Yesilgöz zo weinig mogelijk binding willen hebben met de nieuwe regering. Daarom wordt het een extraparlementair kabinet. In naam althans, want het wordt gewoon een rechtspopulistisch kabinet. In elk geval blijft premier Wilders ons bespaard. Helaas geldt dat niet voor Mona Keyzer; die zal wel minister mogen worden. Naar het begin van dit kwartaal
Gorinchem (24.075)

Vrijdag 15-03-2024
Het is vandaag een grijze dag met met soms wat zon en af en toe regen. Soms pittige buien. Anna is flink neusverkouden en de sinussen doen mee. Ze doet een coronatest die negatief uitvalt. Ik ga alleen sporten en doe boodschappen bij de Coöp en de Marokkaanse groenteboer in de Westwagenstraat. Helaas vergeet ik dat de laatste op vrijdagen tussen de middag altijd gesloten is; dan is hij naar de moskee. Morgen moet ik dus nog een keer.
Gisteren was de warmste 14e maart ooit gemeten. Het is het vierde warmterecord van 2024. In De Bilt werd het om 15:10 uur 17,7 graden en daarmee is het oude datum-warmterecord van 17,6 graden uit 1991 gebroken. Uiteindelijk werd het 17,8 graden. Warmterecords komen tegenwoordig dan ook veel vaker voor dan kouderecords. Je ziet dat in de grafiek hierboven. Deze eeuw telt tot dusver negen keer meer warmterecords dan kouderecords.
Informateur Kim Putters kwam gisteren (na het afsluiten van mijn weblog) op zijn persconferentie met een nieuw begrip: een programkabinet. Om het verschil te zien met een gewoon meerderheidskabinet heb je een politieke microscoop nodig. 'Vol chagrijn moeten de rechtse partijen een kabinet proberen te vormen', karakteriseert De Volkskrant de situatie. Er lijkt nauwelijks voldoende vertrouwen te bestaan tussen PVV, VVD, NSC en BBB. In de komende periode moeten ze ondermeer een zo beknopt mogelijk hoofdlijnenakkoord overeen komen, waarin ze in elk geval afspraken maken over een tiental thema’s, variërend van asiel, migratie en zorg tot volkshuisvesting en financiën. Klimaat staat er niet bij. Deze farce wordt met de week groter. Voorbeeld? Gisteren debatteerde de Tweede Kamer over voortzetting van de steun aan Oekraïne, maar de PVV bleef weg.
Er is weer enig contact met de ruimtesonde Voyager1. Drie maanden geleden meldde ik dat NASA het contact met de sonde was kwijtgeraakt. Sindsdien stuurde het toestel, gelanceerd in 1977, geen wetenschappelijke of technische gegevens meer naar de aarde. In plaats daarvan zond het een repeterend, binair nonsenspatroon van enen en nullen uit, net alsof het systeem ergens in bleef hangen. Men zocht de oorzaak in het FDS, het Flight Data System, dat de meetgegevens van het toestel samenstelt voor verzending. Op 3 maart jl. ontdekte ground control dat een deel van FDS opeens deels een ander signaal verzond, hoewel het nog steeds niet het goede format had. Een technicus van NASA kwam erachter hoe hij het aparte signaal kon decoderen. Het bleek een read-out te zijn van het complete FDS-geheugen. Daarin opgenomen waren behalve wetenschappelijke meetresultaten ook essentiële commando's en instructies. NASA gaat nu proberen om met behulp van dit nieuwe signaal de sonde als het ware 'op te porren' en langs de storing in de software te leiden. Voyager 1 is nu 24 miljard kilometer verwijderd van de aarde. Sowieso zou het contact met Voyager 1 voor 2025 voorgoed verloren gaan en zal het vaartuig in stilte nog duizenden jaren zijn eenzame reis door de ijzige interstellaire ruimten voortzetten. Naar het begin van dit kwartaal
Gorinchem (24.077)

Zondag 17-03-2024
Op 9 maart jl. was er een megazware uitbarsting van gloeiendheet plasma op de verre zijde van de zon. De enorme booglus van 500.000 kilometer lengte werd waargenomen door NASA's Solar Dynamics Observatory (SDO). De uitbarsting zond een gigantische wolk heet plasma de ruimte in, een coroneale massa ejectie (CME) die volgde op 10 maart trof de kale rotsplaneet Mercurius en schroeide daar het oppervlak hevig. Daarbij zou een aurora (poollicht) van röntgenstraling, dus niet van zichtbaar licht zoals bij ons, zijn ontstaan die grote delen van de onbeschermde bodem trof. Mercurius staat van alle planeten in het zonnestelsel het dichtst bij de zon en wordt vaak door CME's getroffen. Hij is daardoor een volkomen kale, steriele planeet. Op de zon zelf bleef een bijna 100.000 kilometer lange ravijnkloof van vuur achter. Dergelijke fenomenen aan de verre zijde van de zon kunnen soms gezien worden door de Perseverance rover op de planeet Mars, als die aan de andere zijde van de zon staat. De gigantische uitbarsting is een teken dat de piek nadert van de 25e zonnecyclus. Dat is eerder dan verwacht, de piek werd aanvankelijk pas in 2025 of 2026 verwacht.
Afgelopen donderdag overleed Frans de Waal in zijn woonplaats Atlanta, Georgia (VS), aan de gevolgen van uitgezaaide maagkanker. Hij werd 75. Wat las ik zijn geestige en informatieve boeken graag! 'De man die mens en aap dichter bij elkaar bracht', schrijft de NRC. Hij had altijd kritiek op de opvattingen van auteurs als Richard Dawkins, die hij eenzijdigheid verweet, alsof gedrag louter en alleen door de genen wordt bepaald.
Eergisteren meldde het RIVM dat er inmiddels vier baby's zijn overleden aan kinkhoest. Gebruikelijk is dat ieder jaar wel enkele baby’s aan die ziekte overlijden, maar over de huidige toename maakt het instituut zich ‘grote zorgen’. Onbekend is of het gaat om kinderen die niet waren gevaccineerd. De afname van het aantal inentingen is niet de enige factor. Sinds eind jaren negentig is de kinkhoest bezig aan een opmars, vermoedelijk omdat de bacterie wat is gemuteerd. Toch weten veel mensen niet dat de aanstaande moeder al tijdens haar zwangerschap kan worden gevaccineerd. Dat beschermt de baby na de geboorte tegen kinkhoest. Het gaat overigens niet alleen om kinkhoest. Afgelopen week waren er verschillende meldingen van mazelen in Eindhoven en omgeving. Dat betrof veertien ongevaccineerde kinderen met een gemiddelde leeftijd van 5 jaar en om een ongevaccineerde volwassene. Door de dalende vaccinatiegraad neemt het risico op verspreiding toe. Dat komt niet alleen door rechtzinnige gelovigen in de Bijbelbelt, minima en allochtonen, maar ook door een steeds groter spiritueel ontspoord deel van de intelligentsia.
In Rusland nemen vandaag rond het middaguur ineens tienduizenden deel aan 'Lunch tegen Poetin' protesten. Tientallen worden opgepakt. Het is de derde keer dat in korte tijd veel mensen op de been komen uit protest tegen het regime. Eerst uit steun voor een oppositiekandidaat, Nadezjdin, die later geschrapt werd, en daarna bij de begrafenis van Navalny. Op de eerste dag van de verkiezingen werd in zeker vier stemlokalen brand gesticht of met vuurwerk gegooid, meldden onafhankelijke Russische media. Ook werden afgelopen dagen gevulde stembussen besmeurd met zeljonka, een heldergroene kleurstof waarmee oppositiefiguren in het verleden geregeld werden besmeurd door Kremlin-sympathisanten. Tegelijkertijd wordt tegen de middag de luchthaven van Moskou aangevallen door Oekraïense drones.
Zondagochtend, bewolkt maar nog droog. Buiten loopt een gids van de VVV met een drom toeristen langs. Later op de dag volgen weer rondleidingen. Dan is er meer zon. Het gaat beter met de sinussen van Anna maar niet met haar hoofdpijn. Bij mij viel gisteravond de oude kroon weer uit mijn bovengebit. Old age. Over snotteren gesproken: volgens Nature Today staat de berk sinds vorige week volop in bloei, vooral in het zuiden en oosten van het land. En dat is veel eerder dan normaal, want de laatste keer dat de berk zo vroeg bloeide was in 1990. Komende week zullen er heel veel pollen in de lucht zijn. Naar het begin van dit kwartaal
Gorinchem (24.078)

Maandag 18-03-2024
Wappies spotten graag met de kwaliteit van weerberichten: 'Hoezo een warmer klimaat? Ze kunnen nog niet eens vijf dagen vooruit het weer voorspellen!' Ze snappen er niks van. Je kunt ze niet eens uitleggen dat weer en klimaat volstrekt niks met elkaar te maken hebben en dat het weer nooit voor honderd procent voorspelbaar kán zijn. Om principiële redenen. Omdat het een niet-lineair systeem is, is de chaostheorie erop van toepassing. Dat komt door de enorme gevoeligheid voor beginwaarden, het vlindereffect om zo te zeggen, het opfladderen van een vlinder in het Braziliaanse regenwoud kan een tornado in Texas veroorzaken. Een dergelijke fundamentele onvoorspelbaarheid heb je bijvoorbeeld ook bij het chaotisch gedrag van dubbele pendulums, zie hier. Of op de aandelenbeurzen. Daarom ben ik blij dat de weersvoorspellingen desondanks steeds beter worden - al zullen ze nooit perfect kunnen zijn. Rond de eeuwwisseling waren de 5-daagse voorspellingen tot 'hoog-accuraat' gestegen; die kwalificatie geldt door de steeds grotere rekenkracht van computers nu voor 7-daagse voorspellingen, zoals je hierboven kunt zien. De 3-daagse voorspelling zie je asymptotisch de 100 procent correctheid naderen. Maar hij zal die nooit bereiken.
Vanmorgen zag ik Poetin, die omringd door aanhangers, vol tevredenheid constateerde dat hij met overmacht de presidentsverkiezingen had gewonnen. Voor het eerst noemde hij Navalny. De lange rijen van protest gisteren hadden geen invloed op de uitslag. En de dood van de oppositieleider? 'Die dingen gebeuren. Zo is het leven'. Poetin reageerde ook op Macron, die onlangs niet uitsloot dat de NAVO grondpersoneel in Oekraïne zou kunnen inzetten. (Hij kreeg daarvoor steun van landen als Finland, Tsjechië, Polen en andere bondgenoten langs de oostflank van de NAVO). De dictator blufte opnieuw met zijn kernwapens. Rusland en de NAVO zijn in dat geval 'slechts één stap verwijderd van een Derde Wereldoorlog', zei hij. 'Maar ik denk dat bijna niemand daarop zit te wachten'. Autoritaire leiders dreigen altijd met geweld om hun zin te krijgen. Zo ook Trump. In zijn geval niet met kernwapens maar met volksopstanden. Op een bijeenkomst in Dayton, Ohio, zei hij deze week: 'Now, If I don't get elected, it's gonna be a bloodbath for the whole. That's gonna be the least of it'. It's going to be a bloodbath for the country'. Het is vrijwel een herhaling van zijn toespraak voorafgaand aan de bestorming van het Capitool op 6 januari 2021.
Waterschappen en drinkwaterbedrijven doen een dringend beroep op een nieuw kabinet om de watervervuiling in Nederland aan te pakken, meldt de NOS. De organisaties worstelen met de hoeveelheid schadelijke stoffen in het water en willen dat er desnoods een wettelijk verbod komt op schadelijke stoffen, zo schrijven ze in een gezamenlijk pamflet. Het gaat om onder meer nitraat door mest uit de landbouw, bestrijdingsmiddelen, medicijnresten en PFAS. De voorzitter van Vewin, de vereniging van drinkwaterbedrijven, zegt: 'Ik kan eerlijk gezegd niet aan mijn kinderen uitleggen dat we zo ongelofelijk veel investeren om rottigheid uit het water te halen die we er zelf in stoppen'. Vorig jaar concludeerde milieuorganisatie Natuur & Milieu op basis van een burgeronderzoek al dat de waterkwaliteit van Nederlandse sloten en plassen slecht blijft. En cijfers uit 2022 wezen al uit dat het meeste oppervlaktewater in Nederland niet voldoet aan de normen. Verwacht niet dat een rechtspopulistisch kabinet zich er veel van zal aantrekken..
Maandag. Een tamelijk zachte dag met stapelwolken en 15 graden. Anna knapt wat op, de bijholten zijn weer rustig. Ze doet zelfs al boodschappen, maar nog geen sport. Met een hoogwerker en een hogedrukspuit komt iemand de gevel van ons gebouw schoonspuiten (foto hier). Ook op de sluis wordt voor de start van het vaarseizoen hard gewerkt aan de technische installatie. Naar het begin van dit kwartaal
Gorinchem (24.079)

Dinsdag 19-03-2024
Twee keer voeren we met onze Dulce door de Straat van Gibraltar. De eerste keer in 2008 in oostelijke richting, na een winter in Lagos, Portugal. De tweede keer op de terugweg naar de Atlantische Oceaan, in 2014. Toen had de boot in Ragusa, Sicilië, overwinterd en wij in Gorcum. Het varen door de smalle zeestraat - op het smalste punt slechts 14 kilometer breed - tussen twee continenten door was een bijzondere ervaring, vergelijkbaar met varen door de Bosporus (in 2009) en de Rode Zee (in 2011). De mooie luchtfoto hierboven laat de indrukwekkende Straat mooi zien. Rechts zie je ze allebei, de Zuilen van Hercules. Rechtsboven zie je de punt van de Britse kroonkolonie Gibraltar met de havens duidelijk zichtbaar in fijne lijntjes. Wij lagen zowel op de heen- als de terugweg in de noordelijkste marina bij de korte landingsbaan van het vliegveldje. We genoten van het rare Britse stadje aan de voet van de hoge rots, die vol met aapjes zat. Helaal linksboven in de knik aan de kust zie je aan de Atlantische kust de Spaanse haven Barbate, waar we vandaan kwamen. Toen we in 2008 vanaf Gibraltar verder voeren staken we over naar de andere Zuil van Hercules, het puntige schiereiland met de Spaanse enclave Ceuta. Die haven zie je rechtsonder liggen. Ook een aparte plaats, toen al vol met asielzoekers uit Afrika die over de hoge hekwerken hadden weten te klimmen. Daarna gingen wij om het schiereilandje heen in zuidelijke richting, verder Marokko in.
Wat je ook goed op de luchtfoto ziet is de subductiezône op de zeebodem, exact tussen de beide Zuilen. Daar schuift de ene aardplaat onder de andere. Hij wordt de Boog of de Trog van Gibraltar genoemd en blijft al 5 miljoen jaren vast op zijn plaats liggen. Daarvoor bewoog hij wel en schoof gedurende 30 miljoen jaar traag naar het westen, naar de oceaan. Men denkt dat de trog de komende 20 miljoen jaar inactief en slapend zal blijven, maar een recente modelstudie in het blad Geology voorspelt dat hij daarna opnieuw in beweging zal komen: 'Gibraltar subduction zone is invading the Altlantic'. Lees er hier meer over. Je hebt de neiging - althans ik - om je nietig te voelen bij die platentektoniek op een aarde, die altijd in beweging is en waarop de menselijke beschaving slechts een luttele 3000 jaar bestaat. Een futiliteit, zou je zeggen, ware het niet dat wij er in niet meer dan 200 jaar tijd in slagen diezelfde aarde ingrijpend te veranderen en in no-time te verpesten.
Veel bewolking, wat zon en met 16 tot haast 17 graden zeer zacht. Ik ga sporten terwijl Anna de bovenste buurvrouw op bezoek heeft. Buiten gaat het schoonspuiten van onze gevels door. Aan de andere kant van de sluis wordt ook gespoten; de geometrische beelden van Winiarski krijgen een beurt met de hogedrukspuit. Naar het begin van dit kwartaal
Gorinchem (24.080)

Woensdag 20-03-2024
Vandaag is het kamerdebat over het rapport van informateur Putters en het zogenaamde programkabinet. Een dag tevoren had het VanderPlasmens nog een waardige behandeling van dieren in de veeteelt om zeep geholpen. In de NRC zien Philip de Witt Wijnen en Pim van den Dool vier struikelblokken: het broze vertrouwen van met name Omtzigt in de grilligheid van Wilders, de naïeve wens van wisselende meerderheden in het parlement bij een extraparlementair kabinet met populistisch-rechts, de ambitieuze bemensing inclusief de premiersvraag, en de vele inhoudelijke obstakels (o.a. de lijst van tien punten van Putters).
Om kwart over tien begint het debat. Buiten schijnt de zon maar ik kijk naar de livestream. Al meteen maakt Wilders de namen bekend van twee nieuwe informateurs, die Putters zullen opvolgen: oud-SGP-Kamerlid Elbert Dijkgraaf en oud-topambtenaar Richard van Zwol (CDA). Ze hebben al 'ja' gezegd, maar hun partijen weten nog van niks en zijn not amused. Henri Bontenbal 'baalt ervan'. Ik snap dat wel, het is nogal stiekem. Omdat de PVV en de andere drie geen kwaliteitsmensen kunnen (of willen) leveren, breken ze steeds in bij de oppositie. Later is er een debat over het eventueel royeren van leden van oppositiepartijen die minister worden in een rechts-populistisch kabinet. Van der Plas vindt dat 'schandalig'. Terzijde: Dijkgraaf is overigens een traditioneel-gelovige man die nog altijd het vrouwenverbod bij de SGP onderschrijft.
Ondertussen bakt Anna een gembercake en belt bij ons een techneut van Ziggo aan. Een aardige jongeman, anders dan de hork van een halfjaar geleden, die naarstig zoekt naar de oorzaak van de storing aan onze televisie - valt af en toe uit - maar kan het niet vinden. Ons probleem is te ingewikkeld en/of wij te oud. Het debat gaat voort. Timmermans bezweert tevergeefs VVD, NSC en BBB om niet met Wilders te gaan regeren. 'Doe dit ons land niet aan!' 'De werkelijke macht zal vanuit dat bankje daar komen’, zegt hij wijzend op de kamerbank van de PVV-leider. ‘Het maakt niet uit waar Wilders zit, het wordt het kabinet-Wilders, zelfs als het niet zo heet.’ Yesilgöz zegt 'Dit is misschien wel de laatste kans op centrum-rechts kabinet’ om daarna hautain te vervolgen '‘Als de poging van deze partijen mislukt, rolt de bal gewoon naar de heer Timmermans’. Daarna ligt Omtzigt flink onder vuur van de oppositiepartijen omdat hij alsnog gaat onderhandelen met de PVV, nadat hij eerder had gezegd dat de ‘rechtsstatelijke afstand’ met die partij ‘te groot’ is. Zo gaat het verder maar ik val erbij in slaap, waarschijnlijk mede door de last van mijn verkoudheid.
De volgende fase kan nu beginnen, aanstaande maandag, en mag acht weken duren. De inhoudelijke verschillen zijn dermate groot dat ik niet geloof dat het zal lukken. Of dat een rechts-populitische kabinet een lang leven beschoren is. Na alle concessies, met name het premierschap, en de lange rij zaken in de koelkast zal Wilders nu eindelijk wel eens wat voor zijn kiezers willen bereiken, zoals inperken van migratie en het garanderen van bestaanszekerheid. Bovendien zegt hij alsmaar toch premier te willen worden en dat kan alleen nadat hij het aanstaande kabinet laat vallen, bijvoorbeeld wegens chronisch geruzie en een nog grotere winst bij nieuwe verkiezingen. Naar het begin van dit kwartaal
Gorinchem (24.081)

Donderdag 21-03-2024
Natuurwetenschap beweegt zich tussen de extreme domeinen van groot en klein en alles wat ertussen is. Van de beide extremen kun je veel leren. Zo bijvoorbeeld de allergrootste structuren in het heelal: enorme superclusters van gigagrote en kleinere verzamelingen van spiraalsterrenstelsel en sterrenhopen. De vraag mag gesteld worden waarom het universum zo ontstellend groot zou moeten zijn, als het alleen maar de mensheid hoeft voort te brengen? Dat lijkt zwaar overdreven. Het is een argument om te besluiten dat we niet de bedoeling waren. Of - omgekeerd - dat we verre van alleen zijn.
Een internationaal team van wetenschappers onder leiding van astronomen van de Universiteit van Tartu (Estland) heeft talrijke superclusters in het heelal ontdekt. De meest in het oog springende van deze clusters is vernoemd naar de Estse astronoom Jaan Einasto, een pionier op dit gebied, die op 23 februari zijn 95e verjaardag vierde. Terzijde: de naam 'Einasto' is een anagram van 'Estonia', een naam die zijn patrottische vader koos ter vervanging van zijn Duitse achternaam.
Superclusters zijn de grootste en meest massarijke verzamelingen van sterrenstelsels in het heelal. Bij hun onderzoek hebben de wetenschappers vastgesteld dat de gemiddelde supercluster zes miljoen miljard keer zoveel massa heeft als onze zon en ruwweg 200 miljoen lichtjaar groot is. Daarmee zijn superclusters ongeveer tweeduizend keer zo groot als ons Melkwegstelsel. De zwaarste van de opgespoorde supercluster heet dus nu de Einasto Supercluster. Hij staat sinds kort op de lijst die de Engelse Wikipedia bijhoudt. Einasto bevindt zich op ongeveer drie miljard lichtjaar afstand van de aarde. De kolossale structuur bevat het massa-equivalent van ongeveer 26 biljard (- een miljoen miljard, ofwel 26 met 15 nullen) zonnen, zegt Astronieuws. Zie ook hier en de wetenschappelijke publicatie hier. Een lichtstraal die aan het ene uiteinde van deze kolos vertrekt, doet er 350 miljoen jaar over om het andere uiteinde te bereiken.
Het Estse team heeft in totaal 662 superclusters ontdekt en geanalyseerd. De onderlinge zwaartekracht van Einasto is tot dusver sterk genoeg om hem bijeen te houden, maar door de versnelde uitdijing van de kosmnos zal hij tenslotte uit ons gezicht verdwijnen. Voorgoed onbereikbaar? Kun je aannemen dat de ruimtetijd op dat soort megagrote afstanden dezelfde vier dimensies heeft als bij ons? Die vraag komt bij me op door de lectuur van 'The Three-Body-Problem' trilogie van Liu Cixin. In zijn universum kan ruimtetijd in sommige delen van het heelal vijf (grote) dimensies hebben, maar op andere plaatsen ook twee. Wie zegt dat zoiets niet kan? In de snaartheorie heb je zelfs tien of elf dimensies, onzichtbaar klein gemaakt (gecompactificeerd), waarvan er eentje wel groot zou zijn maar om andere, mij niet bekende redenen niet gezien kan worden. Vanaf vanavond kun je de verfilming van de trilogie op Netflix zien.
Een Russische rechtbank heeft een klacht van de moeder van Aleksej Navalny verworpen. Ze had de strafkolonie aangeklaagd waar Navalny is overleden, omdat ze vindt dat hij niet de juiste zorg heeft gekregen. De rechtbank heeft het verzoek afgekeurd met als argument dat alleen Navalny zelf die aanklacht had kunnen indienen. Zoiets bedenken ze alleen in Rusland.
Gisteren begon na al die mooie dagen de astronomische lente. Vandaag is het overwegend grijs en niet meer zo zacht. Vandaag worden de versleten PVC-regenpijpen van ons gebouw vervangen door mooie pijpen van glimmend RVS. We gaan samen sporten maar met mate. De verkoudheid wreekt zich; ik doe maar één rondje op het Biocircuit. 's Middags krijgen we bezoek van Barbara, Nikita en Zaila. Die zijn alledrie al verkouden geweest (maar dat hoeft niet hetzelfde virus te zijn geweest). Naar het begin van dit kwartaal
Gorinchem (24.082)

Vrijdag 22-03-2024
Op zoek naar de oorsprong van alles vonden onderzoekers met de Europese astrometrische ruimtetelescoop Gaia en de Magellan-telescoop in Chili een bijzonder oude ster in de Grote Magelhaense Wolk, een zelfstandig satellietsterrenstelsel dat circa 2 miljard jaar geleden werd ingevangen door de zwaartekracht van onze Melkweg. In totaal vonden ze er tien van zulke oude sterren, maar deze - LMC119 - was de oudste. Deze oude sterren zijn dus buiten ons sterrenstelsel gevormd. Dat geeft astronomen de kans om te onderzoeken of de omstandigheden in het vroege heelal overal gelijk waren, of lokaal verschilden. De eerste materie die na de oerknal ontstond bestond slechts uit waterstof en helium met een spoortje lithium. Zwaardere elementen werden pas later gevormd bij de nova-explosies van opvolgende generaties sterren. In LMC119 vond men veel minder elementen zwaarder dan helium dan in enig andere ster die tot nu toe in de Grote Magelhaense Wolk. Dit betekent dat hij waarschijnlijk is gevormd in het kielzog van de eerste stellaire generatie, en dus nog niet veel zwaardere elementen kon opnemen. 'De weinige zwaardere elementen die LMC-119 bevat zijn volgens de onderzoekers waarschijnlijk afkomstig van de supernova-explosie van een ster van de eerste generatie', zegt Astronieuws. Maar er was ook iets vreemds met LMC119. 'Toen ze de elementen in de ster in kaart brachten, zagen de astronomen tot hun verbazing dat er veel minder koolstof dan ijzer in zat dan in sterren van ons Melkwegstelsel'. (Sterren van dezelfde ouderdom, neem ik aan - TZ). Dit suggereert dat koolstofverrijking die oude Melkweg-sterren tentoonspreiden wellicht niet universeel was.'
Biden maakt zich zorgen over zijn herverkiezing. Daarom wil hij dat Oekraïne stopt met de succesvolle drone-aanvallen op Russische olievoorraden en raffinaderijen. Ik snap ik wel dat de VS bang zijn voor escalatie en de oorlog het liefst voort willen laten sudderen op een laag niveau. Dat kan jarenlang duren. Maar de president is nu ook bang dat Rusland vergeldingsmaatregelen zal nemen, zoals het afsluiten van pijpleidingen die ook voor het Westen van belang zijn, want dan zouden de benzineprijzen aan de pomp in de VS kunnen stijgen. Dat is wel erg cynisch, moet ik zeggen. Het is alsof de president roept: Hé Zelensky, tot november even geen effectieve tegenaanvallen op Rusland! Dat gebeurt terwijl het Kremlin juist weer erg intensief poogt om de Oekraïnse energievoorziening lam te leggen. Afgelopen nacht hebben de Russen 90 raketten en 30 drones afgevuurd op energiecentrales en een dam bij een grote waterkrachtcentrale in Oekraïne. Het was de grootste aanval in maanden op de energiesector daar. Ruim een miljoen Oekraïeners zit nu zonder stroom. Ik begrijp best dat ze de Russen graag een koekje van eigen deeg serveren en zich niets van Biden willen aantrekken. Per slot hebben ze al vijf maanden geen Amerikaanse steun meer ontvangen, geloof ik. Enfin, de onrust in de wereld stuwt de brandstofprijzen inmiddels ook bij ons weer flink op. Overal in Europa stijgen de prijzen aan de pomp. Weinig ergert de verwende consumenten in het westen meer dan hoge benzineprijzen. Opmerkelijk is dat ze daardoor steeds meer op extreemrechts gaan stemmen, alsof het allemaal de schuld van links is.
Vanochtend is het grijs maar nog droog. De werklui maken de klus af van de nieuwe regenpijpen. Er passeren verschillende rondleidingen over de sluis. Na twaalf uur begint het te regenen als een koufront overtrekt. De koude lucht erachter gaat ons een guur weekeinde brengen. Anna krijgt vanmiddag een vriendin op bezoek. Vandaag is het bijna tien dagen na de expertise; nog geen bericht van de bootverzekering. Naar het begin van dit kwartaal
Gorinchem (24.083)

Zaterdag 23-03-2024
Een ouderwetse avond. Een avond zoals we die vroeger vaak hadden. Anna had lekker gekookt en mijn taak was de muziek te verzorgen. Uit de CD-kast haalde ik op zeker moment de opname, een dubbel-CD, van het concert voor Bangladesh in de zomer van 1971, georganiseerd in Madison Square Garden in New York door George Harrison en Ravi Shankar. Voor een keer mocht het volume op hard. Meedeinen op de aanstekelijke rock met gillende meiden en Leon Russel over een huiselijk onderwerp. 'Now everyonne has a young lady at home'. Dus ik sprong de vloer op en ging dansen terwijl Anna, niet zo'n danstype, het meewarig gadesloeg. En toen kwam hij verderop in het programma er opeens in, Bob Dylan met tenslotte de regels die klonken alsof ze niet van gisteren waren:
I’m a-goin’ back out ’fore the rain starts a-fallin’
I’ll walk to the depths of the deepest black forest
Where the people are many and their hands are all empty
Where the pellets of poison are flooding their waters
Where the home in the valley meets the damp dirty prison
Where the executioner’s face is always well hidden
Where hunger is ugly, where souls are forgotten
Where black is the color, where none is the number
And I’ll tell it and think it and speak it and breathe it
And reflect it from the mountain so all souls can see it
Then I’ll stand on the ocean until I start sinkin’
But I’ll know my song well before I start singin’.
Het sloeg er flink in. Toen voerden we nog oppositie, beter langharig dan kortzichtig, kwamen we in verzet tegen de wrede idiotie van een onverschillige wereld en dachten we dat we die veranderen konden. 'We can change the world!' Een paar jaar later vertrok ik als revolutionair dokter naar de bevrijdingssstrijd in Angola. (Die geen revolutie bleek maar een ordinaire burgeroorlog om macht en privileges). Toch stemt het je treurig als je de slappe, verwende jeugd van vandaag de dag ziet, de verwende consumenten, de kortzichtige populisten, de politici zonder karakter en kennis. Nu stelt Europa uit angst voor radicaal-rechts een hoogstnoodzakelijke natuurherstelwet uit. Ons nationale parlement boort de al overeengekomen wet voor dierenwelzijn op het laatste moment de grond in. De formerende partijen PVV, NSC en BBB keren zich tegen het nieuwe Europese klimaatdoel voor 2040. Enzovoorts. Moeten we niet véél meer doen, bozer worden - en we zijn al zo vaak boos - en meer verzet bieden? Enfin, toen ik uitgedanst was zetten we de televisie aan, de avond was al een eind gevorderd, kwam pas het nieuws over de aanslag in Moskou langs. Een terreuraanslag die niet van Oekraïne zou zijn maar van een Afghaanse tak van ISIS.
Het is een kille zaterdag, maximaal 8 graden met een gure oostenwind. Er vallen maartse buien in het land maar tot drie uur vanmiddag niet bij ons. Daarna regent het. In Moskou staat het dodental van de aanslag nu op 133 met honderden gewonden, maar in de verbrande ruimtes van het Crocus City Mall concertgebouw denkt men nog meer slachtoffers te vinden. De Russen zeggen elf terroristen te hebben opgepakt maar ze hebben nog niemand officieel verantwoordelijk gesteld. Poetin spreekt op de televisie van 'een barbaarse terroristische daad' en legt opnieuw verband met Oekraïne. Vier terroristen werden in een vluchtauto aangehouden in de regio Brjansk, 370 kilometer ten zuidwesten van Moskou, na een achtervolging. Oekraïne ontkent er iets mee te maken te hebben. Poetin zegt niets over de Afghaanse tak van ISIS, die de aanslag claimt. Amaq, het persbureau van IS, publiceert vandaag foto's van de vier aanslagplegers. De Amerikaanse ambassade in Rusland had eerder deze maand voor terreurdaden in Moskou gewaarschuwd. Een bron bij de Russische inlichtingendienst bevestigt aan RIA Novosti dat er inderdaad zulke informatie is ontvangen uit de VS, maar ze vonden het een provocatie. Naar het begin van dit kwartaal
Gorinchem (24.084)

Zondag 24-03-2024
De kille zondagochtend start met zon, maar het is guur en winderig en na half elf regent het. Opnieuw Maartse buien. Dit is een geschikt moment voor een minder vrolijk onderwerp. De Zweeds/Amerikaanse natuurkundige Max Tegmark maakte een videofilm over wat er zou gebeuren als er een kernoorlog zou uitbreken tussen de VS en Rusland. Het is goed om die waanzin weer eens onder ogen te zien. De systemen van kernmogendheden zitten zo in elkaar dat ze bij een aanval door de aangevallen partij al worden afgevuurd als de raketten van de aanvaller nog onderweg zijn. Dus hun doelen nog niet bereikt hebben. Mocht een kernaanval door Moskou worden begonnen dan gaat het om een conflct met de NAVO, waarbij niet alleen de VS maar ook doelen in Europa zullen worden getroffen. Allereerst zelfs, vanwege hun nabijheid, dus de kernmachten van het VK en Frankrijk, maar ook ons land. Bij ons staan de kernwapens op de vliegbasis Woensdrecht.
Kijk rustig naar het filmpje, het duurt niet lang, en alles komt aan bod: de enorme schokgolf, de verdamping (vaporisatie) van mensen en gebouwen in het inslaggebied, de allesvernietigende vuurstormen, de nucleaire fallout over grote gebieden, de dood van 95 procent van de bevolking, de verduistering van de hemel door roet- en stofwolken, de daling van de temperaturen met zo'n 35 graden, de lange nucleaire winter en de hongersnoden, vooral op de noordelijke helft van de aarde. Merk op dat de huidige grootmachten, de VS, Rusland en China, alledrie op die hemisfeer liggen.
MAD. Mutual Assured Destruction. Realiseer je ook dat het Poetin is die er herhaaldelijk mee dreigt. Hij weet dat we in het westen allemaal van terechte angst in elkaar duiken. Poetin is een gewiekste pokeraar, de westerse landen zijn dat niet,ze schrikken terug en zo zet hij zijn zin door. Tegelijk weet hij ook dat hij ook het bestaan zijn eigen land en volk in de waagschaal stelt, want afschrikking werkt alleen als die geloofwaardig is. We herinneren ons allemaal Barry McGuire en zijn hit 'The Eve of Destruction':
If the button is pushed, there's no runnin' away
There'll be no one to save with the world in a grave
De popgorep The Spokesmen reageerde erop met het lied 'The Dawn of Correction' in 1965 en vatte daarin de situatie zo samen:
There are buttons to push in two mighty nations
But who's crazy enough to risk annihilation?
The buttons are there to ensure negotiation
So don't be afraid, boy, it's our only salvation
Het werd geen grote hit.
In Rusland houden ze een dag van nationale rouw vanwege de aanslag van vrijdagavond in de Crocus City Hall bij Moskou. Bij de Russische ambassades over de hele wereld hangt de vlag halfstok. Zo ook bij de ambassade in Den Haag. In de Crocus concertzaal en omgeving wordt gewerkt aan het ruimen van het puin na de aanslag en de brand die daarop volgde. Het deels verwoeste gebouw wordt gesloopt. Het is onduidelijk of er nog gezocht wordt naar vermisten. Het dodental staat nog op 133, het aantal gewonden op 153. De terreurgroep IS-K publiceerde een video van de aanslag, gefilmd door de daders zelf. Op de film van één minuut en 31 seconden zie je dat ze het vuur openen op mensen. Op de grond liggen slachtoffers. Op de beelden is ook te zien hoe een van de aanvallers de keel doorsnijdt van een man die gewond op zijn rug ligt. CNN en BBC hebben de beelden geverifieerd, maar Poetin blijft zonder enig bewijs volhouden dat Oekraïne erachter zat. Naar het begin van dit kwartaal
Gorinchem (24.085)

Maandag 25-03-2024
De wetenschappelijke discussie in kringen van klimaatwetenschappers over wat de oorzaak is van de ongewoon hoge temperaturen in 2023 is nog lang niet uitgewoed. De gemiddelde wereldtemperaturen kwamen in de laatste negen maanden van vorig jaar 0,2 graden Celsius hoger uit dan de modellen voorspelden. De normale opwarmingstrend zou slecht een stijging van 0,02 graden geven. De klimatoloog Gavin Schmidt, hoofd van NASA’s Goddard Institute for Space Studies in New York, vindt dat het op planetaire schaal een grote afwijking (anomalie) is. De modellen baseren hun voorspellingen op het verleden, maar in de aaneengesloten reeks van negen maanden in 2023 komt de anomalie er fors bovenuit. Hierboven zie je dat het zich voortzet in de eerste drie maanden van 2024. Sinds een jaar warmt de wereld sneller op dan klimaatwetenschappers verwachten. De discussie gaat allereerst over de oorzaken. 'Many reasons for this discrepancy have been proposed but, as yet, no combination of them has been able to reconcile our theories with what has happened'.
Natuurlijk dachten velen aan de opwarmende invloed van de huidige El Niño. Dat lijkt Schmidt niet zo waarschijnlijk. 'This weather pattern set in only in the second half of the year, and the current spell is milder than similar events in 1997–98 and 2015–16.' De ongebruikelijke extra warmte manifesteerde zich al maanden vóór het begin van de El Niño het eerst in oppervlaktetemperaturen van het water van de noordelijke Atlantische Oceaan. In de zomer was de hoeveelheid zeeijs bij de noordpool kleiner dan ooit. Er miste een ijsoppervlak ter grootte van Alaska.
Andere opties betroffen de extra hitte van de eruptie van de Hunga Tonga–Hunga Ha‘apai vulkaan op Tonga in januari 2022, en van de hogere instraling van zonnewarmte door de juist begonnen 25e cyclus van verhoogde zonneactiviteit. 'But these factors explain, at most, a few hundredths of a degree in warming', zegt Schmidt onder verwijzing naar Schoeberl, M. R. et al. Geophys. Res. Lett. 50, e2023GL104634; 2023.
Een andere factor was hier op dit blog al eerder als verklaring aan de orde: de sterk afgenomen uitstoot van vervuilende zwavelverbindingen door de zeescheepvaart sinds nieuwe, internationale wetgeving voor schonere brandstof van kracht werd in 2020. Studies wezen tevoren uit dat het effect ervan gering zou zijn, maar mogelijk ligt dat anders. Daarvoor bestaan aanwijzingen in de metingen van schonere lucht op juist drukke scheepvaartroutes als gevolg van minder koelende zwaveldioxiden. Of dit echt de oorzaak van de sterke anomalie kan zijn, kan blijken uit de resultaten van NASA’s PACE mission, die vorige maanden gelanceerd werd.
De nog onverklaarde temperatuurs-anomalie kan tenslotte ook een aanwijzing zijn voor sterke veranderingen in de ingewikkelde klimaatprocessen op een planeet die inmiddels 1,5 graden opgewarmd is in nauwelijks 200 jaar. In dat geval komen we in onbekend en onverkend gebied terecht. 'It could imply that a warming planet is already fundamentally altering how the climate system operates, much sooner than scientists had anticipated.'
Een stralende zonsopgang en een zonnige, frisse dag. 's Middags krijgt Anna haar jeugdvriendin op bezoek. Bij ons gaat de informatie voor een nieuw kabinet verder. Gisteren kreeg Yesilgöz het met Wilders aan de stok over financiën. Vandaag hebben ze volgens haar 'een mooie sessie'. In België kunnen ze er ook wat van. De Vlaamse politicus Filip Dewinter blijkt jarenlang in opdracht van de Chinese Communistische Partij te hebben gewerkt. Dat melden het Vlaamse weekblad Humo en het Vlaamse onderzoeksplatform Apache op basis van documenten die zij in handen hebben. Dewinter is een kopstuk van de rechts-nationalistische partij Vlaams Belang. Politiek op rechts gaat steeds meer op Jiskefet lijken. Naar het begin van dit lwartaal
Gorinchem (24.086)

Dinsdag 26-03-2024
Vandaag zijn we 20 jaar getrouwd. Twintig jaar gelukkig met elkaar zijn is niet gering. Natuurlijk wilden we het vanavond vieren met een etentje. We hadden gereserveerd bij het restaurant 'The Local Club', dat onlangs in de plaats is gekomen van Grieks restaurant 'Mykonos' op de Langendijk. Maar helaas, Anna leed vannacht aan slapeloosheid en intestinale bekommernissen die vandaag niet verdwijnen. We moeten afzeggen; mogelijk later in de week een herkansing. Op twintig jaar maken die paar dagen niks uit. Mijn eigen verkoudheid is op zijn retour, ik ga alleen naar de sportschool. Het is een droge dag met gaandeweg meer wolken. Nog altijd geen bericht van de verzekering. De expertise is al twee weken geleden. Vanavond zal er regen komen.
Daar heb je het gedonder al: de uitbraak van mazelen in Eindhoven is groter geworden. Het zat erin, het virus is zó ontzettend besmettelijk. Waar er vorige week nog elf meldingen werden bevestigd zijn het er nu 28. Het gaat om 26 ongevaccineerde kinderen en twee volwassenen. (Tussen haakjes: Anna heeft het niet). Alle meldingen zijn te herleiden naar de eerdere lokale uitbraak in de regio Eindhoven, maar de uitbraak kan zich snel verspreiden zodat men de greep erop geheel verliest. Oorzaak: deels onwetendheid, deels verwarring, twijfel aan de wetenschap en misleiding door het wappiedom.
In De Volkskrant vreest Arnout Brouwers na de zware terreuraanslag van IS-K in het Crocus concertcentrum voor een escalatie van de oorlog in Oekraïne. De roep om wraak en de schuldvraag worden gekanaliseerd richting Oekraïne. Gisteren erkende Poetin weliswaar dat de daders Islamitische terroristen waren, maar ze werden volgens hem toch door Kyiv aangestuurd. En hoewel westerse landen Rusland vooraf waarschuwden voor zo’n terreurdaad, is Oekraïne in elke Russische complottheorie natuurlijk de uiteindelijke schuldige. Vandaag voegde de chef van de Russische staatsveiligheidsdienst FSB zich in dat onwaarschijnlijke narratief. Hij zegt tegen persbureau Tass dat Oekraïne, de VS en het VK achter de aanslag in Moskou zitten. Hij heeft natuurlijk boter op zijn hoofd. Dat het verhaal van hem en zijn baas niet klopt, komt ook aan het licht in een reactie van dictator Loekasjenko, die Poetin niet goed zal uitkomen. De daders van de aanslag in Moskou probeerden op hun vlucht de grens naar Belarus over te steken, zegt hij. Die poging mislukte door de strenge grenscontroles, waarna zij richting de grens met Oekraïne vertrokken. Wat een afgang voor het regime in Moskou! Autoriteiten die elkaar tegenspreken: het toont aan hoe volkomen onverwacht de aanslag was en hoe onvoorbereid de diensten waren. Er zullen koppen rollen.
Brouwers is niet de enige die escalatie van de oorlog vreest. Het Institute for the Study of War meent dat ‘verschillende Russische financiële, economische en militaire indicatoren erop wijzen dat Rusland zich voorbereidt op een grootschalig conflict met de Navo, (...) binnen een kortere termijn dan gedacht’. Nu Poetin met zijn herverkiezing met ruim 87 procent stevig in het zadel zit sprak zijn woordvoerder Peskov - ik moet steeds de neiging bedwingen er 'Pestkop' van te maken - voor het eerst niet meer van 'de speciale militaire operatie' maar van 'oorlog'. Direct na de herverkiezing gaf Poetin de opdracht aan zijn generaals om dit jaar nieuwe legers te formeren met een omvang groter dan de verzamelde legers van West-Europa. Maar 'de geur van appeasement hangt boven het continent.' Kyiv krijgt te weinig wapens van het bange, laffe en verwende Westen. Mogelijk valt het land nog dit jaar. Maar 'We blijven de Oekraïners hartjes sturen tot op het schavot'. Naar het begin van dit kwartaal
Gorinchem (24.087)

Woensdag 27-03-2024
Het viel ons vorige zomer op Vlieland en Terschelling al op: weinig vlinders. Het jaar 2023 blijkt het slechtste vlinderjaar te zijn geweest sinds de jaren 80. En het gaat sneller. Het totale aantal vlinders in de lente en zomer is sinds 1992 meer dan gehalveerd, bericht het CBS. Vorig jaar was de teruggang zelfs dramatisch. Meerdere zeldzame vlindersoorten in Nederland dreigen uit te sterven, en ook algemene soorten zoals de kleine vos, het klein geaderd witje en het groot koolwitje lopen sterk terug, blijkt uit de nieuwste metingen. Oorzaken: veranderingen in het landschap, zoals ruilverkaveling, verdroging en overbemesting, waardoor wilde bloemen grotendeels zijn verdwenen uit weilanden.
Bij alle ellende die domrechts in de samenleving aanricht klamp je je vast aan positieve berichten. Nederlands grootste pensioenfondsen willen miljarden investeren in de energietransitie, schrijven ze aan de informateurs. Wat die daarmee moeten weet ik niet, de fondsen moeten het gewoon zelf doen, maar ze hebben nog geen concrete plannen. Ze willen vooral meer geld steken in de uitbreiding van warmte- en elektriciteitsnetten. Ze vinden wel dat de staat hun risico's moet dekken, want pensioengeld moet je niet vergokken. Ah, nu snap ik het, die verzekering moet een komend kabinet op zich nemen. In de Tweede Kamer schijnt er een meerderheid te zijn voor een voorstel van de ChristenUnie om de prijs voor warmtenetten versneld los te koppelen van de gasprijs. Anders dan warmtepompen belasten warmtenetten niet het electriciteitsnet.
Het schijnt dat het vogelgriepvirus minder gevaarlijk is voor pinguins dan gevreesd, toen het virus een aantal maanden geleden op Antarctica werd gevonden. Mogelijk hebben pinguïns geluk en horen ze bij de vogelsoorten die van nature wat minder ziek worden van H5N1. Met gps-trackers volgden de experts zeven adéliepinguïns die besmet waren geraakt met H5N1. Ze ontdekten dat de dieren maanden na de besmetting nog leefden en zoals het hoort te jagen op vis. Wel lijkt het virus in de VS nu ook koeien en geiten te besmetten. Amerikaanse experts vermoeden dat het virus bij de grazers terecht kan zijn gekomen via besmet drinkwater of zwerfkatten. Let op hoe snel het gaat: tot 4 jaar geleden was H5N1 een virus dat vooral circuleerde in pluimvee in Azië.
De GGD in Zuid-Limburg ontdekte mazelen bij een nooit als kind gevaccineerde volwassen man. Hij zou het virus hebben opgedaan bij een reis naar Oost-Europa. Deze besmetting staat los van de uitbraak van mazelen in Eindhoven. De GGD heeft de contacten van de besmette man nagetrokken en ze vaccinatie aangeboden.
Gisteren kregen we van veel kanten felicitaties voor ons 20-jarig huwelijk. Daar zijn we blij mee. Allen hartelijk dank! Het is vandaag een bewolkte dag. Met Anna gaat het wat beter. De intestinale klachten zijn weg maar ze voelt zich erg slap en er kwam migraine bij. Ze slaapt veel. Aan de overkant op de Kriekenmarkt en de Krommenhoek werkt men al enige dagen aan de aanleg van glasvezel. Dat zouden ze bij ons op het Eind al in januari doen, maar het kwam er kennelijk niet van. Naar het begin van dit kwartaal
Gorinchem (24.088)

Donderdag 28-03-2024
Viermaal staken we sinds 2006 de Golf van Biskaje over en iedere keer genoten we van de grote scholen van dolfijnen. Honderden. Vaak speelden ze een tijd om de boeg en draaiden dan op hun zij om je aan te kijken. Geweldige ervaring, we hadden er altijd plezier in. Maar door de intensieve visserij gaat het al jaren slecht met ze. Ze komen terecht in vissersnetten en raken daarin verstrikt, kunnen dan niet meer naar de oppervlakte om te ademen, waardoor ze stikken. Vissers gooien de dieren gewond of dood weer terug in zee. In grote aantallen spoelden ze dood aan de kusten aan. Nu heeft de Franse regering eindelijk een visverbod ingesteld van eind januari tot eind februari. Het hielp meteen, bericht het instituut Pelagis van de universiteit van Rochelle, Het aantal aangespoelde dolfijnen daalde onmiddellijk. Maar het verbod moest door milieuorganisaties wel bij de rechter worden afgedwongen. Er waren echter zoveel uitzonderingen dat het niet werkte. Na een nieuwe gang naar de rechter kwam er een verbod voor de hele Golf, maar slechts voor één maand. Het is dezelfde electorale angst als de autoriteiten voor de boeren en domrechts hebben. De dolfijnen overwinteren doorgaans van december tot en met april in de Golf van Biskaje.
De politie heeft criminelen aangehouden die op grote schaal phishingmails verstuurden en bankhelpdeskfraude bedreven. Op de laptop van een van de verdachten vond men meerdere lijsten met daarop 7,3 miljoen unieke mailadressen, waarvan 5 miljoen uit Nederland. Wees gewaarschuwd, die lijsten circuleren nog steeds. Ik krijg vrijwel dagelijks phishingberichten. Vaak hebben ze het over spoed en 'een laatste waarschuwing' om je onder druk te zetten. Doorgaans zitten ze al in mijn spambox. De politie heeft een site waar je kunt controleren of jouw e-mailadres ook op de aangetroffen lijst staat. Als dat zo is, krijg je een politiemail met tips over wat je het beste tegen phishing kunt doen. Ik doe die check een paar keer per jaar. Vandaag blijkt dat mijn emailadres inderdaad voorkomt in de gestolen (inlog)gegevens uit het grootschalig bankhelpdeskfraude- en phishingonderzoek. Dus aan het werk, cookies wissen, nieuwe wachtwoorden en zo.
Vanmorgen regen, vanmiddag droog en winderig. De eerste passantenboten voor het Paasweekeinde. Anna knapt verder op. Straks op de borrrel bij een vriendin hier vlakbij. Naar het begin van dit kwartaal
Gorinchem (24.089)

Vrijdag 29-03-2024
Heel veel factoren hebben invloed op de snelheid waarmee de aarde om zijn as draait. Bijvoorbeeld de kracht waarmee overheersende passaatwinden waaien, de grote waterverplaatsingen door de oceaanstromen maar ook bewegingen van de aardkern zelf. Maar dat klimaatverandering er ook invloed op heeft, wist ik niet. In het algemeen schijnt onze planeet sinds 2020 steeds sneller om zijn as te draaien, maar de opwarming van het klimaat remt hem af, zegt George van Hal uiteen in De Volkskrant van eergisteren. De reden daarvoor is niet zo moeilijk voor hen die wel eens bij kunstschaatsen een pirouette zagen. Als de kunstschaatser de armen tegen het lichaam houdt, wordt de spin sneller en sneller. Houdt hij/zij de armen van zich af, dan wordt de spin langzamer. Dat laatste is er bij de aarde het geval. Het versnelde afsmelten van de grote ijskappen van Groenland en Antarctica brengt veel meer water in de zeeën en de resulterende zeespiegelstijging verplaatst zich door de rotatie van de aarde naar de evenaar. De extra hoge 'waterbult' daar maakt de omwenteling trager. Het is allemaal een gevolg van de wet van behoud van impulsmoment. De afremming door klimaatopwarming compenseert nog niet de versnelling. Die overheerst vooralsnog en vergt nog altijd dat er af en toe een extra schrikkelseconde bij een lopend jaar gevoegd moet worden. De laatste keer gebeurde dat eind december 2016. 'De afremming door het smeltwater zorgt er overigens wél voor dat dat moment nu wat later plaatsvindt dan anders. Zonder klimaatverandering had de wereld in 2025 of 2026 al een negatieve schrikkelseconde nodig. (De Amerikaanse geofysicus - TZ) Agnew schat de komst van de negatieve schrikkelseconde nu echter in op 2029', schrijft George van Hal.
Uit een onderzoek blijkt dat de Zeeuwse stranden de vuilste van Nederland zijn. Op 91 plekken in het land gingen mensen het strand op met prikkers en afvalzakken om troep te verzamelen. Ze vonden 14.000 stuks afval. Men vond er vooral plastic, stukken hout en vispluis (materiaal om visnetten te beschermen). Ook zijn op het overgrote deel van de Zeeuwse stranden enorme hoeveelheden 'nurdles' gevonden. Nurdles, ofwel ‘pellets’, zijn piepkleine korreltjes kunststofgranulaat, minder dan 5 millimeter groot, die in de industrie worden gebruikt om allerhande plastic producten van te maken. Deze plastickorrels vormen sinds 2015 een van de belangrijkste dossiers van Plastic Soup Foundation. Alleen al in de EU belanden elke dag tot wel 2 miljard nurdles in het milieu. Dat is dus op jaarbasis het nauwelijks te bevatten aantal van 8 biljoen nurdles, zo’n 160 miljoen kilo.
Na wat miezer in de vroege ochtend is het een frisse, droge dag met minder wind dan gisteren. Anna brengt me naar de sportschool en gaat daarna bij de Plus boodschappen doen. Meegaan sporten zit er nog niet in. In het Paasweekeinde zijn er tal van evenementen in de stad. In de loop van de dag arriveren een tiental passantenboten om de Paasdagen in Gorcum door te brengen. De verbouwing van het voorzieninggebouw is juist op tijd klaar. Naar het begin van dit kwartaal
Gorinchem (24.090)

Zaterdag 30-03-2024
De maand maart was dit jaar recordwarm, maar het weer was bepaald somber, zegt het KNMI. Met een gemiddelde temperatuur van 9 graden, tegen normaal 6,5 graden, was het de zachtste maart sinds 1901, het begin van de metingen. In De Bilt hadden ze deze maand geen enkele vorstdag, wat sinds 1912 niet meer voorgekomen was. Van november 2023 tot en met maart 2024 bedroeg het Hellmanngetal in De Bilt 15,8. Met de uitkomst van dat getal wordt de hele winterperiode als zeer zacht aangemerkt.
Is het je opgevallen dat hittegolven in West-Europa de afgelopen jaren trager verlopen dan vroeger? Dus langer duren en heftiger zijn dan de weermodellen voorspellen? Mij in elk geval niet, maar het schijnt wel zo te zijn. En intensiever. Zo werd het in 2019 in Nederland bij een hittegolf 40,7 graden, een piek die zelfs met de opwarming van de aarde meegerekend nagenoeg onmogelijk werd geacht. In ons land is er tegenwoordig zo om het jaar een hittegolf, schrijft Maarten Keulemans in De Volkskrant. 'Vorig jaar was de zomer na een warme, droge start vooral koel en nat, maar in 2022 was er in augustus een hittegolf, net als de bijna twee weken durende hittegolf in augustus 2020. In ons land telt een warme periode als een hittegolf als het minimaal vijf dagen achtereen 25 graden of warmer is, waarvan drie dagen 30 graden of meer.' De hittegolf van 2022 kostte in totaal zo’n 62 duizend Europeanen het leven, vooral ouderen en kwetsbare mensen in Zuid-Europa.
Vergeleken met eind jaren zeventig zijn er tegenwoordig zo’n 30 procent meer hittegolven, die gemiddeld bovendien anderhalve dag langer duren en ongeveer 500 kilometer extra afleggen, blijkt uit recent onderzoek van Chinese wetenschappers, gepubliceerd in ScienceAdvances. Langzamer bewegen doen ze vooral sinds ongeveer de eeuwwisseling, en met name in Afrika, Europa en Azië. De Chinese onderzoekers hebben zo'n 2500 hittegolven over alle continenten geanalyseerd. Daaruit blijkt verrassend genoeg dat hittegolven op een doorsnee dag zo’n dertig kilometer minder afleggen dan ze begin jaren tachtig deden. 'Daardoor kunnen ze een gebied langer in hun verzengende greep houden', zegt Keulemans. Een aantal factoren speelt een rol, zoals de vertraging van de straalstroom en de verzwakking van de AMOC, de Atlantische multidecadale oscillatie, waar de warme golfstroom deel van uitmaakt. Over beide fenomenen heb ik hier regelmatig geschreven. De toename van broeikasgassen in de atmosfeer speelt er een rol in.
De dag begint grijs bewolkt en al gauw komt er regen bij. Het is klam, kil en onaangenaam. Via de sluis arriveren er nog wat passantenboten zodat de Lingehaven aardig gevuld is. Als het even tussen twee buien droog is loop ik snel naar de poelier op de Langendijk voor twee grillkippetjes. Niet voor vanavond, want dan gaan we samen uit eten, het uitgestelde dineetje om ons 20-jarig huwelijk te vieren, vlakbij in de wijnboetiek op het hoekje aan het begin van onze straat. Vannacht gaan we over op de zomertijd. Naar het begin van dit kwartaal
Gorinchem (24.091)

Zaterdag 31-03-2024, 1e Paasdag
Gisteren vergat ik in de namiddag helemaal naar het orgelconcert te gaan van stadsorganist Arjen Versluis in de Grote Kerk. Ik was geheel verzonken geraakt in het uitlezen van het nieuwe boek 'The Allure of the Multiverse' (Basic Books, 2024) van de fysicus Paul Halpern, een goede samenvatting van de al decennia durende impasse in de fysica en de kosmologie tussen quantumtheorie en relativiteit en eveneens tussen de Kopenhaagse Interpretatie van Niels Bohr en de Veelwereldeninterpretatie van Hugh Everett. Het ziet er niet naar uit dat die fundamentele impasse snel doorbroken zal worden. Enfin, even na zes uur - het was even droog - liepen we naar de Wijnboutique aan het begin van het Eind (!) om alsnog ons 20-jarig huwelijk te vieren. Het was er gezellig vol en we genoten van de vele lekkere hapjes en niet in de laatste plaats van een Château Musar 2016, waar men nog wat halve flesjes van had liggen. In 2010 bezochten we dat wijngoed toen we met de boot vlakbij Beiroet lagen. Het is een favoriet van ons gebleven. Voor Anna had ik weken geleden bij de Wereldwinkel een mooi halssnoer gevonden, dat erg in de smaak viel. We hadden een fijne avond.
Vannacht droomde ik dat ik als dokter was teruggekeerd naar Angola. Ik hield weer spreekuur 's ochtends en was daarna in het ziekenhuis. Niet als revolutionair dokter zoals in 1975/1976 maar gewoon als tropenarts ergens op het Angolese platteland. Een rustige manier om je laatste jaren te besteden, vond ik. Luïs, de MPLA-dokter van toen, was er ook weer, hij was weer provinciaal opzichter voor de medische zorg. Ik werkte destijds graag met hem samen. Jaren terug vernam ik dat hij overigens allang niet meer in Angola werkte. Van de revolutie kwam niks terecht, na de eeuwen van koloniale uitbuiting door Portugal kwam er een inheemse corrupte klasse in Luanda aan de macht. Luïs zou nu een gezondheidsautoriteit zijn op het Franse eiland La Réunion in de Indische Oceaan. Het was in elk geval geen verkeerde droom maar niet een om werkelijkheid van te maken. Daarvoor is het ten ene male te laat. Ik zou trouwens mijn boeken weer moeten opslaan, ditmaal in de zekerheid ze nooit meer te zullen zien. Voor Anna zou het helemaal niets zijn, ze zou gek worden van heimwee. Bovendien worden grote delen van dat continent weldra onleefbaar. De klamme hitte is sowieso slopend. Ik herinner me de vroedvrouw die met haar man in ons Nederlands team werkte. Ze verliet hem voor een Angolees, kreeg een kind met hem en stierf niet veel later.
Vanochtend zetten we de klokken een uur vooruit. Het is droog met wat stukjes blauw aan de hemel en het wordt steeds zonniger, Na het middaguur lopen we naar de Paasbrunch die Barbara & Michel voor de familie hebben belegd. Zeer gezellig! Barbara brengt ons na drie uur met haar autootje weer terug thuis. Ondertussen raakt de hemel bewolkt; er worden buien verwacht. Naar het begin van dit kwartaal
Lees vanaf hier verder op https://www.sailing-dulce.nl/home/80




website maken